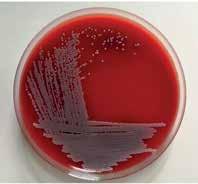

A polêmica do suposto material
supercondutor à temperatura ambiente

A polêmica do suposto material
supercondutor à temperatura ambiente
Queda no número de formados em licenciaturas e desinteresse pelo magistério ameaçam a educação básica brasileira

Acidentes de trânsito são a principal causa de mortalidade de jovens na América Latina
Invisíveis a olho nu, microplásticos estão em todo o litoral brasileiro
Vírus da febre amarela circula de modo ininterrupto há sete anos no Centro-Sul do país
Casal de meteorologistas conta como estudos na Amazônia fortaleceram pesquisa climática
Orquídea atrai mosca polinizadora com berçário falso e armadilha
Rua
10 de outubro de 2023 | das 10h às 11h30
Bernard Anthony WoodDiretor do Centro de Estudos Avançados de Paleobiologia Humana da Universidade George Washington (GWU)

Moderação: Carlos Alfredo Joly, Universidade Estadual de Campinas (Unicamp)
as mudanças
transformadoras e o desenvolvimento de pessoas e
transformadoras e o desenvolvimento de pessoas
27 de outubro de 2023 | das 10h às 11h30
Laura Maureen B. Pereira
Global Change Institute of University of the Witwatersrand, Johanesburgo, África do Sul
Moderação: Carlos Alfredo Joly, Universidade Estadual de Campinas (Unicamp)
Inscrições e mais informações, acesse
fapesp.br/conferencias2023
5 CARTA DA EDITORA
6 NOTAS
CAPA
12 Melhorar a carreira e reformular os currículos é o caminho para reverter a escassez de professores na educação básica
18 Desvalorização social torna carreira docente pouco atrativa
ENTREVISTA
20 Casal de meteorologistas Pedro e Maria Assunção Dias conta como estudos na Amazônia fortaleceram ciência climática brasileira
INFRAESTRUTURA
26 Governo prevê R$ 7,9 bilhões para projetos de interesse da comunidade científica
RECURSOS HUMANOS
30 Competição estimula alunos da rede estadual de ensino de São Paulo a prestar vestibular na USP
INDICADORES
34 Relatório de atividades mostra como a FAPESP ampliou o financiamento em 2022
BOAS PRÁTICAS
38 Site que avalia artigos já publicados vira plataforma de denúncias de má conduta
DADOS
41 Inclusão na universidade e escolaridade superior de jovens adultos
Pássaros taxidermizados para exposição em museu (ITINERÁRIOS DE PESQUISA , P. 94)
FÍSICA
42 Supostos supercondutores à temperatura ambiente geram debate acalorado
COVID-19
48 Estratégias não medicamentosas ajudaram a reduzir o impacto do novo coronavírus
VIROLOGIA
52 Causador da febre amarela circula de modo ininterrupto há sete anos no Centro-Sul do Brasil
GENÉTICA
54 Costa do Chile ou do Peru é origem do vírus da gripe aviária que se espalha pelo país
ECOLOGIA
55 Orquídea usa armadilha para atrair moscas polinizadoras
EVOLUÇÃO
58 Abelhas surgiram há 120 milhões de anos no supercontinente formado pelas atuais América do Sul e África
CONSERVAÇÃO
60 Caça para a subsistência em reservas extrativistas tem impacto limitado sobre animais silvestres

AMBIENTE
62 Microplásticos são encontrados em todo o litoral brasileiro
ENERGIA
68 As novas técnicas para reciclar baterias veiculares de lítio
BIOTECNOLOGIA
72 Sensor de papelão pode monitorar a qualidade da água
POLÍTICAS PÚBLICAS
74 Aumento no número de mortes no trânsito exige melhorias em estradas e campanhas educativas
CIÊNCIA POLÍTICA
80 Dados da Receita
Federal mapeiam um século de expansão de igrejas evangélicas
FOTOGRAFIA
84 A atuação de fotógrafos italianos no Brasil do século XIX

OBITUÁRIOS
88 Antonio Galves (1947-2023)
89 Alberto Setzer (1951-2023)
MEMÓRIA
90 Identificado há 40 anos, o HIV mudou a visão sobre doenças infecciosas
ITINERÁRIOS DE PESQUISA
94 O taxidermista
Paulo César Balduíno monta animais para mostras e coleções científicas
Vincenzo Pastore documenta o próprio trabalho ao retratar um homem, por volta de 1900 (FOTOGRAFIA , P. 84)
VÍDEO
Os psicodélicos e a depressão Novas descobertas abrem caminho para a produção de medicamentos que podem ajudar quem tem o problema
VÍDEO
O punk no Brasil
Documentos revelam contexto social e político em que o gênero se desenvolveu no país
PODCAST
Transplantes, sensor de poluentes e Bob Esponja
RESENHA
96 Juventude e contracultura, de Marcos Napolitano. Por Patrícia
Marcondes de Barros
97 COMENTÁRIOS
98 FOTOLAB
As estratégias para ampliar a doação de órgãos e o número de cirurgias no Brasil. E mais: ciência em Bob Esponja; academia sob nova direção; sensor de poluentes
Este conteúdo está disponível no site www.revistapesquisa.fapesp.br, que contém, além de edições anteriores, versões em inglês e espanhol e conteúdo exclusivo



Comunidade Jurucuá, localizada na reserva extrativista Médio Purus, em Lábrea, no Amazonas (CONSERVAÇÃO, P. 60)

Alexandra Ozorio de Almeida | DIRETORA DE REDAÇÃO
Nos depoimentos de alunos do ensino médio que se inscreveram na Competição de Conhecimentos e Oportunidades da USP, o incentivo de professores é um reconhecimento recorrente. As premiações incluíram uma formação complementar preparativa para o vestibular e, para muitos estudantes, a descoberta de que havia espaço para eles no ensino superior público (página 30).
A importância de seus professores também aparece na fala do taxidermista Paulo César Balduíno, que já montou milhares de animais para exibição em museus e coleções científicas e é destaque da seção Itinerários de Pesquisa deste mês (página 94). Depoimentos desse tipo são corriqueiros quando o tema é educação e trajetórias profissionais, sinal inequívoco da relevância dos docentes e de seu impacto na vida dos alunos.
Há, entretanto, um hiato entre a inconteste importância da carreira de professor e a sua atratividade. Estudos, um deles inédito, do Instituto Nacional de Estudos e Pesquisas Educacionais (Inep), vinculado ao Ministério da Educação, mostram que as matrículas em licenciaturas caíram e o número de formandos também se reduziu.
Dados da instituição apontam ainda que somente um terço dos licenciados vai atuar na docência.
O que vem sendo considerado um apagão de professores não é uma ameaça futura, mas sim uma realidade: ainda segundo o Inep, em 2022, apenas cerca de 60% das vagas de docentes no ensino fundamental II eram ocupadas por professores qualificados na área do conhecimento correspondente. A reportagem de capa traz dados relevantes para uma reflexão urgente acerca da educação básica no Brasil, que vem apresentan-
do avanços e não pode retroceder pela falta de pessoal especializado (página 12).
É rara, nesta revista, a publicação de uma entrevista em dupla, mas neste mês houve um bom motivo para trazermos dois entrevistados em conjunto: os meteorologistas Pedro Leite e Maria Assunção Dias são casados há 50 anos e se dedicam a pesquisar temas muito próximos. Enquanto ele é especialista em modelagem climática nos trópicos, ela estuda a interação do clima com a floresta amazônica (página 20). Na entrevista, eles contam como estudos na Amazônia deram peso à pesquisa climática brasileira.
Cobrir um amplo leque de áreas do conhecimento é um dos pilares de Pesquisa FAPESP. A equipe procura, mensalmente, pautas para garantir a diversidade temática, cada uma com suas especificidades e complexidades. Nesta edição, os mais recentes episódios da busca pelos materiais supercondutores ganham ar de série de streaming na narrativa do editor Marcos Pivetta (página 42). A história de um objetivo científico que é perseguido há mais de 100 anos tem, nessa nova temporada, tons de aventura e drama, explicada com clareza para que leitores que chegam agora também acompanhem a história.
Para fechar, a divertida história de uma orquídea do Cerrado que engana as moscas que a polinizam. Atraídos com falsa oferta de alimento – as chamadas orquídeas-sapatinho parecem oferecer abundância de pequenos pulgões, mas não passa de uma ilusão de ótica, mostram pesquisadores da Universidade Federal de Uberlândia –, os insetos acabam por escorregar para dentro da flor. O spoiler é que elas conseguem escapar; para saber como, vá diretamente à página 55.
Comum nas bacias sul-americanas do Amazonas e do rio da Prata, a planta aquática aguapé (Eichhornia crassipes) é a espécie invasora mais disseminada pelo mundo, segundo o relatório da Plataforma Intergovernamental de Políticas Científicas sobre Biodiversidade e Serviços Ecossistêmicos (Ipbes), ligada à Organização das Nações Unidas (ONU). No lago Vitória, na África Oriental, por impedir a passagem de luz e a oxigenação da água, a planta aniquilou populações de tilápias, recurso pesqueiro importante. Além de exportar espécies, as Américas também sofrem invasões. “Um exemplo é Limnoperna fortunei, o mexilhão-dourado”, conta o biólogo Ricardo Pinto Coelho, professor aposentado da Universidade Federal de Minas Gerais e hoje pro-
prietário da empresa RMPC Meio Ambiente Sustentável, único brasileiro no painel de especialistas da Ipbes. “Nas águas brasileiras, esses moluscos causam problemas para a aquacultura e na operação de usinas, onde ficam incrustados nos sistemas de refrigeração.” Outro exemplo: o mosquito Aedes aegypti, originário da África, transmite os agentes causadores da dengue, zika e de outras doenças. O relatório afirma que as atividades humanas causaram a disseminação de mais de 37 mil espécies de plantas, animais e microrganismos, com papel central em 60% das extinções globais. Em 2019, o impacto econômico das espécies invasoras ultrapassou US$ 423 bilhões anuais, cerca de R$ 2 trilhões (ipbes.net, 4 de setembro).

Especialista em mecanismos neurocomportamentais do movimento humano, Shlomi Haar se prepara para avaliar as possibilidades de uso da Meias Inteligentes (SmartSocks) com 15 pessoas em um laboratório do Instituto de Pesquisas sobre a Demência, do Imperial College London (ICL), no Reino Unido, onde as atividades diárias se dão como se fosse na sala de estar de uma casa. Desenvolvidas pela startup Milbotix, sediada em Chipping Norton, as meias contêm sensores que medem a frequência cardíaca, os níveis de transpiração e o movimento. Se aceitas pelos potenciais usuários, elas poderiam ajudar no monitoramento remoto de pessoas com demência, que nem sempre se dão bem com as pulseiras usadas atualmente para acompanhar o bem-estar dos idosos com problemas cognitivos. As meias seriam uma solução – pelo menos em condições climáticas nas quais essa peça do vestuário é natural e cotidiana –, já que ao usuário parecem comuns. Zeke Steer, diretor da Milbotix, resolveu criar essas peças após testemunhar a evolução da demência de sua bisavó. Ávido por ajudá-la, desistiu de seu emprego na indústria de defesa e fez um doutorado em robótica, no qual se interessou pelas chamadas tecnologias vestíveis (newsletter do Imperial College London, 10 de agosto).

Representação gráfica da Aditya-L1 aproximando-se de seu objetivo
A Índia está fazendo história espacial. No final de agosto, logo depois de pousar perto do polo sul da Lua, a sonda Chandrayaan-3 enviava as primeiras imagens da face oculta do único satélite natural terrestre. Uma semana depois, a Organização Indiana de Pesquisa Espacial (Isro) anunciou que o instrumento de espectroscopia de ruptura induzida por laser (Libs), a bordo da sonda, identificou pela primeira vez os elementos químicos da superfície daquela região. Por meio de pulsos de laser, o aparelho registrou, de modo inequívoco, enxofre e, preliminarmente, alumínio, cálcio, ferro, cromo, titânio, manganês, silício e oxigênio. Com ela, a Índia tornou-se o quarto país a chegar à superfície da Lua, após os Estados Unidos, a China e a Rússia. No início de setembro, a Índia lançou sua primeira missão de observação do Sol, a Aditya-L1, que viajará 1,5 milhão de quilômetros em quatro meses. Se a missão for bem-sucedida, a Índia será um dos poucos países que estudam o Sol. O Japão lançou uma sonda em 1981 e as agências espaciais dos Estados Unidos e da Europa observam o Sol desde a década de 1990 (Isro, 28 de agosto; BBC, 2 de setembro).

A violência doméstica contra as mulheres prejudica também as crianças que a testemunham, indicou um estudo conduzido por pesquisadores da Universidade Federal de Pelotas (UFPel), no Rio Grande do Sul. As conclusões se apoiam na Coorte de Nascimentos de Pelotas de 2015, que inclui todos os nascimentos hospitalares ocorridos entre 1º de janeiro e 31 de dezembro de 2015, na cidade de Pelotas. Dos 4.275 nascidos vivos participantes da coorte, a amostra incluiu 3.730 e 3.292 duplas de mães e filhos acompanhados aos 4 anos e aos 6-7 anos de idade, respectivamente. As relações parentais foram avaliadas por meio de filmagens da mãe e da criança em tarefas interativas, avaliadas por uma equipe de psicólogos, e de entrevistas com mulheres dos dois grupos. Coordenadas pela epidemiologista da UFPel Carolina Coll, as análises indicaram a alta prevalência da chamada violência praticada entre parceiros íntimos (VPI): 21,9% das mães relataram ter sofrido violência emocional e 9,4% física ou sexual nos 12 meses anteriores à entrevista. A experiência de violência prejudicou o relacionamento entre mães e filhos, debilitou a chamada consistência parental, expressa pela comunicação e interação com as crianças, e induziu a comportamentos coercitivos dos pais, com resultados semelhantes nos dois grupos (Lancet Global Health, setembro).
Problema de saúde pública mundial, as cáries dentárias afetam cerca de 2,5 bilhões de pessoas no mundo e resultam da interação entre uma alimentação rica em açúcares e os microrganismos existentes na boca, ampliada por uma higiene oral precária. Investigando as variedades de microrganismos existentes na cavidade oral de 416 crianças em idade pré-escolar nos Estados Unidos, pesquisadores da Universidade da Carolina do Norte em Chapel Hill e da Universidade da Pensilvânia, ambas nos Estados Unidos, identificaram 16 espécies de bactérias encontradas em maior quantidade nas crianças com cárie. Uma delas, Streptococcus mutans, já era bem conhecida dos dentistas por estar associada a esse tipo de deterioração dos dentes. Ela não age sozi-

Enquanto dorme, embora não pareça, seu cachorro pode estar ouvindo o que você faz. Especialistas em comportamento animal da Universidade Eötvös Loránd, da Hungria, conectaram dispositivos que medem as ondas cerebrais em 13 cães (nove fêmeas e quatro machos, com idade entre 1 e 10 anos). Os animais foram expostos a sons de cães e humanos – gritos, gemidos, rosnados, tosses, risadas, suspiros e bocejos, sem estímulos negativos para não se assustarem – e os dados gravados enquanto estavam acordados, sonolentos ou depois de relaxarem e adormecerem. Mesmo quando estavam em sono mais profundo, os cães aparentemente conseguiam distinguir se um ruído vinha de outro companheiro peludo ou de uma pessoa e se a comunicação era positiva ou neutra. Os autores do trabalho, embora reconheçam que mais pesquisas são necessárias, sugerem que os circuitos neurais dos cães diferenciam vocalizações e fornecem evidências do complexo processamento vocal durante o sono. Essa capacidade já havia sido detectada em primatas e roedores, como ratos (Scientific Reports, 4 de setembro; ScienceAlert, 12 de setembro).

nha. O grupo, do qual participa o brasileiro de origem coreana Hyun Koo, verificou que ao menos outras três – Selenomonas sputigena, Prevotella salivae e Leptotrichia wadei – também desempenham um papel importante. Todas são capazes de transformar os açúcares livres dos alimentos em ácidos corrosivos. Em geral, elas dependem de S. mutans para formar o biofilme (placa bacteriana), colônias aderentes de bactérias que crescem sobre os dentes. Os testes de formação de biofilme in vitro e de agressividade das bactérias feitos com roedores mostraram, porém, que a combinação de S. mutans e S. sputigena foi a mais danosa. Ela formou biofilmes mais extensos e produziu mais ácido do que as outras espécies isoladamente (Nature Communications, 22 de maio).
Colônia de Rothia nasimurium, que converte ácidos graxos em hidrocarboneto
Após três anos e meio de trabalho, uma equipe do Laboratório Nacional de Biorrenováveis do Brasil (LNBR) do Centro Nacional de Pesquisa em Energia e Materiais (CNPEM) identificou uma enzima que poderia substituir os catalisadores tradicionais utilizados em rotas termoquímicas para a produção de bioquerosene de aviação. Chamada de descarboxilase ou OleTPRN, provém da bactéria Rothia nasimurium e converte ácidos graxos, componentes essenciais de gorduras, em uma classe de hidrocarbonetos conhecidos como alcenos ou olefinas, um intermediário da produção desse tipo de combustível. Essa capacidade permitiria a produção de hidrocarbonetos para a aviação a partir de plantas oleaginosas, como soja, macaúba ou milho, ou resíduos agrícolas, como o bagaço ou a palha da cana-de-açúcar. “A versatilidade dessa enzima permite que seja adaptada para uso em diferentes setores [da indústria], como alimentícia, cosmética, farmacêutica e de transportes”, comentou à Agência FAPESP a física Letícia Zanphorlin, coordenadora da pesquisa (PNAS, 22 de maio).
dupla que agrava as cáriesConsumo de doces, sem escovar os dentes depois, cria ambiente favorável às bactérias

Sabe qual o sítio arqueológico mais antigo do Brasil? E o mais próximo da sua casa? Essas informações estão disponíveis no site do projeto Brazilian Radiocarbon Database (brc14database. com.br). Construído pela equipe do arqueólogo Lucas Bueno, da Universidade Federal de Santa Catarina (UFSC), o site reúne 3.769 datações de 1.249 sítios arqueológicos brasileiros registrados no Cadastro Nacional de Sítios Arqueológicos (CNSA). No ar desde 2021, permite aos usuários colaborar para a atualização das informações. Bueno e seus colegas completaram os registros do CNSA com informações de 459 documentos (artigos científicos, teses e dissertações) sobre a localização dos sítios e a idade de
Carros sem motorista, ainda em testes, não conseguem detectar crianças e pedestres de pele mais escura tão bem quanto adultos de pele mais clara, aumentando, assim, o risco de atropelar quem não identifica corretamente. Após testar oito sistemas de detecção de pedestres alimentados por 8.311 imagens com 16.070 identificadores de gênero, 20.115 de idade e 3.513 de tons de pele, pesquisadores do King’s College, em Londres, verificaram que a detecção para adultos era 19,67% maior em comparação com a de crianças e 7,52% mais precisa para pedestres de pele clara que para pedestres de pele mais escura; o gênero mostrou uma diferença de apenas 1,1%. Isso ocorre porque os programas de inteligência artificial são treinados com fotos que mostram mais pessoas com pele clara do que com pele escura. “O perigo que os carros autônomos podem representar é grande”, disse Jie Zhang, uma das autoras do estudo, em um comunicado de imprensa. “As pessoas de grupos minoritários podem enfrentar lesões graves.” Segundo ela, fabricantes dos chamados autônomos e governo deveriam se unir para promover o tratamento igualitário para os pedestres (ArXiv.org, 5 de agosto; King’s College London, 23 de agosto; PCMag, 28 de agosto).
materiais neles encontrados. Um mapa interativo permite acessar informações de cada sítio, com o número de datações realizadas e datas mais antigas e mais recentes. As mais longínquas são dos sítios Abrigo do Morro Furado, na Bahia, e Boqueirão da Pedra Furada, no Piauí, ambos com cerca de 40 mil anos. “Uma rápida comparação entre a quantidade de sítios para os quais conseguimos, até o momento, reunir dados sobre datações radiocarbônicas e a quantidade de sítios registrados hoje no CNSA, dá uma dimensão do que precisa ser feito”, afirmam os autores em um artigo científico no qual descrevem o projeto (Boletim do Museu Paraense Emílio Goeldi, 2023).


A Masdar, empresa de energia limpa dos Emirados Árabes Unidos (EAU), e a Africa50, plataforma pan-africana de investimento em infraestrutura, anunciaram em setembro uma parceria para identificar, acelerar e dimensionar projetos de energia limpa em todo o continente. Mohamed Jameel Al Ramahi, CEO da Masdar, comentou: “Nosso portfólio [de energias limpas] inclui o primeiro parque eólico de grande escala do Senegal, o primeiro e maior projeto solar fotovoltaico da Mauritânia e o desenvolvimento do maior parque eólico da África, no Egito”. Ligada ao Etihad 7, plataforma de desenvolvimento lançada pelos EAU na Semana de Sustentabilidade de Abu Dhabi em 2022, tem como meta fornecer eletricidade limpa a 100 milhões de pessoas em todo o continente africano até 2035. A iniciativa reúne capital privado e público, além de instituições dos EAU, como o Fundo para o Desenvolvimento de Abu Dhabi. A Masdar comprometeu-se com um total de US$ 10 bilhões em financiamento de energia limpa, dos quais US$ 2 bilhões de capital próprio e US$ 8 bilhões de financiamento de projetos (Africa Science News, 7 de setembro).
No cérebro, além dos neurônios, há micróglias, células pequenas com ramificações. Elas protegem o sistema nervoso central ao combater agentes infecciosos e ajudar na eliminação de células mortas. A neurocientista Katherine Prater e o bioquímico Kevin Green, ambos da Universidade de Washington em Seattle, extraíram amostras de micróglia do cérebro de pessoas que morreram com a doença de Alzheimer e de indivíduos sem a enfermidade e compararam o padrão de ativação dos genes. Comparativamente, as micróglias de quem tinha Alzheimer exibiram mais genes ativos associados à inflamação. Embora necessária para eliminar microrganismos invasores e células doentes, a inflamação, quando se intensifica ou se prolonga, torna-se nociva: compostos inflamatórios podem danificar células saudáveis e contribuir para a progressão do Alzheimer. A identificação desse perfil torna as micróglias um potencial alvo para o desenvolvimento de novas terapias para o Alzheimer, embora até o momento testes com anti-inflamatórios não tenham mostrado efeitos significativos (Nature Aging, 29 de maio; ScienceAlert, 26 de agosto).
Um macaco que pesava cerca de 230 gramas, batizado com o nome Ashaninkacebus simpsoni, inseriu novas discussões na história da origem dos primatas amazônicos. Até aqui, todos os fósseis encontrados tinham parentesco com os macacos atuais da América do Sul, com origem na África. A nova espécie tem semelhanças dentárias com um pequeno grupo extinto de macacos do sul da Ásia e não deu origem a nenhum animal moderno, por isso é considerado um beco sem saída da evolução. Uma equipe franco-brasileira chegou a essa conclusão a partir de um minúsculo dente, um molar superior menor do que um grão de arroz, encontrado em uma barranca do alto rio Juruá, no Acre, próximo ao Peru. “Os antepassados de Ashaninkacebus devem ter atravessado o oceano Atlântico em uma balsa natural formada por restos vegetais, por volta do Eoceno Médio, entre 40 milhões e 35 milhões de anos atrás”, comenta o biólogo Francisco Ricardo Negri, do campus de Floresta da Universidade Federal do Acre (Ufac). Por serem pequenos, os macacos precisavam de pouco alimento e possivelmente teriam sobrevivido à viagem comendo restos vegetais. A. simpsoni foi o terceiro primata a chegar na Amazônia. Antes dele, outras duas espécies de macacos pequenos já haviam feito a mesma travessia, provavelmente também de balsa (PNAS, 3 de julho).

Por causa do derretimento do gelo em novembro/dezembro, na primavera do hemisfério Sul, não sobreviveu nenhum filhote em quatro das cinco colônias de reprodução dos pinguins-imperadores (Aptenodytes forsteri) na Antártida. Como fazem todos os anos, as fêmeas depositaram os ovos em maio e junho no chamado gelo rápido, que se forma em abril, e os chocaram durante 65 dias. Mas essa borda da superfície se rompeu e os filhotes ainda indefesos, com a penugem incompleta, caíram nas geladas águas antárticas. A região com maior perda foi a do mar de Bellingshausen, a oeste da península. Em apenas um local, a ilha Rothschild, com 650 casais reprodutores, os filhotes conseguiram emplumar e sobreviver. Cada colônia pode abrigar até 3.500 casais. Caso a tendência de redução da superfície de gelo da Antártida continue, em razão das mudanças do clima, mais de 90% das colônias de pinguins-imperadores poderão se extinguir até ao final deste século, alertaram pesquisadores do Instituto Britânico de Pesquisa Antártica, que identificaram a mortandade no final do ano passado (Communications Earth & Environment, 24 de agosto; ScienceAlert, 25 de agosto).

Desde os anos 1980, a produtividade da soja sofre uma redução de 6% para cada aumento de 1 grau Celsius (°C) na temperatura. Para chegar a esse resultado, pesquisadores brasileiros examinaram os efeitos da variação da temperatura e da pluviosidade médias anuais de 1980 a 2018 em 322 municípios da região conhecida como Matopiba, área de transição entre o Cerrado e a Amazônia formada por partes dos estados do Maranhão, Tocantins, Piauí e Bahia. A equipe, coordenada pelo economista brasileiro Daniel Silva, da Universidade do Texas, entrevistou 90 fazendeiros da região para examinar as práticas agrícolas e as percepções das mudanças do clima. Eles atribuem a elevação da temperatura média a oscilações cíclicas do clima, mas não relacionam a perda de vegetação com a redução das chuvas. A elevação da temperatura também implica aumento do endividamento, por exigir mais capital para investir em irrigação e tecnologias para mitigar perdas com a seca (International Journal of Agricultural Sustainability, fevereiro).
Uma análise de pesquisadores da Universidade Federal do Rio de Janeiro nas 14 áreas urbanas mais populosas do país registrou um excesso (valor além do normal) de 48.075 mortes relacionadas às ondas de calor verificadas de 2000 a 2018, principalmente nas regiões Norte, Nordeste e Centro-Oeste. As Regiões Metropolitanas de São Paulo, Rio de Janeiro, Porto Alegre, Recife, Belém e Cuiabá apresentaram as maiores taxas de mortalidade relacionadas ao calor. Os grupos mais vulneráveis foram de idosos, mulheres, pessoas autodeclaradas pretas e pardas, com menor nível de escolaridade ou comorbidades, como o câncer. As principais causas de morte durante as ondas de calor estavam associadas com doenças cardiovasculares e respiratórias. Os autores desse estudo acentuam que “o fortalecimento da atenção primária à saúde combinado com a redução das desigualdades socioeconômicas e de gênero representa um passo crucial para reduzir as mortes relacionadas ao calor no Brasil”. De acordo com uma análise da mortalidade e temperatura entre 326 cidades da América Latina, para cada 1 grau Celsius (oC) de aumento de temperatura, estima-se uma elevação de 5,7% no risco de morte, em especial entre idosos com doenças cardiovasculares ou câncer (preprint, SSRN).
 Grupo de pinguins-imperadores, cada vez mais raros
Grupo de pinguins-imperadores, cada vez mais raros

Brasil registra déficit de professores habilitados para lecionar em todas as áreas do conhecimento
Christina QueirozUma medida paliativa vem ocorrendo com frequência cada vez maior em escolas públicas e privadas de todo o país. Muitos estudantes estão finalizando o ano letivo de 2023 sem ter tido aulas de física ou sociologia com professores habilitados para ministrar essas disciplinas. Diante da ausência de candidatos para ocupar as docências, as escolas improvisam e colocam profissionais formados em outras áreas para suprir lacunas no ensino fundamental II e no ensino médio. A medida tem se repetido em diferentes estados e municípios brasileiros, como mostram dados de estudo inédito realizado por pesquisadores do Instituto Nacional de Estudos e Pesquisas Educacionais (Inep): em Pernambuco, por exemplo, apenas 32,4% das docências em física no ensino médio são ministradas por licenciados na disciplina, enquanto no Tocantins o valor equivalente para a área de sociologia é de 5,4%. Indicativo da falta de interesse dos jovens em seguir carreira no magistério, o número de concluintes de licenciaturas em áreas específicas passou de 123 mil em 2010 para 111 mil em 2021. Esse conjunto de dados indica que o país vivencia um quadro de apagão de professores. Para reverter esse cenário, pesquisadores defendem a urgência da criação de políticas de valorização da carreira docente e a adoção de reformulações curriculares.
“O apagão das licenciaturas é uma realidade que nos preocupa”, afirma Marcia Serra Ferreira, da Universidade Federal do Rio de Janeiro (UFRJ) e diretora de Formação de Professores da Educação Básica da Coordenação de Aperfeiçoamento de Pessoal de Nível Superior (Capes). As licenciaturas em áreas específicas são cursos superiores que habilitam os concluintes a dar aulas nos anos finais do ensino fundamental e no
ensino médio na área do conhecimento em que se formaram. Dados do último Censo da Educação Superior do Inep, autarquia vinculada ao Ministério da Educação (MEC), divulgados no ano passado, mostram que desde 2014 a quantidade de ingressantes em licenciaturas presenciais está caindo, assim como ocorre em cursos a distância desde 2021. “As áreas mais preocupantes são as de ciências sociais, música, filosofia e artes, que apresentaram as menores quantidades de matrículas em 2021, e as de física, matemática e química, que registraram as maiores taxas de desistência acumulada na última década”, assinala Ferreira (ver gráfico na página 14).
Dados do Inep disponíveis no Painel de Monitoramento do Plano Nacional de Educação (PNE) indicam que, em 2022, cerca de 59,9% das docências do 6º ao 9º ano do ensino fundamental e de 67,6% daquelas oferecidas no ensino médio eram ministradas por professores qualificados na área do conhecimento. Ao analisar os números, o pedagogo e professor de educação física Marcos Neira, pró-reitor adjunto de Graduação da Universidade de São Paulo (USP), comenta que a situação é diferente em cada área do conhecimento. “Por um lado, a média nacional mostra que 85% dos docentes de educação física são licenciados na disciplina, enquanto os percentuais equivalentes para sociologia e línguas estrangeiras são de 40% e 46%, respectivamente. Ou seja, os problemas podem ser maiores ou menores conforme a área do conhecimento e também são diferentes em cada estado”, destaca Neira, que atualmente desenvolve pesquisa com financiamento da FAPESP sobre reorientações curriculares na disciplina de educação física.
A falta de formação adequada do professor pode causar impactos no processo de aprendizagem dos alunos, conforme identificou Matheus Monteiro Nascimento, físico da Universidade
Políticas para melhorar a atratividade da carreira e reformular currículos é o caminho para reverter cenário de escassez docente na educação básica
Federal do Rio Grande do Sul (UFRGS), em pesquisa realizada em 2018. De acordo com o pesquisador, na ausência de docentes licenciados em física, quem acaba oferecendo a disciplina nas escolas, geralmente, são profissionais da área de matemática. “Com isso, observamos que a abordagem da disciplina tende a privilegiar o formalismo matemático”, comenta. Ou seja, no lugar de tratar de conhecimentos de mecânica, eletricidade e magnetismo por meio de abordagens fenomenológicas, conceituais e experimentais, os professores acabam trabalhando os assuntos em sala de aula apenas através de operações matemáticas e equações sem relação direta com a realidade do aluno. “O formalismo matemático é, justamente, o elemento da disciplina de física que mais prejudica o interesse de estudantes por essa área do conhecimento”, considera Nascimento.
Preocupados em mensurar se as defasagens poderiam ser sanadas com a contratação de profissionais formados em licenciaturas no Brasil nos últimos anos, pesquisadores do Inep realizaram, em setembro, estudo no qual olharam para as carências de escolas públicas e privadas nos anos finais do ensino fundamental e médio.
“Se todos os licenciados de 2010 a 2021 ministrassem aulas na disciplina em que se formaram nos anos finais do ensino fundamental e no ensino médio em 2022, ainda assim o país teria dificuldades para suprir a demanda por docentes de artes em 15 estados, física em cinco, sociologia

em três, matemática, língua portuguesa, língua estrangeira e geografia em um”, contabiliza Alvana Bof, uma das autoras da pesquisa. Além disso, o estudo avaliou se a quantidade de licenciados de 2019 a 2021 seria suficiente para suprir todas as docências que, em 2022, estavam sendo oferecidas por professores sem formação adequada. Foi constatado que faltariam docentes de artes em 18 estados, física em 16 estados, língua estrangeira em 15, filosofia e sociologia em 11, matemática em 10, biologia, ciências e geografia em 8, língua portuguesa em 5, história e química em 2 e educação física em um estado. “Os resultados indicam que já vivemos um apagão de professores em diferentes estados e disciplinas”, reitera Bof, licenciada em letras e com doutorado em educação (ver gráficos nas páginas 16 e 17).
Outro autor do trabalho, o sociólogo do Inep Luiz Carlos Zalaf Caseiro esclarece que o cenário de falta de professores não está relacionado com falta de vagas em cursos de licenciaturas. “Em 2021, o país teve 2,8 milhões de vagas disponíveis, das quais somente 300 mil foram preenchidas. Isso significa que 2,5 milhões de vagas ficaram ociosas, sendo grande parte no setor privado e na modali-
À direita, alunos do curso de licenciatura em química na USP e, abaixo, estudantes em escola de São Paulo em aula de artes: disciplinas registram altos patamares de carência de professores
De 2012 a 2021, a taxa de desistência acumulada de alunos matriculados em cursos de física foi de 72%
Taxa de desistência acumulada Taxa de conclusão acumulada Taxa de permanência*

dade de ensino a distância”, relata. Licenciaturas oferecidas no ensino público, na modalidade presencial, também tiveram quantidade significativa de vagas ociosas. “De 2014 a 2019, a taxa de ociosidade de licenciaturas em instituições públicas foi de cerca de 20%, enquanto em 2021 esse percentual subiu para 33%”, informa. Cursos como o de matemática apresentaram situação ainda mais alarmante. “Licenciaturas de matemática em instituições públicas no formato presencial registraram 38% de vagas ociosas em 2021”, destaca Caseiro, comentando que muitas vagas, mesmo quando preenchidas, logo são abandonadas. Além disso, segundo o sociólogo, somente um terço dos estudantes que finalizam as licenciaturas vai atuar na docência; o restante opta por outros caminhos profissionais. O estudo foi desenvolvido a partir do cruzamento de dados relativos a docentes presentes no Censo da Educação Básica e referentes a ingressantes e concluintes em licenciaturas captados pelo Censo da Educação Superior. Ambas as pesquisas são realizadas anualmente pelo Inep para analisar a situação de instituições, alunos e docentes da educação básica e do ensino superior.

Os cursos de licenciatura enfrentam, ainda, o desafio de atualizar seus currículos. Tomando como exemplo a área de física, Marcelo Alves Barros, físico da USP de São Carlos, explica que os licenciados na disciplina, tradicionalmente, recebem formação pautada em uma abordagem com pouca conexão com outras disciplinas e a realidade do estudante da educação básica. Essa forma tradicional de pensar o conteúdo de física e ministrá-lo em sala de aula, conforme Barros, difere de diretrizes estabelecidas por documentos oficiais, entre eles a Base Nacional Comum Curricular (BNCC) do ensino médio. Homologada em 2018, a BNCC dessa etapa
de ensino determina que os currículos escolares devam deixar de ser organizados conforme disciplinas para passarem a funcionar por meio de áreas do conhecimento. Com isso, aulas de física, por exemplo, poderiam ser integradas à grande área de ciências da natureza e suas tecnologias que abarca, também, conteúdos de química e biologia. “Apesar da proposta interdisciplinar ser aspecto positivo da BNCC, a maioria dos professores de física do país não está preparada para atuar com esse viés nas escolas”, avalia Barros. Na perspectiva do pesquisador, o novo ensino médio – criado pela Lei nº 13.415, em 2017, prevendo a flexibilização da grade curricular por meio da oferta dos chamados itinerários formativos (ver Pesquisa FAPESP nº 316) – traz desafios à formação tradicional de graduados em física. Isso porque os professores licenciados na disciplina não são preparados para ministrar aulas alinhadas com as propostas do novo ensino médio. “O descompasso entre o currículo atual do ensino médio e os conhecimentos do professor prejudica o processo de aprendizagem dos estudantes. Mais tarde, as deficiências no ensino de física na educação básica contribuem para que o jovem não queira cursar licenciatura nessa área do conhecimento”, relaciona. Segundo Barros, o caso do Instituto de Física da USP de São Carlos constitui exceção, na medida em que desde a década de 1990 os alunos da licenciatura recebem formação interdisciplinar, concluindo o curso aptos para lecionar aulas de ciência, física, química e matemática tanto para turmas do 6º ao 9º ano do ensino fundamental como para o ensino médio. Seguindo esse modelo, o pesquisador sustenta que currículos das licenciaturas em física devam ser reformados para aproximar a disciplina dos avanços da ciência moderna, tratando de temas atuais de mecânica quântica, relatividade e astrofísica e buscando desenvolver metodologias inovadoras de ensino. “Para que essa abordagem possa ser aplicada em sala de aula, um ponto-chave são as escolas contarem com laboratórios de atividades experimentais, que podem ajudar a conquistar o interesse de alunos”, aponta Barros, integrante de projeto financiado pela FAPESP voltado à busca por estratégias de renovação do ensino de ciência.
A BNCC e a reforma do ensino médio também trouxeram desafios para as licenciaturas em história, assegura Marieta de Moraes Ferreira, historiadora da UFRJ. “As novas diretrizes enxugaram os conteúdos específicos de áreas como sociologia, história e filosofia que devem ser ministrados na educação básica, em prol de uma abordagem interdisciplinar. Porém os professores não foram preparados para atuar com essas mudanças”, enfatiza Ferreira. Ela recorda que as primeiras graduações nessa área do co -

nhecimento foram criadas no Brasil nos anos 1930 com foco na formação de professores. Mais tarde, na década de 1970, com a expansão de programas de pós-graduação, as instituições de ensino passaram a valorizar atividades de pesquisa nessa disciplina, de forma que a preocupação em formar alunos para o magistério ficou em segundo plano. O debate sobre o ensino de história voltou à cena nos anos 2000, quando as instituições passaram a diferenciar quem queria ser licenciado e dar aulas de quem se graduaria como bacharel para atuar como pesquisador. “Não concordo com essa divisão e penso que não dá para ser professor sem saber pesquisar. Para formar melhores docentes, as licenciaturas deveriam articular atividades de ensino com pesquisas focadas em questões suscitadas pelo ambiente escolar”, propõe.

Ao refletir sobre a BNCC, o matemático Jorge Herbert Soares de Lira, da Universidade Federal do Ceará (UFC), concorda que a nova base curricular pode trazer melhorias aos processos de ensino e aprendizagem, mas as mudanças precisam ser trabalhadas com alunos formados nas licenciaturas. Lira, que também é cientista-chefe da Secretaria de Educação (Seduc) daquele estado, considera que, no caso da matemática, é preciso incentivar a integração entre o enfoque aprofundado no conteúdo e estratégias de ensino. Na última edição do Programa Internacional de Avaliação de Estudantes (Pisa), estudo da Organização para a Cooperação e o Desenvolvimento Econômico (OCDE) para analisar o desempenho de estudantes nas áreas de matemática, ciências e leitura, o Brasil ficou entre os 10 países do mundo com pior desempenho em matemática.
Em 2018, para entender as razões pelas quais o desempenho dos alunos em matemática não progredia ou até recuava a partir de seu ingresso no ensino fundamental II, um grupo de pesquisadores da UFC liderados por Lira realizou um levantamento em parceria com a Seduc. “Diretores e coordenadores se perguntavam por que na virada do fundamental I para o II o desempenho matemático dos alunos não avançava tanto quanto em outras áreas”, conta. “Então, resolvemos investigar a fundo a origem desse problema.” Foram analisados dados históricos de estudantes da rede pública do Ceará do ensino fundamental até o final do ensino médio, mapeando curvas de aprendizagem e detectando os gargalos que começavam de forma massiva na passagem do ensino fundamental I para o II. Em paralelo, desenvolveram análise para avaliar o conhecimento pedagógico de professores, identificando a existência de lacunas envolvendo conceitos básicos que são trabalhados desde os anos iniciais do ensino fundamental, entre

Acima, alunos do ensino médio em escola de Fortaleza, no Ceará, estado que criou estratégia para melhorar a formação docente em matemática. Ao lado, aula de história em escola de Rio Branco, no Acre

eles frações, leitura de gráficos e tabelas, o sistema de numeração decimal e as operações aritméticas. “ Os docentes têm lacunas na compreensão profunda dessa matemática básica e em habilidades complexas próprias do ensino de conceitos fundantes ministrados nos primeiros anos da educação básica, que são retomados em toda a trajetória curricular. Assim, não estavam preparados para ensinar os alunos a utilizá-los em abordagens mais complexas, que começam a partir do 6º ano”, comenta Lira. A partir desse diagnóstico, a Seduc passou a promover avaliações periódicas para identificar os conteúdos nos quais os estudantes não progridem. Conforme os resultados das análises, a secretaria realiza processos formativos aos docentes com vistas a melhorar seu preparo para abordar os tópicos mais estruturais do currículo. “Nesses treinamentos, mostramos aos professores como retomar conhecimentos básicos e alinhá-los com competências complexas, por meio de estratégias pedagógicas nas quais os alunos são expostos a problemas em contextos cotidianos, científicos e sócio-econômicos”, conta o pesquisador, cujo projeto é financiado pela Fundação Cearense de Apoio ao Desenvolvimento Científico e Tecnológico (Funcap). Para Lira, aproximar estudantes
do conhecimento matemático durante a educação básica é uma forma de ampliar seu interesse por lecionar a disciplina no futuro.
Para evitar os problemas identificados por Lira no Ceará e resolver outros mapeados em São Paulo, Neira propõe atualizar os 28 programas de licenciatura da USP. O pró-reitor conta que a instituição desenvolve ações para apoiar coordenadores de cursos na reformulação de currículos.
“Queremos oferecer graduações com viés integrativo, abandonando a ideia de que a formação do bacharel deva ocorrer de forma separada daquela oferecida ao licenciado”, resume. A USP estuda uma parceria com a Secretaria de Educação do Estado de São Paulo para oferecer estágios remunerados em escolas públicas a alunos de licenciaturas.
Os pesquisadores defendem que as licenciaturas precisam se renovar para oferecer formações sólidas tanto no conteúdo da área do conhecimento como em questões de caráter prático e didático, preparando os alunos para saber como ensinar.
“Em todas as áreas do conhecimento, alunos de licenciaturas devem ter formação nas disciplinas específicas da educação, como políticas educacionais, teorias curriculares, planejamento e avaliação, gestão escolar e organização do trabalho pedagógico”, resume a pedagoga Márcia Aparecida Jacomini, da Universidade Federal de São Paulo (Unifesp). Segundo a pesquisadora, hoje, muitos cursos de licenciatura ainda enfatizam o ensino da disciplina em si, deixando de lado aspectos práticos e metodológicos fundamentais para o sucesso do processo de aprendizagem.
Christina Queiroz
Apesar da busca por construir um país civilizado e economicamente produtivo passar, necessariamente, pela boa formação de crianças e jovens, professores da educação básica têm enfrentado, nas últimas décadas, desafios envolvendo baixos salários, falta de acesso a laboratórios e bibliotecas escolares, assim como um processo de desvalorização social da profissão. Divulgado em 2021 pela Organização para a Cooperação e o Desenvolvimento Econômico (OCDE), o relatório “Education at a glance”, por exemplo, indicou que o piso salarial de docentes do ensino fundamental no Brasil é o mais baixo dentre as 40 nações analisadas, sendo menor do que em outros países latino-americanos como Colômbia e México.
No Brasil em 2019, o rendimento bruto médio mensal de profissionais do magistério com nível superior completo atuantes em redes públicas da educação
básica correspondia, em média, a 78% do valor registrado para outros profissionais assalariados com mesmo nível educacional, segundo o “Relatório do 3º ciclo de monitoramento das metas do Plano Nacional de Educação (PNE)”. O físico Mauricio Pietrocola, da Faculdade de Educação da Universidade de São Paulo (FE-USP), observa que além de salários insuficientes e classes lotadas, deficiências de aprendizagem acumuladas pelos alunos em toda a sua trajetória educacional são outros desafios enfrentados por docentes que, muitas vezes, acabam por desistir da profissão. “Vivo encontrando ex-alunos da licenciatura em física trabalhando em bancos. Muitos me dizem que gostariam de ser professores, mas optaram por prestar concurso para trabalhar em bancos públicos pelas melhores condições laborais”, relata Pietrocola, que é coordenador de projeto de pesquisa financiado pela FAPESP voltado à busca por estratégias inovadoras no ensino de ciências naturais.
A falta de docentes para atuar na educação básica é um fenômeno que vem se agravando nos últimos anos e, para ser mais bem compreendido, deve ser analisado em perspectiva histórica, segundo Pietrocola, que estuda a questão há cerca de 40 anos. De acordo com o pesquisador, entre 1970 e 2000, a escassez docente estava relacionada, principalmente, com a rápida expansão na quantidade de matrículas.
Ao recordar o cenário passado de crescimento acentuado em matrículas da educação básica, Lúcia Teixeira, presidente do Semesp, entidade que representa mantenedoras de ensino superior no Brasil, menciona que, entre as décadas de 1980 e 1990, o governo federal autorizava a contratação de pessoas sem formação na área para lecionar em escolas. Esse cenário começou a mudar em 1996, com o estabelecimento da Lei de Diretrizes e Bases (LDB), ou Lei nº 9.394, segundo a qual professores são obrigados a ter formação na disciplina

que oferecem. “Porém essa diretriz da LDB ainda não é integralmente cumprida”, afirma Teixeira. Em 2021, o número total de professores atuantes na educação básica foi de 2,2 milhões, segundo o Inep. Já a quantidade de docentes lecionando no ensino fundamental II caiu de 779 mil para 753 mil de 2016 a 2021, conforme pesquisa do Instituto Semesp divulgada em 2022. Os valores correspondentes para o ensino médio no mesmo recorte temporal foram de 520 mil e 516 mil. O Instituto Semesp estima que o déficit de professores na educação básica pode chegar a 235 mil em 2040.
Mas, ao contrário de décadas passadas, o problema atual de escassez docente se relaciona com um processo de desvalorização da carreira, na perspectiva de Pietrocola. Ao enfatizar que essa não é uma dificuldade exclusivamente brasileira, ele cita estudo da OCDE realizado com jovens concluintes da educação básica. “Em 2015, a pesquisa identificou qual era a média global de estudantes no mundo que estavam finalizando a educação básica e afirmavam que queriam se tornar professores, comparando os patamares médios com os percentuais de países e regiões”, diz. Conforme o estudo, o percentual médio do mundo caiu de 5,5% para 4,2% em 10 anos, enquanto no cenário
brasileiro o valor foi ainda menor, de 2,4%.
Já a média de países europeus foi de 20%
Por sua vez, Marcia Serra Ferreira, da Universidade Federal do Rio de Janeiro (UFRJ) e diretora de Formação de Professores da Educação Básica da Capes, menciona relatório elaborado em 2007 por uma comissão instituída na Câmara de Educação Básica do Conselho Nacional de Educação (CNE). O documento já alertava sobre um possível apagão de professores no ensino médio, caso providências urgentes não fossem tomadas no país. A partir daquele ano o governo federal criou diversas ações, entre elas o Programa Institucional de Bolsas de Iniciação à Docência (Pibid), oferecendo bolsas para que estudantes de licenciaturas atuem em escolas públicas da educação básica. “O programa beneficiou 317 mil alunos. Atualmente, mantém parcerias com 248 instituições de ensino superior e contempla 49,2 mil bolsistas de iniciação à docência em todo o Brasil”, afirma. Para 2024, devem ser instituídas 100 mil novas vagas para o programa, segundo Ferreira. O pedagogo Ocimar Munhoz Alavarse, da USP, reconhece a importância desses programas, mas afirma que as vagas são restritas e precisam ser ampliadas. “Eu tenho cerca de 300 alunos nos dois primeiros anos do curso de pedagogia elegíveis para receber as bolsas do Pibid, mas somente 24 conseguiram vagas para participar”, comenta.
Na avaliação de Alavarse, o Brasil deve expandir a quantidade de bolsas do Pibid a partir de análises sobre suas estatísticas educacionais, incluindo projeções demográficas futuras. “O envelhecimento da população brasileira captado pelo Censo pode fazer com que a demanda por professores diminua, nas próximas décadas, de forma que será preciso mensurar o déficit de professores, tendo em conta tendências demográficas”, propõe (ver Pesquisa FAPESP nº 330).
Vitor de Angelo, presidente do Conselho Nacional de Secretários de Educação, comenta que em 2023 o governo federal criou programas para ampliar as escolas de tempo integral e melhorar o processo de alfabetização de alunos do ensino fundamental I. “Porém ainda há muito o que ser feito em relação aos professores”, avalia Angelo, que também é secretário de Educação do Espírito Santo. Nesse sentido, ele recorda que o Plano Nacional de Educação (PNE), que determina diretrizes, metas e estratégias para a política educacional brasileira e com vigência de 2014 a 2024, está sendo reformulado. “O momento é oportuno. O novo PNE deve ser repensado de forma a contemplar ações para tornar a carreira docente mais atrativa, criando estratégias eficazes para atrair professores à educação básica”, finaliza Angelo. n
IDADE 71 anos
ESPECIALIDADE
Dinâmica da meteorologia de grande escala e modelagem atmosférica
INSTITUIÇÃO
Universidade de São Paulo (USP)
FORMAÇÃO Graduação em matemática aplicada pela USP (1974), mestrado (1977)
e doutorado (1979) em ciências atmosféricas pela Universidade Estadual do Colorado em Fort Collins, Estados Unidos
IDADE 71 anos
ESPECIALIDADE
Chuvas em sistemas tropicais e interação entre biosfera e atmosfera, particularmente na Amazônia
INSTITUIÇÃO
Universidade de São Paulo (USP)
FORMAÇÃO Graduação em matemática aplicada pela USP (1974), mestrado (1977)
e doutorado (1979) em ciências atmosféricas pela Universidade Estadual do Colorado em Fort Collins, Estados Unidos

Casal de meteorologistas conta como estudos sobre a atmosfera da Amazônia fortaleceram a ciência
climática brasileira e alerta sobre os desafios atuais
Marcos Pivetta | RETRATO Léo Ramos ChavesCasados há 50 anos, os meteorologistas Pedro Leite da Silva Dias e Maria Assunção Faus da Silva Dias dividem seu tempo atual entre a casa na cidade de São Paulo e uma fazenda de café em Arceburgo, município do sudoeste mineiro com 9 mil habitantes que faz divisa com a paulista Mococa. Professor titular do Instituto de Astronomia, Geofísica e Ciências Atmosféricas da Universidade de São Paulo (IAG-USP), Pedro passa a maior parte da semana na capital paulista. Desde que se aposentou do IAG em 2015, quando passou a ser professora sênior na universidade, Assunção, como ele a chama, permanece mais tempo na propriedade rural.
A exemplo de Pedro, Assunção continua ativa com as pesquisas acadêmicas, ainda que em ritmo menor do que no passado, e passou a prestar consultoria climática a empresas. “A diferença agora é que eu tenho de dividir a sala com ele”, brinca Assunção, que não tem mais um espaço fixo no IAG. Ambos orientam alunos na pós-graduação e tocam as pesquisas que os tornaram conhecidos entre seus pares daqui e do exterior. Pedro é especialista em modelagem climática nos trópicos e Assunção estuda a interação do clima, em especial da chuva, com a floresta amazônica e as queimadas.
Os dois, que têm a mesma idade, fizeram praticamente toda a carreira acadêmica na USP, onde exerceram cargos de direção em sua unidade. Também passaram temporadas fora da universidade paulista, no exterior e em outras instituições de pesquisa do país. Entre 1988 e 1990, ele chefiou o então recém-criado Centro de Previsão de Tempo e Estudos Climáticos do Instituto Nacional de Pesquisas Espaciais (CPTEC-Inpe). De 2007 a 2015, dirigiu o Laboratório Nacional de Computação Científica (LNCC). Assunção também coordenou o CPTEC, por seis anos, de 2003 a 2009.
Nesta entrevista, concedida na sala número 350 do bloco principal do IAG, agora às vezes compartilhada por ambos, Pedro e Assunção contam sua trajetória comum, falam de suas pesquisas e comentam o cenário das mudanças climáticas.

Vocês fizeram a graduação em matemática na USP juntos. Já se conheciam antes da universidade?
Pedro: Já, desde os 15 anos. Mas não namorávamos.
Assunção: Antes da USP, estudamos juntos no Colégio Bandeirantes, em São Paulo. Éramos da mesma classe, na qual havia 50 alunos, só cinco meninas
Como foram se reencontrar na USP?
A: Em 1971, o Pedro entrou na Escola Politécnica [Poli] e eu no Instituto de Física. Em seguida, ele mudou para o curso de matemática aplicada. Um ano depois fiz o mesmo.
P: Quando entrei na Poli, já achava que não ia fazer engenharia. Queria fazer alguma coisa ligada às ciências da Terra e meteorologia já estava na lista. Mas naquela época só havia graduação em geologia. Excluí esse curso porque a matemática e a computação não eram então fundamentais no ensino da geologia.
Por que não optaram logo de início por fazer a graduação em matemática?
A: Inicialmente, o curso era só de matemática pura, não havia a parte aplicada, que era o que queríamos.
P: Meu pai [o matemático Candido Lima da Silva Dias (1913-1998), primeiro diretor do Instituto de Matemática e Estatística da USP] dizia que a universidade teria logo um curso de matemática aplicada. Mas eu não podia ficar esperando isso acontecer. Optei pela Poli, de onde poderia me transferir para outro curso de exatas. Já no final do primeiro ano, vi que a engenharia não era para mim. Por sorte, o curso de matemática aplicada foi aprovado logo depois e ia começar em 1972. Esperei até o fim do primeiro ano e me transferi para a matemática.
A: Queria fazer astronomia. Como ainda não havia esse curso, tinha de fazer física. Um dia vi um cartaz nos corredores do Instituto de Física que oferecia estágios em meteorologia marinha no Instituto Oceanográfico [IO] da USP. Também não estava muito convencida de que era astronomia mesmo o que eu queria. Fui até o Oceanográfico, e me aceitaram no estágio. Contei para o Pedro e acho que no dia seguinte ele foi lá e também conseguiu o estágio. Foi assim que começamos a trabalhar em pesquisa meteorológica, ambos com bolsa de iniciação científica da FAPESP por dois anos.
Não sei se entendi direito. Vocês já tinham se transferido para a matemática, mas faziam estágio no Oceanográfico?
A: Sim. Na matemática aplicada era possível fazer disciplinas optativas em outras unidades da USP. Fizemos as optativas em meteorologia no IAG e a iniciação científica no IO.
Nessa época, já namoravam?
P: Namoramos um ano e nos casamos em fevereiro de 1973, no terceiro ano da faculdade. Em outubro de 1974, o professor Giorgio Giacaglia, que era então diretor do IAG, estava à procura de jovens com vontade de ajudar na montagem de um Departamento de Meteorologia.
A: Ele nos chamou para uma conversa, por indicação dos professores Paulo Marques dos Santos e Paulo Benevides, e nos disse que estava contratando dois meteorologistas americanos e três chineses de Taiwan que trabalhavam nos Estados Unidos e Canadá, mas que também tinha de recrutar brasileiros, pois não podia depender apenas de estrangeiros para conduzir a graduação e a pós. Ele sabia que estávamos nos formando no fim de 1974 e nos fez uma proposta. Podia nos contratar se fizéssemos mes-
trado e doutorado em meteorologia nos Estados Unidos. Nem hesitamos. Na hora, aceitamos o convite.
Ele veio com um pacote fechado para vocês?
P: Sim e explicou por quê. Tínhamos pensado em fazer mestrado no Inpe, onde havia alguns pesquisadores que tinham feito doutorado em meteorologia no exterior, e a pós-graduação em meteorologia do Inpe já existia. Como era difícil conseguir bolsa para o mestrado no exterior, pretendíamos tentar uma bolsa de doutorado no exterior após o mestrado no Inpe. Mas o Giacaglia disse que seria importante para o IAG que tivéssemos uma formação diferenciada. Dizia que a USP precisava ter um pensamento independente. Ele foi muito específico. Disse que tínhamos de ir para os Estados Unidos, não para a França ou a Inglaterra, que seriam outras opções naturais naquela época, pois na Europa a formação na pós-graduação era muito específica, concentrada no tema da tese. Nos Estados Unidos, a formação era mais aberta, o que seria mais útil para nós na volta ao Brasil, onde teríamos de ajudar na constituição do Departamento de Meteorologia da USP.
O Giacaglia também escolheu onde fariam a pós nos Estados Unidos?
P: Isso não. Mas sabíamos que tínhamos de ir para algum centro que trabalhasse com meteorologia tropical, algo não muito comum nos Estados Unidos.
A: Fizemos uma lista de possíveis lugares de interesse e nos candidatamos em quatro programas. Fomos aceitos em três e optamos pela Universidade Estadual do Colorado (CSU), em Fort Collins. O Departamento de Ciências Atmosféricas, criado no início dos anos 1960, tinha vários professores com experiência em um grande experimento meteorológico, com navios oceanográficos e estações na superfície, para explorar a região do Atlântico Equatorial. Isso pesou bastante na nossa escolha. Em maio de 1975, fomos contratados como auxiliares de ensino na USP e em agosto fomos para o Colorado. Foi tudo muito rápido. Nosso primeiro filho – temos três – acabou nascendo lá, em 1977. Concluímos o mestrado no início de 1977 e o doutorado em maio de 1979 e reassumimos as funções no IAG no final desse mês.
Estamos muito aquém do necessário na redução das emissões de gases de efeito estufa, afirma Pedro
O que estudaram nos Estados Unidos?
A: O Pedro sempre olhou mais para a dinâmica da meteorologia de grande escala, que observa o comportamento dos continentes e oceanos. Fui estudar tempestades, chuvas. No mestrado, trabalhei com chuvas na Venezuela. Meu orientador, Alan Betts, tinha um conjunto de dados muito bom sobre esse tema. No doutorado, trabalhei com modelagem de sistemas de chuva nos trópicos. A chuva é um fenômeno fascinante. Numa tempestade severa, ocorrem muitos processos, como ventania, gelo e chuva forte. Melhorar a compreensão da chuva tem um impacto grande na previsão meteorológica, que afeta a vida das pessoas e a economia.

P: Trabalhei com o professor Wayne Schubert, já naquela época muito conhecido por seus estudos em dinâmica da atmosfera tropical. Fiz um trabalho essencialmente teórico sobre a dinâmica da relação entre o vento e a temperatura perto do Equador, tema que até hoje desafia os meteorologistas.
A: Depois que voltamos para o Brasil, convidamos vários ex-professores para visitar o IAG, pois tínhamos a intenção de iniciar pesquisas de campo.
P: Isso criou aqui uma cultura de experimentos de campo para coletar dados e entender o ciclo de vida de fenômenos meteorológicos.
Qual foi o primeiro experimento no Brasil que organizaram?
P: Foi o Radasp, com o radar meteorológico de Bauru e financiamento da FAPESP.
A: Fui com a cara e a coragem. Entrei com o pedido do projeto no começo dos anos 1980 e ele foi aprovado. Quando saiu o recurso financeiro, perguntei para o Alan Betts se ele não poderia passar um mês aqui para me ajudar. E ele veio. Ofereceu um curso de pós-graduação compacto e passou sua vasta experiência para nós.
Como era o experimento?
A: O objetivo geral era estudar o papel das circulações locais, produzidas por topografia, brisa marítima e lagos, na formação da chuva nas regiões monitoradas por radar meteorológico em São Paulo. Montamos equipamentos no solo para registrar a radiação, a temperatura, a umidade, os ventos e outros parâmetros, e soltamos a cada três horas balões
com instrumentos para medir a estrutura vertical da atmosfera. Foi o primeiro conjunto de dados em altitude com alta resolução temporal realizado no Brasil.
Havia alguma discussão sobre mudanças climáticas nos anos 1980, quando vocês estavam começando a carreira?
P: Foi o El Niño de 1983 [até então, a mais forte manifestação desse fenômeno climático no século XX] que provocou um interesse maior sobre essa questão. Seu impacto econômico e social foi fortíssimo no mundo inteiro. Tinha aprendido na pós-graduação o que era a mudança climática. Desde o século XIX, já havia a noção de que o aumento da concentração de dióxido de carbono na atmosfera poderia ter um impacto climático.
A: Não se pode esquecer que o El Niño não é estritamente uma mudança climática, faz parte da variabilidade natural do clima. Desde então, foi criada toda uma estrutura de pesquisa em clima com abrangência global.
P: A questão era distinguir se o que ocorria com o clima era devido ao aumento da concentração de gases de efeito estufa ou a variabilidade natural. A Organização Meteorológica Mundial iniciou esse processo que, com apoio da Organização das Nações Unidas [ONU], levou à criação do IPCC [Painel Intergovernamental sobre Mudanças Climáticas] em 1988. A primeira avaliação das pesquisas sobre o clima saiu em 1990. Participei do segundo relatório, de 1995, e do quarto, de 2007.
A: Participei do quinto, de 2013.
Quais das suas contribuições científicas vocês destacariam?
P: No meu caso, acho que são os trabalhos sobre a questão da dinâmica tropical. Em particular, como a energia associada às chuvas é dispersada na atmosfera, fazendo com que os trópicos influenciem o clima em latitudes mais altas. Também estudo como fenômenos tropicais de pequena escala espacial e alta frequência temporal podem influenciar a formação de sistemas de grande escala. São trabalhos mais teóricos que levaram a explicações sólidas sobre as observações na escala de tempo meteorológico e do clima.
Esses processos são diferentes dos que ocorrem em uma zona temperada?
P: Tem diferenças significativas. É uma linha de pesquisa que começou com o doutoramento na CSU e é de grande aplicação no desenvolvimento de modelos atmosféricos globais. É um tema com interface nos estudos sobre sistemas dinâmicos em matemática. Nos trópicos, o efeito do conjunto das chuvas, não de apenas um ou outro episódio isolado, é muito importante. Esse conhecimento hoje é usado para melhorar os modelos de previsão de tempo nos trópicos. A: Sou mais conhecida pelos estudos sobre interações das chuvas na biosfera da Amazônia. Trabalhei muito na interação do clima com áreas de floresta, de pastagem e com os produtos das queimadas, também como esses elementos alteram os processos meteorológicos e como as tempestades se formam e evoluem no ambiente tropical. A questão da influência da poluição de queimadas sobre o clima ainda tira o sono. Em certas circunstâncias, a poluição parece inibir as chuvas. Em outras, transforma uma nuvem de chuva amazônica, que aparentava ser típica do verão e não muito severa, em um sistema mais preocupante, com ventos fortes, muita chuva e gelo. Na Amazônia, as pedras de gelo são encontradas principalmente na primavera, quando o ar está extremamente poluído pelas queimadas. Não há um consenso sobre esse ponto: é a poluição que causa essas pedras de gelo ou é outro parâmetro meteorológico que leva à sua formação? Precisamos de mais pesquisas para entender esse ponto. Essa linha de pesquisa começou nos anos 1980, se expandiu muito com o LBA [Experimento de Grande Escala da Biosfera-atmosfera na Amazônia que teve início em meados da década de 1990] e alcançou grande exposição internacional. Não sabíamos quase nada sobre esses processos algumas décadas atrás, área de pesquisa na qual há uma expressiva contribuição brasileira.
O LBA foi o primeiro grande experimento de clima na Amazônia com financiamento tripartite, do Brasil, Estados Unidos e Europa.
P: O LBA foi montado com pessoas que já tinham bastante experiência em experimentos de campo nos anos 1980, como eu, Assunção, Carlos Nobre, Paulo Artaxo, Reynaldo Victoria, entre outros. Primeiro fizemos uma reunião só nossa
aqui no Brasil. Depois, chamamos os colegas estrangeiros para um grande encontro em que definimos os objetivos gerais do programa de pesquisa e a forma do relacionamento da equipe brasileira com os grupos do exterior. Tínhamos ficado com um gostinho amargo na boca em experimentos anteriores com intensa participação estrangeira em que ocorreram parcerias mal resolvidas. Em alguns experimentos a participação brasileira foi inexpressiva do ponto vista da geração de novos conhecimentos e pouca ciência foi feita em colaboração.
A: O LBA foi criado com outra ideia. Fizemos um grande esforço para obter apoio financeiro das agências brasileiras para as atividades no campo e na condução das pesquisas. Foi um sucesso: fomos sempre considerados como parceiros efetivos. Claro que não dá para competir financeiramente com a Nasa [agência espacial norte-americana, que investiu muito no LBA]. Mas, com nosso financiamento, bancamos nossas equipes e podíamos conversar de igual para igual com os estrangeiros.
P: No LBA, desde o início, estipulamos algumas condições para fazer parcerias
com os grupos do exterior. Para o grupo estrangeiro participar, era necessário que houvesse um compromisso com a formação de alunos com bolsas de estudo para que fizessem a pós-graduação com eles.
A: Uma grande quantidade de jovens, principalmente da comunidade amazônica, foi para o exterior fazer doutorado. Cresceram profissionalmente, viraram pesquisadores e hoje estão espalhados pelo país.
Como avaliam o nível da pesquisa atual sobre meteorologia e clima no Brasil?
P: Hoje há gente fazendo pesquisa de alto nível em todo o Brasil. Essa é a principal diferença. Isso não existia 40 anos atrás. Éramos poucos e bastante limitados nas áreas de pesquisa. Nos anos 1970, ficávamos maravilhados com as condições de trabalho nos laboratórios da Universidade Estadual do Colorado quando comparados com os nossos. Hoje não é mais assim.
A: Mas eles ainda têm mais recursos e mais gente.
P: Sim, mas a ciência que nossos colegas fazem aqui hoje não é muito diferente da que eles fazem lá. Uma grande parte dos pesquisadores brasileiros tem projeção internacional.
Nossa previsão do tempo e modelagem climática é hoje do mesmo nível dos melhores centros internacionais?
P: Acho que, 15 ou 20 anos atrás, tínhamos maior destaque internacional na parte operacional. Estávamos no time dos 10 melhores centros de previsão meteorológica do mundo.
Por que ficamos para trás?
A: Tínhamos um computador mais competitivo e equipes trabalhando em temas nos quais também éramos competitivos. Por razões múltiplas, o número de grupos trabalhando com o desenvolvimento da previsão numérica diminuiu. Houve uma pulverização dos recursos humanos especializados e perdeu-se muita gente na área acadêmica.
P: Principalmente para instituições no exterior e para a iniciativa privada.
Nossa modelagem climática está defasada?
P: Antes de tudo, para ser competitivo, teríamos de ter um supercomputador cerca de 50 vezes mais rápido do
Temos hoje a constatação de que as mudanças climáticas já estão ocorrendo, diz Assunção
que o atual do CPTEC. Outra questão é que falta rumo à nossa ciência. Para resolver um problema maior, que tenha impacto na sociedade, é preciso ter foco. Isso é um problema sério no Brasil. Durante meus oito anos como diretor do LNCC, passei por seis ministros de Ciência e Tecnologia, cada um com uma ideia diferente do que a instituição deveria fazer.
A criação em 2012 do Centro Nacional de Monitoramento e Alertas de Desastres Naturais, o Cemaden, praticamente um filhote que saiu do Inpe, não foi algo bom para o país?
A: É importante ter um centro desse tipo. Mas talvez pudesse ter sido criado em coordenação com o Inpe e com órgãos estaduais voltados para desastres naturais.
P: Houve um processo de esvaziamento do CPTEC, que comprometeu sua missão.
A: Por exemplo, a operação de previsão meteorológica foi duplicada.
P: Também dava para fazer um centro mais articulado com iniciativas que já existiam pelo Brasil afora. Grupos de pesquisa de outros estados que faziam um bom trabalho, como em Santa Catarina, ficaram com a sensação de que seus esforços foram vistos como de pouca valia. Hoje não há no CPTEC o número necessário de pessoas para incorporar os avanços na modelagem climática. Há dois anos, visando reverter essa situação, começou um programa institucional do Inpe, com o apoio do MCTI [Ministério da Ciência, Tecnologia e Inovação], para o desenvolvimento do novo modelo comunitário brasileiro do sistema terrestre, o Monan.
A: Monan quer dizer Model for Ocean-laNd-Atmosphere predictioN [Modelo para Previsão dos Oceanos, Superfícies Terrestres e Atmosfera].
P: O Monan tem um coordenador do Inpe, o Saulo Ribeiro de Freitas, e um coordenador externo, que sou eu. Ele reúne mais de 50 pesquisadores no Brasil. Em tupi, Monan é o nome da entidade que criou o mundo, os céus e os seres vivos. No Brasil, a competência hoje está dispersa em várias universidades, cada uma com sua missão. Precisamos que todos trabalhem para atender uma demanda nacional. No caso, ter uma capacidade preditiva de alta qualidade.
Ainda é possível reduzir as emissões de gases de efeito estufa para que o aquecimento global não ultrapasse 1,5 ºC, como é o objetivo do Acordo de Paris?
A: Uma mudança significativa no padrão das emissões já teria de estar ocorrendo agora. A resposta do clima é lenta. Não é cortar as emissões e o aquecimento termina imediatamente.
P: Tenho a impressão de que as ações necessárias só vão ser tomadas quando a “dor no bolso” for insuportável. É claro que houve algum progresso com uma série de acordos internacionais, como o de Kyoto e o de Paris. Mas ainda estamos muito aquém do necessário com relação aos compromissos de redução na emissão de gases de efeito estufa em todo o mundo.
A: A ciência avançou muito e temos hoje a constatação de que as mudanças climáticas já estão ocorrendo. Mas a sociedade enfrenta dilemas incríveis, como balancear o impacto ambiental com a economia. Nunca se discutiu tanto esse tema como hoje.
Há evidências de que ciclones extratropicais, como esse recentemente que atingiu o Rio Grande do Sul, estão se tornando mais frequentes ou fortes no Brasil?
P: O IPCC sinaliza que, com as mudanças climáticas, há uma tendência de aumento na frequência de furacões e tufões mais intensos. Costumo contar uma história sobre por que os ciclones se formam nas minhas aulas sobre o tema. Os ciclones estabilizam a atmosfera do ponto de vista termodinâmico, transportando calor de baixo para cima, evitando o aquecimento exagerado na superfície. As nuvens convectivas, aquelas de grande desenvolvimento vertical que se formam em dias muito quentes, também atuam nesse sentido. O aquecimento global produzido pelo aumento da concentração de gases de efeito estufa tem impacto contrário: tende a desestabilizar a atmosfera, aquecendo embaixo, perto da superfície, e esfriando mais acima. Então, para estabilizar a temperatura em um planeta mais quente, a atmosfera tem de “tomar uma decisão”: ou produz mais nuvens convectivas isoladas ou organiza sistemas ciclônicos mais intensos para resolver o problema causado pela instabilidade termodinâmica. Do ponto de vista prático, se os ventos forem favoráveis, é mais eficiente produzir ciclones intensos do que nuvens isoladas. Esses ciclones resolvem mais rapidamente o problema da instabilidade termodinâmica. A atmosfera “toma decisões” em razão das leis de conservação que controlam os movimentos do ar, em particular da lei de conservação de energia termodinâmica.
Vocês falam muito de clima e meteorologia também em casa?
P: A partir do momento em que entramos na universidade estudávamos juntos. Sempre trocamos ideias sobre ciência e ensino. Às vezes nossos filhos pediam para pararmos de falar de trabalho.
A: Creio que o fato de trocarmos ideias sobre questões relacionadas com pesquisa foi uma vantagem para nós dois. Para mim, uma fase da vida muito difícil foi quando os filhos eram pequenos. Conciliar o trabalho e a criação deles não foi fácil. Cheguei a pensar em diminuir meu regime de trabalho na universidade, mas o Pedro argumentou que era uma fase, que iria passar. Acabei não fazendo essa mudança. n
O IPCC sinaliza uma tendência de aumento na frequência de furacões mais intensos, comenta Pedro
Seis iniciativas do Ministério da Ciência, Tecnologia e Inovação (MCTI) foram incluídas no Novo PAC, o Programa de Aceleração do Crescimento, anunciado pelo governo federal em agosto. Os investimentos previstos são de R$ 7,9 bilhões até o final de 2026. A maior parte dos recursos, em um total de R$ 4,4 bilhões, está vinculada ao Pró-infra, programa que existe há duas décadas e busca atualizar e ampliar a infraestrutura de pesquisa em universidades e institutos de ciência e tecnologia – a expectativa é lançar editais ao longo dos próximos anos para modernizar laboratórios e estimular a construção de instalações onde há poucas, como o Norte, o Nordeste e o Centro-Oeste.
Projetos de grande porte também estão contemplados. Há R$ 1 bilhão previsto para o Orion, um conjunto de laboratórios de biossegurança em Campinas, no interior paulista, que inclui
 Maurício Oliveira
Maurício Oliveira
Representação gráfica dos laboratórios de biossegurança ligados ao acelerador Sirius, em Campinas (à esq.), e do Reator Multipropósito Brasileiro, em Iperó: investimentos para lidar com microrganismos letais e fabricar radiofármacos
a primeira instalação de contenção máxima no Brasil, própria para manipular microrganismos altamente patogênicos e letais. Uma peculiaridade desse projeto é que está prevista sua conexão com o Sirius, o laboratório de luz síncrotron de quarta geração que começou a operar em 2020 e é a maior e mais complexa infraestrutura científica já construída no país. Ambas as instalações pertencem ao Centro Nacional de Pesquisa em Energia e Materiais (CNPEM), organização social financiada pelo MCTI que também dispõe de unidades de pesquisa em nanotecnologia, biologia e combustíveis renováveis. Com a integração, o Orion usará três linhas de luz síncrotron e será capaz de analisar a estrutura de amostras manipuladas no laboratório. Outro investimento previsto é a segunda fase do Sirius. A ideia é destinar R$ 800 milhões para a construção de mais 10 linhas de luz síncrotron – hoje, há 14 fontes funcionando ou em implantação. Uma dotação de R$ 1 bilhão está prometida para o Reator Multipropósito Brasileiro (RMB), que tem como objetivo a produção de radioisótopos a serem usados na medicina e na indústria. O projeto, idealizado em 2008, não foi adiante por falta de recursos. Já as Infovias RNP (Rede Nacional de Ensino e Pesquisa) deverão receber R$ 640 milhões. Esse projeto prevê a ampliação de redes de fibras ópticas de longa distância para levar internet de alta velocidade a universidades e instituições de pesquisa em localidades do interior do Brasil. Completando o pacote, o Centro Nacional de Monitoramento e Alertas de Desastres Naturais (Cemaden), responsável pela prevenção e pelos alertas de risco de catástrofes naturais, receberá R$ 50 milhões. Os recursos se destinam à instalação de equipamentos e buscam

ampliar de 1.038 para cerca de 1.800 o número de municípios acompanhados pelo Centro nos próximos quatro anos.
“A inclusão desses projetos no PAC ressalta a importância da área de ciência, tecnologia e inovação na promoção de um novo ciclo de desenvolvimento do país e facilita o acompanhamento das iniciativas pela sociedade”, avalia o secretário-executivo do MCTI, Luis Fernandes. Os investimentos têm como lastro a intenção do governo federal de executar os recursos do Fundo Nacional de Desenvolvimento Científico e Tecnológico (FNDCT), principal fonte de financiamento federal para pesquisa que, desde 2016, vinha sofrendo contingenciamentos de recursos sucessivos e vultosos. Uma lei aprovada em abril liberou R$ 4,18 bilhões do FNDCT que haviam sido bloqueados quando o orçamento de 2023 foi votado. Com isso, o montante disponível em 2023 atingiu R$ 9,96 bilhões. Mas a capacidade de manter um fluxo estável de recursos nos próximos anos ganhou um grau de incerteza depois da aprovação no Congresso do Regime Fiscal Sustentável, conhecido como arcabouço fiscal, que prevê a possibilidade de bloquear recursos do FNDCT caso o governo não consiga controlar seu endividamento.
No passado, a inconstância no financiamento federal da ciência criou embaraços para realizar ou concluir grandes projetos de infraestrutura. O RMB é um exemplo recente. Seu objetivo é garantir autonomia na produção de radioisótopos, usados principalmente na fabricação de fármacos para diagnóstico e tratamento de várias doenças, mas com aplicações em energia, indústria, materiais e combustíveis nucleares, agricultura e meio ambiente. “O objetivo do RMB é tirar o Brasil da condição de importador de radioisóto-
Sala de situação do Centro Nacional de Monitoramento e Alertas de Desastres Naturais (Cemaden): ampliação do número de municípios cobertos

pos e transformá-lo em exportador”, diz Patrícia Pagetti, pesquisadora do Instituto de Pesquisas Energéticas e Nucleares (Ipen) e coordenadora técnica do projeto. O cronograma inicial previa sua conclusão em 2014, mas até hoje ele é um canteiro de obras em uma área de 2 milhões de metros quadrados em Iperó (SP). O projeto já consumiu R$ 285 milhões, entre projetos arquitetônicos e de engenharia e algumas obras. Ainda será necessário investir R$ 2,5 bilhões na construção – o valor previsto no PAC, de R$ 1 bilhão, assegura a retomada, mas não é suficiente para concluí-lo.
Nos últimos cinco anos, a iniciativa esteve abandonada. Em 2021, não houve recursos no orçamento federal para importar radiofármacos, que chegaram a faltar nos hospitais (ver Pesquisa FAPESP nº 309). Se houver dinheiro suficiente, o RMB deve ficar pronto em 2029, com vida útil prevista de 50 anos. Há quatro reatores nucleares de pesquisa dedicados a atividades diversas no Brasil – dois em São Paulo, um no Rio de Janeiro e um em Minas Gerais –, mas são estruturas antigas e de desempenho limitado. O RMB será um reator de 30 megawatts, seis vezes mais do que o reator mais potente existente hoje no Brasil.
A demora na conclusão de uma grande instalação de pesquisa traz prejuízos que vão além de sua indisponibilidade por um tempo maior que o previsto. Quando foi projetado, há cerca de 10 anos, o Sirius teria como competidor apenas uma instalação semelhante na Suécia, garantindo à comunidade científica nacional em análise de materiais a chance de produzir estudos que pouca gente no mundo seria capaz de fazer. Hoje,
as instalações são ainda bastante competitivas, mas já enfrentam a concorrência de outros países com fontes semelhantes, como a França e, em breve, a China.
A luz síncrotron é um tipo de radiação eletromagnética de amplo espectro – desde a luz infravermelha, passando pela radiação ultravioleta e chegando aos raios X –, que é produzida quando partículas carregadas, aceleradas a velocidades próximas à velocidade da luz em um túnel, têm sua trajetória desviada por ímãs superpotentes. A luz síncrotron canalizada para estações de pesquisa é capaz de penetrar a matéria e revelar características de sua estrutura molecular e atômica.
O Sirius foi projetado para receber até 38 linhas de luz dedicadas a diferentes técnicas e aplicações. Por enquanto dispõe de 14 linhas previstas na fase 1, que estarão em operação plena em 2025. As verbas previstas no PAC serão destinadas à construção de mais 10 linhas, além das três destinadas ao Orion, com conclusão programada para o final de 2027. “Essa ampliação resultará na maior capacidade de investigação dos mais diversos materiais, em diferentes escalas de espaço e de tempo”, diz Antônio José Roque da Silva, diretor-geral do CNPEM. “Para entender como o cérebro funciona, por exemplo, essa diversidade de escalas é essencial.” Roque vai dar início ao planejamento mais efetivo da terceira e última fase do projeto.
A iniciativa científica mais ambiciosa prevista no PAC é mesmo o Orion – e não há como dissociar sua concepção da experiência recente da pandemia. Trata-se de um complexo de laboratórios de biossegurança que inclui um laboratório NB4, categoria que permite a manipulação de vírus de alta patogenicidade e mortalidade para os quais não há remédios nem vacinas.
O único vírus dessa categoria identificado até hoje no Brasil é o sabiá (SABV), que causa a febre hemorrágica brasileira. A doença foi diagnosticada em humanos pela primeira vez na década de 1990 e, após quase 20 anos sem registro, teve dois casos identificados em 2019. Pesquisas que exigem a manipulação desse patógeno não podem ser feitas em território brasileiro por falta de infraestrutura adequada. Há 60 laboratórios desses no mundo, mas nenhum até agora na América do Sul. A existência de uma instalação de biossegurança máxima vai
oferecer condições para isolar e monitorar agentes biológicos e auxiliar no desenvolvimento de métodos de diagnóstico, vacinas e terapias. Já a conexão com as três linhas de luz síncrotron permitirá analisar a estrutura de células, tecidos e fazer tomografia de pequenos animais contaminados por patógenos.
Os R$ 4,4 bilhões destinados ao Pró-infra, programa operado pela Financiadora de Estudos e Projetos (Finep), têm o objetivo de expandir e tornar competitiva a rede de milhares de laboratórios de universidades e instituições de pesquisa. Fernandes, do MCTI, diz que os critérios para a distribuição dos recursos e lançamento dos editais ainda estão sendo definidos. Ele adianta que os investimentos levarão em conta, além da necessidade de modernizar a infraestrutura, critérios como a descentralização da atividade científica no território nacional. Parcerias com as fundações estaduais de amparo à pesquisa terão contrapartidas federais de quatro para um na região Norte e de três para um no Nordeste e no Centro-Oeste. Já no Sul e no Sudeste, serão mais equilibradas. Outra meta é estreitar as relações com a iniciativa privada, para que aumente a participação das empresas nos investimentos em ciência, tecnologia e inovação feitos no Brasil. “Países que deram saltos de inovação têm 20% de investimentos públicos e 80% de privados. Aqui no Brasil ainda estamos meio a meio”, afirma Fernandes.
Os recursos para as iniciativas do MCTI são uma parcela pequena –pouco mais de 0,5% – do montante envolvido no Novo PAC, que prevê desembolsos públicos e privados da ordem de R$ 1,78 trilhão. “No caso dos projetos em ciência e tecnologia, o PAC deve ser olhado como uma tentativa de organizar investimentos e de estabelecer prioridades”, diz a economista Fernanda De Negri, do Instituto de Pesquisa Econômica Aplicada (Ipea). Para ela, a mescla de grandes instalações para múltiplos usuários e infraestrutura básica atualizada busca atender necessidades imediatas e de médio prazo da comunidade científica. D e Negri ressalta a importância dos projetos de grande porte para dar escala e maior competitividade à produção científica brasileira, mas também aponta a necessidade de atualizar e modernizar uma série de laboratórios e instalações de pesquisa que ficaram sem investimento nos últimos anos e que respondem por parte significativa da produção científica do país. “Os laboratórios menores sustentam a produção científica brasileira. Certamente não seria o caso de decidir, de uma hora para outra, que os investimentos irão apenas para os grandes projetos.” Ela adverte, contudo, que será
preciso prover recursos no longo prazo para que o país possa lidar com desafios de pesquisa em temas como mudança climática e transição energética. “Só assim o Brasil conseguirá criar escala para fomentar pesquisas de alto nível”, diz.
O programa Infovias RNP tem como estratégia ampliar a abrangência e a segurança da conectividade para educação e pesquisa, expandindo-a em todas as regiões do país. Os investimentos são destinados a implantar 18 novas infovias estaduais, oito regionais e duas nacionais. A infraestrutura óptica será compartilhada entre as organizações de educação e pesquisa usuárias do Sistema RNP e a rede do governo estadual parceiro. Essas iniciativas somarão mais de 40 mil quilômetros de fibra óptica, com a ambição de atingir 1.328 universidades, institutos e centros de educação, pesquisa e inovação, 180 mil pesquisadores, 3.880 programas de pós-graduação e 12 ambientes de inovação e parques tecnológicos. “Além de fortalecer a pesquisa, vamos avançar na inclusão e na capacitação digital da população brasileira, sobretudo nas regiões mais remotas do país”, afirma o diretor de Relações Institucionais da RNP, Gorgonio Araújo. “O objetivo é ir cada vez mais para o interior, para que as condições de pesquisa, de acesso à internet e de tráfego de dados sejam as mesmas para quem está nos grandes centros e em qualquer outro lugar do país”, diz Araújo.
Os R$ 50 milhões destinados ao Cemaden, unidade de pesquisa vinculada ao MCTI, buscam ampliar o alcance geográfico de alertas produzidos pela instituição sobre o risco de deslizamento de encostas, enxurradas, inundações e secas – e que apoiam o trabalho da Defesa Civil. Ainda não foram definidos os municípios que serão incluídos, mas se projeta que a população atendida passará de 55,7% para aproximadamente 70% do país. “Parte do dinheiro será aplicada também na modernização do nosso parque de Tecnologia da Informação, que foi concebido em 2011 e precisa ser atualizado”, conclui a diretora do Cemaden, Regina Alvalá. n

Traçados de projetos de infovias no Pará, em Goiás e na Bahia: R$ 640 milhões para levar internet de alta velocidade a instituições de pesquisa do interior


Em sua sétima edição, competição de conhecimentos da USP exclusiva para alunos da rede estadual de ensino tem recorde de inscritos e procura aproximar jovens da graduação
Sarah Schmidt
Aestudante Marcela Amanda Tonelli, de 18 anos, tinha o desejo de cursar a graduação em física quando iniciou o primeiro ano do ensino médio em uma escola pública do município de São Carlos, interior paulista. Naquele mesmo ano, em 2021, por incentivo dos professores, inscreveu-se e participou da Competição de Conhecimentos e Oportunidades da Universidade de São Paulo (USP), a Cuco. A prova on-line com 18 questões, distribuídas entre ciências da natureza, ciências humanas, matemática e linguagens, foi sua primeira aproximação com um exame nos moldes do vestibular e ela pôde testar seus conhecimentos e o controle do nervosismo com duas horas cronometradas para responder a tudo.

Com o melhor desempenho de sua sala, ganhou uma bolsa de pré-iniciação científica no campus da USP na cidade, com direito a aulas semanais sobre física e desenvolvimento de um
projeto de pesquisa. Em 2022, pulou uma série e foi direto para o terceiro ano. Competiu novamente e ganhou acesso a cursos remotos para se preparar para o vestibular. “Descobri que as universidades públicas têm reservas de vagas para egressos do ensino público, o que me fez sentir mais confiante”, diz ela, que foi aprovada no bacharelado em física na Universidade Federal de São Carlos (UFSCar) e no Instituto de Física (IFSC) da USP e optou por este último, onde ingressou em 2023.
Tonelli faz parte dos 4.492 estudantes da rede estadual paulista que já participaram da Cuco e conseguiram ingressar em algum dos campi na universidade paulista ao longo dos últimos seis anos – cerca de 55% são mulheres. Em sua sétima edição, realizada em agosto, a competição gratuita exclusiva para alunos do ensino médio público bateu seu recorde: foram 141.254 inscritos – ante 18 mil da primeira edição – de 3.012 colégios distribuídos por 605 municípios.
Ao todo, 117.651 alunos efetivamente fizeram a prova e 15.888 foram premia dos com certificados e cursos on-line de formação complementar para se prepararem para o vestibular, com direito a tirar dúvidas em fóruns de discussão com estudantes de graduação da USP. Algumas escolas também devem organizar visitas aos campi da universidade paulista e as 15 que tiveram maior adesão de alunos à Cuco receberão palestras sobre curiosidades da USP e um show de física com demonstrações de experimentos.
“Apesar do nome do programa, o obje tivo final não é promover uma disputa, mas estimular o processo formativo dos alunos, aproximá-los da universidade públi ca e mostrar que ela é um lugar para eles”, afir ma o físico e educador Herbert Alexandre João, do IFSC-USP, coordenador-executivo da Cuco.
Uma ação de extensão universitária do programa Vem Saber, vinculado ao IFSC, a competição nasceu para ampliar o acesso de estudantes do ensino médio público ao ensino superior público. Foi criada em resposta à política de cotas para alunos de escolas públicas da USP, aprovada em 2017 para ingresso em 2018, que paulatinamente aumentou de 37% para os atuais 50% de vagas reservadas na graduação, 37,5% delas destinadas a candidatos autodeclarados pretos, pardos e indígenas (PPI). “Não basta que as vagas sejam criadas, os alunos precisam saber que têm esse direito. Ninguém escolhe o que não sabe que existe”, observa o físico.
Nas edições anteriores, apenas um aluno de cada sala era premiado. Neste ano, a pedido dos próprios estudantes e dos professores, os três melhores de cada turma passaram a ser classificados com certificados de nível ouro, prata e bronze.
Um dos prêmios que os alunos recebem é o acesso a cursos complementares oferecidos pela USP, mas a iniciativa não pretende ser um cursinho pré-vestibular popular, modelo que há décadas se dedica a preparar jovens com vulnerabilidades socioeconômicas para os vestibulares. No IFSC, os membros da equipe da Cuco costumam indicar esses cursinhos para competidores da cidade de São Carlos. “Nosso trabalho é oferecer uma formação complementar”, afirma o físico Antonio Carlos Hernandes, do IFSC, idealizador da Cuco, que foi pró-reitor de Graduação da USP quando a reserva de vagas foi implementada.
Como o foco é o processo de aprendizagem, os alunos são classificados dentro de sua série e de sua escola. “Cada escola tem a sua realidade e
dessa maneira os alunos concorrem com as mesmas condições educacionais”, observa Hernandes, que organizou um livro sobre a experiência da Cuco, lançado neste ano. “O intuito desse sistema é incentivar os alunos e mantê-los motivados”, complementa. Após a realização da prova, formulada com questões específicas para cada ano com base no conteúdo curricular, a comissão avaliadora define uma nota de corte calculada a partir de uma média de desempenho estadual.
Hyan Tuzi, de 20 anos, conta que se sentia desanimado com os estudos quando cursava o terceiro ano do ensino médio público no município de Penápolis, em 2021, em meio à pandemia de Covid-19. Ele cogitou fazer o vesti bular, ainda sem muitas certezas, e chegou a pedir isenção da ta xa da Fuvest, mas se esqueceu de anexar um documento e teve seu pedido negado. “Foi quando lembrei que a coordenadora da escola havia comentado que quem fosse premiado na Cuco daquele ano teria isenção da taxa da Fuvest. Decidi participar”, recorda-se. Ficou bem colocado, ganhou a isenção e usou os cursos on-line a que também teve acesso para se preparar em casa para o vestibu lar. Interessado em ciências exatas, em 2022 ingressou na USP no bacharelado em matemá 3

Após participar da competição, Geovânio Monteiro, de 20 anos, passou em vestibulares na USP em 2022 e 2023
Hyan Tuzi foi premiado com isenção da taxa da Fuvest e, em 2022, ingressou na USP no bacharelado em matemática aplicada e computacional

tica aplicada e computacional. Em 2023, os alunos premiados não terão direito a essa isenção porque a parceria com a Fuvest foi interrompida.
A prova on-line da Cuco é apenas uma das etapas, segundo Hernandes. Desde o cadastro no site, passando pela inscrição, pelo teste em si e depois pelo acesso aos conteúdos criados para os alunos, tudo foi planejado para que eles conheçam os caminhos que precisarão percorrer quando se inscreverem nos processos seletivos das universidades.
Neste ano, com a implementação de uma plataforma própria – anteriormente o programa ficava hospedado no site da Fuvest –, 106 professores colaboradores distribuídos em 91 diretorias de ensino do estado terão acesso ao desempenho das classes participantes. A ideia é que eles levem essas informações para diretores e coordenadores pedagógicos, que podem avaliar quais são os conteúdos que precisam de reforço em sua instituição. “Nós somos apenas os organizadores. Tudo realmente acontece graças à mobilização dos professores e das diretorias”, afirma Hernandes. A equipe costuma visitar escolas ao longo do ano para entender suas demandas.
Patrícia Chade, coordenadora de ciências e biologia da diretoria de ensino da cidade de Araçatuba, no interior paulista, e especialista no currículo das duas disciplinas, é uma das professoras colaboradoras da iniciativa. Ela costuma incentivar a participação de docentes e estudantes em
Estudantes que fizeram parte da competição em 2019, quando ela tinha uma fase presencial

projetos que estimulem os jovens a considerarem uma carreira na universidade – entre eles, a Cuco. “Logo que o prazo das inscrições para a competição é divulgado, mando mensagens para os coordenadores e professores em grupos de WhatsApp. Monitoro as inscrições das escolas pela plataforma on-line e incentivo as que estão mais devagar”, diz ela. “Os professores relatam que, como os alunos estão prestando uma prova da USP, muitos perdem o medo do vestibular e se sentem mais encorajados.”

Também há a figura do professor incentivador – neste ano, foram 5.131 cadastrados. Pela primeira vez, 91 deles foram premiados, entre os mais votados pelos alunos, com bolsas integrais de cursos de 18 meses do MBA USP/Esalq. A professora de biologia Isabela Garcia, da Escola Estadual José Augusto Lopes Borges, de Araçatuba, foi uma das premiadas e pretende fazer o curso de gestão escolar. Além das aulas de biologia, ela é responsável pela disciplina Projeto de Vida, em que os alunos de nível fundamental e médio direcionam seus objetivos para uma carreira. Ela usa essas aulas para estimular a discussão sobre o acesso às universidades públicas e divulgar competições de conhecimento.
Uma das alunas que receberam incentivo de Garcia foi Laura Sutil da Silva, de 17 anos, que está no terceiro ano do ensino médio, gabaritou a prova da Cuco deste ano e levou certificado de nível ouro. “Eu não acreditava muito em mim, não me achava tão capaz. Mas, depois de ver meu bom desempenho neste ano, passei a confiar mais na minha capacidade para tentar uma vaga em universidades federais e estaduais”, conta ela, que está em dúvida entre prestar vestibular para física ou zoologia.
No campus da USP em Pirassununga, alunos receberam certificado de participação na Cuco
Isabela Garcia afirma que a participação na Cuco também poderá ajudar os estudantes a se prepararem para o Vestibular Paulista Seriado, conhecido como Provão Paulista, que começará a ser aplicado já neste ano – as notas dos alunos do terceiro ano serão consideradas para ingresso em 2024. Já no ano que vem, será utilizada a nota acumulada das provas feitas na 2ª e 3ª séries do ensino médio. E em 2025 serão consideradas as avaliações nas três séries. Segundo a Secretaria Estadual de Educação, haverá cerca de 13 mil vagas distribuídas em cursos superiores nas três universidades paulistas – USP, Universidade Estadual de Campinas (Unicamp) e Universidade Estadual Paulista (Unesp) –, na Universidade Virtual do Estado de São Paulo (Univesp) e nas Faculdades de Tecnologia (Fatecs) do Centro Paula Souza. “A prova da Cuco é uma prévia, porque aborda conhecimentos gerais e pode servir de termômetro para que os alunos avaliem as áreas que precisam estudar mais”, observa Garcia.
Os anos de experiência com a competição permitiram aos organizadores mapear o que chamam de “entraves invisíveis” enfrentados pelos alunos antes do vestibular. Ainda em 2017, quando o projeto começou, uma das dificuldades era a falta de documentos exigidos para fazer sua inscrição, como ter um número do Cadastro de Pessoas Físicas (CPF). “Levamos essa informação para a Secretaria de Educação, que passou a orientar os alunos a tirar logo o CPF. Hoje já se tornou algo raro de aparecer”, relata Hernandes.
Alunos e professores também se confundem na hora de preencher o questionário socioeconômico para requisitar auxílios estudantis oferecidos pelas
universidades ou a isenção da taxa do vestibular. “Muitos acham que se trata do rendimento mensal da família e não o valor per capita. Um aluno cuja família é composta por cinco pessoas com renda mensal de cerca de R$ 8 mil [menos de 1,5 salário mínimo por pessoa] tem direito a requisitar certos auxílios e muitas vezes ele não se dá conta disso”, observa Herbert.
Neste ano, apesar de a Cuco ter recebido cerca de 180 mil cadastros em seu site, processo no qual o aluno cria um nome de usuário e uma senha, cerca de 40 mil estudantes não se inscreveram para a prova, que é uma segunda etapa. “Muitos pensaram que com o cadastro já estavam inscritos. O mesmo pode ocorrer quando estiverem se inscrevendo para o vestibular da Fuvest, porque o processo é o mesmo”, explica o coordenador-executivo do projeto. “Parecem detalhes pequenos, mas podem fazer a diferença entre ingressar na universidade ou perder um ano de estudos. A cada edição levamos essas dificuldades que notamos para as diretorias de ensino”, completa.
De acordo com as professoras entrevistadas nesta reportagem, outro receio recorrente dos jovens em sala de aula é o de não ter como se manter em uma nova cidade, caso eles sejam aprovados e precisem se mudar para continuar os estudos. Por isso, um dos prêmios deste ano para os participantes será uma live sobre os programas de permanência da USP.
Por muito tempo, Geovânio Alves Monteiro, de 20 anos, aluno de uma escola estadual do município de Casa Branca, interior paulista, não cogitava fazer vestibular para uma universidade pública. Ele não conhecia a reserva de vagas nem os programas de auxílio. Na época, conciliava o trabalho em um supermercado com os estudos. “O que eu via na minha cidade eram pessoas que estudavam em faculdades privadas da região”, recorda-se. Ele fez as provas da Cuco durante o ensino médio, foi o melhor colocado de sua série no terceiro ano e também ganhou isenção para a Fuvest, o que o motivou a prestar o vestibular.
Em 2021, ele ingressou na licenciatura em ciências exatas no IFSC, mas, no final de 2022, decidiu que queria mudar de área. Prestou todo o processo seletivo novamente e em 2023 iniciou o curso de ciências sociais da Faculdade de Filosofia, Letras e Ciências Humanas (FFLCH). Conseguiu auxílios estudantis para mudar novamente de cidade, dessa vez para São Paulo. “Já comecei a participar de grupos de pesquisa e pretendo conseguir uma bolsa de iniciação científica. Quero ser pesquisador”, vislumbra. n

Relatório de atividades mostra como a FAPESP ampliou o financiamento à pesquisa em 2022 e buscou recuperar prejuízos da pandemia
Fabrício Marques
Fundação de Amparo à Pesquisa do Estado de São Paulo investiu no ano passado R$ 1.182.639.805 no fomento a 20.709 projetos de pesquisa. O desembolso foi 16,7% maior que o de 2021 e o número de projetos contratados no período cresceu 27,8%. As receitas da Fundação totalizaram R$ 2.214.740.885, 24% acima do ano anterior – houve um aumento de 12,6% nas transferências feitas pelo Tesouro paulista, que chegaram a R$ 1.907.892.438, e de 235% de outras fontes, que foram a R$ 306.848.447. O balanço está descrito no Relatório de atividades FAPESP 2022, disponível no site da Fundação – no qual também é possível obter os dados anuais do financiamento da instituição desde 1962, quando a FAPESP iniciou suas atividades.
A receita da Fundação é formada por 1% da arrecadação tributária do estado de São Paulo, transferida mensalmente pelo Tesouro conforme previsto na Constituição paulista, e por recursos de outras fontes, como convênios com instituições e empresas para o financiamento conjunto de pesquisas. Um dos destaques de 2022 foram os investimentos em Pesquisa para o Avanço do Conhecimento – categoria que inclui grandes projetos de pesquisa básica e aplicada, como os Temáticos, Jovens Pesquisadores em Centros Emergentes ou os Centros de Pesquisa, Inovação e Difusão (Cepid) – que representaram 53,5% do desembolso da Fundação. Seus aportes cresceram de R$ 563,6 milhões em 2021 para R$ 633 milhões no ano passado. “Esse é o resultado dos esforços da Fundação para ampliar as oportunidades de fomento para jovens pesquisadores por meio de iniciativas como o Projeto Geração e o Projeto Inicial ou pelo aumento do prazo de duração da Bolsa Jovem Pesquisador, de 48 para 60 meses, além da contratação de 54 novos projetos Temáticos no período”, explicou, na apresentação do relatório, o presidente do Conselho Superior da FAPESP, Marco Antonio Zago.
O investimento em todas as modalidades de bolsas cresceu mais de 20% em relação a 2021 – e a formação de recursos hu-
manos foi responsável por 18% dos dispêndios da Fundação. Na categoria Apoio à Infraestrutura de Pesquisa, o desembolso de R$ 130 milhões correspondeu a 11% do fomento, um ponto percentual acima do patamar de 2021. Isso se deveu à abertura, em 2022, de três chamadas de propostas para aquisição de equipamentos de grande porte multiusuários, com previsão de investimentos de R$ 450 milhões. Em setembro de 2023, um novo edital foi lançado, no valor de R$ 200 milhões, agora para aquisição de equipamentos de pequeno porte.
Em outras linhas, o financiamento permaneceu estável. Foi o caso dos investimentos em Pesquisa para Inovação, que reúne programas como o Pesquisa em Parceria para Inovação Tecnológica (Pite), Pesquisa Inovativa em Pequenas Empresas (Pipe) e Centro de Pesquisa em Engenharia/Centro de Pesquisa Aplicada (CPE/CPA), responsáveis por 8,5% do total, e dos dispêndios na modalidade Pesquisa em Temas Estratégicos, que abrange esforços de pesquisa em temas como biodiversidade, bioenergia, mudanças climáticas, entre outros (7%), assim como o desembolso em Difusão, Mapeamento e Avaliação de Pesquisas (2%).
Se o momento de financiamento ascendente é fruto da recuperação da economia após a pandemia, alguns resquícios da emergência sanitária, que levou ao fechamento temporário de laboratórios e à redução de atividade presencial dos institutos e universidades, permanecem presentes em outros indicadores. A produção científica de pesquisadores do estado de São Paulo caiu de 30,6 mil artigos publicados em 2021 para 25,1 mil em 2022, mas, como houve redução equivalente no Brasil, manteve em 41,9% sua participação no total nacional. Também foi registrada, por exemplo, uma redução de cerca de 40% na submissão de novos projetos à Fundação em relação ao período anterior à chegada da Covid-19.
Para compensar a redução na demanda espontânea por recursos, várias iniciativas vêm buscando aumentar o investimento em projetos de médio e longo prazos de modo a estimular as atividades de pesquisa e inovação do estado.
53,5% Pesquisa para o Avanço do Conhecimento (básica e aplicada)
18% Formação de Recursos Humanos para C&T
11% Apoio à Infraestrutura de Pesquisa
8,5% Pesquisa para Inovação
7% Pesquisa em Temas Estratégicos
2% Difusão, Mapeamento e Avaliação de Pesquisas
A FAPESP desembolsou R$ 1.182.639.805 no fomento a 20.709 projetos de pesquisa em 2022
26,2% Saúde
14,2% Biologia
10,2% Interdisciplinar
10,2% Engenharia
9,3% Ciências Humanas e Sociais
6,4% Química
6,3% Agronomia e Veterinária
5,3% Física
4,4% Ciência e Engenharia da Computação
3,1% Geociências
2,0% Matemática e Estatística
1,1% Astronomia e Ciência Espacial
0,7% Arquitetura e Urbanismo
0,5% Economia e Administração
30 GOVERNO
10.398 EMPRESAS 10.398 Empresas com P&D interno
23 INSTITUIÇÕES SEM
2 Outras instituições de CT&I
Como os dispêndios da FAPESP se distribuíram em 2022
44,7% USP 15,6% Unicamp
No ano passado, a FAPESP anunciou os resultados de chamada que selecionou mais 17 novos Centros de Ciência para o Desenvolvimento (CCD) – além dos 11 já instalados –, constituídos para articular pesquisadores de universidades e institutos estaduais de pesquisa com gestores de órgãos públicos, em projetos orientados à solução de problemas específicos e com relevância social ou econômica para São Paulo. “Temos enormes problemas nas várias secretarias estaduais e essa é uma maneira de ouvirmos os gestores públicos, alinharmos os temas de pesquisa e oferecermos chamadas que abordem problemas que as secretarias têm na gestão de políticas públicas”, explicou o diretor-presidente do Conselho Técnico-Administrativo da FAPESP, Carlos Américo Pacheco, no anúncio das propostas vencedoras. Os novos centros desenvolverão pesquisas em tópicos como biofármacos, inovação em políticas públicas urbanas, inovação tecnológica para emergências em saúde, doenças humanas e animais, aprimoramento de vacinas, entre outros.
Em 2022, três novos CPE/CPA iniciaram suas atividades: o primeiro, voltado para o desenvolvimento de inovação offshore, em parceria com a Shell e sede na Universidade de São Paulo (USP); o segundo, com foco no melhoramento molecular de plantas, junto com a Empresa Brasileira de Pesquisa Agropecuária (Embrapa) e com sede na Universidade Estadual de Campinas (Unicamp); e o terceiro, de pesquisa em imuno-oncologia, em cooperação com a GSK e sediado na Sociedade Beneficente Israelita Albert Einstein. Esse será o terceiro centro constituído pela FAPESP e GSK. Um deles está em operação no Instituto Butantan desde 2015 e investiga alvos moleculares para o tratamento de doenças de base inflamatória. O outro, com sede na Universidade Federal de São Carlos (UFSCar), busca desenvolver produtos e processos químicos sustentáveis na elaboração de novos medicamentos.
9,2% Unesp
5,0% Empresas
3,9% Instituições Particulares de Ensino e Pesquisa
0,2% Sociedades e Associações Científicas
0,1% Instituições Municipais
0,8% Outros
Nos CPE, equipes das empresas desenvolvem colaboração de longo prazo, de cinco a 10 anos, com cientistas de universidades ou institutos de pesquisa. As pesquisas são cofinanciadas em quantias equivalentes pela FAPESP e pela empresa parceira, enquanto a contrapartida das instituições é feita por meio da oferta de infraestrutura e do pagamento de salários a pesquisadores e técnicos. “Na hora em que a FAPESP põe R$ 10 em um centro, a empresa A, B ou C coloca outros R$ 10 ou mais para amplificar os resultados do investimento”, observou o neurocientista Luiz Eugênio Mello, diretor científico da FAPESP em 2022 (ver Pesquisa FAPESP nº 327). “E, para várias áreas em que o recurso de pesquisa e desenvolvimento é incentivado – por exemplo, no setor de óleo de gás –, não fazemos parcerias de um para um, mas de dois para um, de três para um, de quatro para um. E esse dinheiro vai sempre para uma instituição de ciência e tecnologia no estado de São Paulo, servindo tanto para reagentes, equipamentos, como para bolsas.” Outros três CPE foram constituídos em 2022 com início de atividades previsto para 2023. O Smartness, que realizará pesquisa em redes e serviços, será instalado na Unicamp, em parceria com a Ericsson. O Centro de Pesquisa em Engenharia para a Mobilidade Aérea do Futuro (CPE-MAF) reunirá pesquisadores da Embraer e do Instituto Tecnológico
Papers a respeito do novo coronavírus publicados por pesquisadores de São Paulo
de Aeronáutica (ITA). E a Braskem será parceira da Unicamp e de outras instituições em pesquisas sobre o uso da plasticultura no cultivo agrícola.
O programa Pipe, que desde 1997 já apoiou pesquisas em 1.853 micro, pequenas e médias empresas de base tecnológica de 163 municípios paulistas, contratou 578 novos projetos de 224 empresas inovadoras em 2022. Uma parte desses projetos foi selecionada em chamadas feitas em parceria com a Companhia de Saneamento Básico do Estado de São Paulo (Sabesp), com o Serviço Brasileiro de Apoio às Micro e Pequenas Empresas (Sebrae) e com a Financiadora de Estudos e Projetos (Finep). Pela primeira vez, a FAPESP integrou o Programa Centelha, iniciativa do Ministério da Ciência, Tecnologia e Inovação (MCTI) e da Finep, junto com o Conselho Nacional das Fundações Estaduais de Amparo à Pesquisa (Confap) e a Fundação Certi – sigla para Centro de Referência para Tecnologias Inovadoras –, com sede em Florianópolis (SC). O objetivo do programa é apoiar jovens empreendedores interessados em transformar ideias inovadoras em novos negócios.
A Fundação foi também responsável pela articulação nacional da Iniciativa Amazônia +10, uma parceria envolvendo Fundações Estaduais de Amparo à Pesquisa (FAP), sob a liderança do Confap, que tem como propósito estimular pesquisa colaborativa e interdisciplinar com foco no desenvolvimento sustentável da Amazônia. A primeira chamada mobilizou mais de 500 pesquisadores em 20 estados brasileiros. Foram selecionadas 39 propostas de 18 estados e do Distrito Federal, com investimentos das FAP totalizando R$ 41,9 milhões.
Em maio de 2022, uma cerimônia marcou os 60 anos da Fundação, com o anúncio de novos investimentos em pesquisa no total de R$ 990 milhões. As comemorações já haviam começado em 2021 e incluíram a realização de 17 Conferências FAPESP 60 anos, duas Escolas FAPESP 60 anos envolvendo 120 estagiários de pós-doutorado de todo o Brasil, além de duas publicações lançadas em 2022: o livro FAPESP 60 anos: Ciência, cultura e desenvolvimento; e FAPESP 60 anos: A ciência no desenvolvimento nacional, organizado pela Academia de Ciências do Estado de São Paulo (Aciesp). n
Iniciação Científica
Mestrado
Doutorado
Doutorado Direto
Pós-doutorado
Bolsa Estágio de Pesquisa no Exterior (BEPE)
BEPE – Iniciação Científica
BEPE – Mestrado
BEPE – Doutorado
BEPE – Doutorado Direto
BEPE – Pós-doutorado
Bolsa de Pesquisa no Exterior (BPE)
BPE – Pós-doutorado
7.165

Site que publica comentários, na maioria anônimos, sobre o conteúdo de artigos científicos consolida-se como plataforma de denúncia de desvios éticos
Criado há 11 anos como um fórum na internet para discussão do conteúdo de artigos científicos, o site PubPeer consolidou-se como uma vitrine de denúncias de má conduta científica. Sua influência ficou evidente no caso que levou à demissão do reitor da Universidade Stanford, o neurocientista Marc Tessier-Lavigne, em meados de julho. Os primeiros indícios de manipulação de imagens em vários artigos publicados pela equipe do reitor foram apontados em comentários no PubPeer a partir de 2015, e ganharam repercussão depois que um repórter de um jornal estudantil de Stanford compilou-os em uma reportagem no ano passado. Uma investigação feita pela universidade concluiu que o dirigente não participou da manipulação nem teve conhecimento das fraudes antes da publicação dos artigos, mas o fato de ele não ter se empenhado em retratar os artigos assim que soube dos problemas foi criticado pelos investigadores e essa inação selou sua saída. “Concordo que em alguns casos eu deveria ter sido mais diligente ao buscar correções e lamento não ter feito isso”, escreveu Tessier-Lavigne, em sua carta de renúncia.
Quem acompanha a trajetória do PubPeer não se surpreendeu com o desfecho em Stanford. Em 2016, um software capaz de identificar erros estatísticos em
artigos científicos analisou cerca de 50 mil trabalhos publicados em revistas de psicologia e divulgou no PubPeer seus resultados, para constrangimento de milhares de autores. No ano seguinte, a revista Nature revogou um prêmio que havia concedido ao bioquímico espanhol Carlos López-Otín em reconhecimento a seu trabalho como mentor de jovens pesquisadores, depois que nove artigos de seu grupo da Universidade de Oviedo foram retratados por evidências de manipulação de imagens – os indícios foram apresentados no PubPeer. Recentemente, sete artigos de Gregg Semenza, pesquisador da Escola de Medicina Johns Hopkins, nos Estados Unidos, vencedor do Nobel de Medicina ou Fisiologia de 2019, foram retratados por manipulação de imagens – os problemas também vieram à tona na plataforma.
Qualquer artigo publicado em uma revista científica pode ser alvo de comentários no PubPeer. Na prática, a plataforma promove um tipo de escrutínio análogo à revisão por pares após a publicação dos estudos, por meio da qual leitores podem apontar sinais de erros ou de má conduta. Os revisores podem ou não se identificar. Segundo os criadores do site, cerca de 90% das análises postadas são anônimas e o PubPeer não guarda informações sobre esses usuários propositalmente. “Consideramos que é só uma questão de tempo até que informações de usuários vazem de alguma forma. A única proteção certa é nunca saber informações que não desejamos ver expostas”, explicaram os responsáveis, ao anunciarem uma reformulação técnica do site, promovida em 2017.
O caráter incógnito das denúncias já rendeu pelo menos uma grande dor de cabeça jurídica para o PubPeer, mas o site saiu fortalecido. Em 2016, Fazlul Sarkar, oncologista da Universidade Wayne, nos Estados Unidos, que teve 13 artigos retratados por manipulação de imagens, processou o PubPeer e exigiu que fosse revelada a identidade dos indivíduos que apontaram os problemas em seus trabalhos – alegou que estava mudando de emprego na época das denúncias e elas abortaram sua transferência para a Universidade do Mississipi. Um tribunal no estado de Michigan considerou que as denúncias anônimas eram protegidas pela legislação.
Nos primeiros anos do PubPeer, seus próprios criadores também se mantiveram anônimos e a plataforma era cercada por uma aura clandestina. Os fundadores só se revelaram em 2015: o site já ganhara prestígio e eles decidiram que era hora de buscar financiamento para expandir as atividades. O neurocientista norte-americano Brandon Stell, pesquisador da Universidade Paris Descartes, na França, anunciou que era o principal responsável pela iniciativa, realizada com o apoio de dois irmãos, seu ex-aluno Richard Smith e George Smith, que trabalha com desenvolvimento de sites. O neurocientista Boris Barbour, da mesma universidade francesa, e o advogado Gabor Brasnjo, que tem um escritório em São Francisco, nos Estados Unidos, uniram-se também ao time depois que o PubPeer foi criado.
Na época, Stell contou à revista Science que a ideia do PubPeer remontava aos seus tempos de graduação na Universidade do Colorado em Boulder, Estados Unidos, onde frequentava reuniões de pesquisadores e estudantes em que artigos publicados em periódicos eram discutidos e dissecados. Ele se inspirou nessa experiência para criar um clube de discussões virtual, aberto à contribuição de qualquer pessoa, com a ambição de acelerar o processo de correção da ciência. O site cresceu e deu origem à The PubPeer Foundation, sediada na Califórnia, e financiada por uma organização filantrópica mantida pelos bilionários John e Laura Arnold.
Aplataforma pede aos usuários que os comentários postados se atenham a informações concretas e que possam ser verificadas publicamente. Veda expressamente a disseminação de boatos. “Alegações de má conduta são proibidas no PubPeer”, informa o site aos usuários. “De qualquer forma, elas são desnecessárias. O público é composto principalmente por pesquisadores altamente inteligentes. Eles são perfeitamente capazes de tirar suas próprias conclusões se os fatos forem claramente apresentados.”
Não se imagine que todos os comentários postados no site sejam fidedignos. A repórter Denise-Marie Ordway, que trabalha no site The Journalist’s Resource, entrevistou três jornalistas que utilizam o PubPeer como fonte de informação e enumerou recomendações para lidar com as denúncias de forma responsável. A mais importante é compreender que as informações são apenas indícios e é necessário confirmá-las em investigações detalhadas. “Você precisa tratar as postagens anônimas no PubPeer da mesma forma que lidaria com postagens anônimas de qualquer tipo”, disse Charles Piller, um dos entrevistados, que escreve para a revista Science e é um dos fundadores de uma ONG de jornalismo investigativo chamada Center for Public Integrity. O primeiro cuidado que Piller toma é o de submeter as suspeitas levantadas nos comentários a especialistas em integridade científica: “Você não tem como saber de antemão se o denunciante tem alguma motivação oculta”.
Stephanie Lee, repórter da revista eletrônica The Chronicle of Higher Education, diz que recorre à plataforma sempre que vai escrever sobre um pesquisador ou um grupo cujo trabalho interessa a ela. “É o primeiro lugar aonde vou para saber se já foram levantadas questões sobre os cientistas”, explicou. Ela teme, contudo, o estrago que denúncias podem causar à reputação de pesquisadores. “Mostre evidências”, aconselha. “Acho melhor deixar as evidências falarem por si.” Julia Belluz, correspondente do site Vox, ressaltou o papel que o PubPeer cumpre no processo de correção de registros científicos. “Sabemos que a revisão por pares pode não detectar erros ou fraudes em artigos antes de sua publicação. O PubPeer é um lugar onde cientistas denunciam pesquisas problemáticas.” n Fabrício Marques
OComitê de Ética em Publicações (Cope), fórum de editores de revistas científicas sediado no Reino Unido que trata de questões de integridade, lançou um documento com recomendações para enfrentar um crescente foco de má conduta: a proliferação exagerada de números especiais de periódicos. Essas edições são organizadas por editores convidados, não vinculados ao organograma das publicações, costumam tratar de tópicos específicos de pesquisa e são usadas para multiplicar as receitas de editoras. Frequentemente, contudo, são acusadas de publicar conteúdo de baixa qualidade e, em alguns casos, até de perder o controle sobre o processo de revisão por pares, manipulado por fraudadores.
De acordo com o Cope, as práticas de publicação das edições especiais as expõem a riscos, como a ocorrência de fraudes, manipulação de citações, conflitos de interesses financeiros, entre outros problemas. Embora de forma velada, o
documento critica os abusos de editoras que publicam uma quantidade exagerada de edições especiais. “Publicar um grande número de coleções de artigos editados por convidados pode levantar preocupações sobre a independência, imparcialidade e credibilidade da revista. [...] O número das coleções editadas por convidados não deve exceder uma quantidade que possa ser razoavelmente supervisionada pelo editor-chefe, conselho editorial e equipe da redação”, informou o texto apresentado pelo Cope. O documento não menciona casos específicos, mas um dos mais rumorosos envolve a editora MDPI, sediada em Basileia, na Suíça, hoje a quarta maior editora científica do mundo. Em 2023, seus dois principais títulos, Sustainability e International Journal of Molecular Sciences, programaram cada um a publicação de cerca de 3,5 mil edições especiais – nove edições por dia (ver Pesquisa FAPESP nº 327).


A maioria das recomendações funciona como um checklist para que editoras

se cerquem de cuidados na hora de selecionar os editores convidados. Algumas sugestões soam redundantes, como a de que os editores-chefes devem verificar a identidade dos editores e a autenticidade de seus e-mails e telefone, antes de lhes atribuir a responsabilidade de organizar um número especial. É que já houve casos em que esse cuidado não foi tomado. Uma investigação da Universidade Politécnica de Hong Kong (PolyU) descobriu que a conta de e-mail de um de seus alunos de pós-graduação era usada de forma fraudulenta por um pesquisador de outra universidade – ele se apropriava da identidade do estudante para atuar como coordenador de edições especiais de dois periódicos científicos da editora Hindawi e publicar artigos fraudulentos. A Hindawi anunciou a suspensão da publicação de edições especiais depois que a Clarivate Analytics puniu, em abril, 19 revistas da empresa por suspeita de práticas desonestas, cancelando a divulgação de seu fator de impacto.
Um importante centro de pesquisa oncológica da Austrália está às voltas com um caso de má conduta científica. Uma investigação interna concluiu que um estudo sobre melanoma conduzido no Peter MacCallum Cancer Center, em Melbourne, descreveu um experimento que, provavelmente, jamais foi realizado. O artigo, publicado em abril de 2016 no Journal of Clinical Oncology, foi coordenado pelo imunologista Mark Smyth, que trabalhou no centro durante 13 anos. O estudo analisou o caso de uma mulher de 39 anos que teve melanoma com metástase nos ossos. Ela recebeu dois tipos de anticorpos, o ipilimumab e o denosumab, e teve boa recuperação: os tumores regrediram e a dor óssea desapareceu. Para avaliar em detalhes o efeito obtido, a combinação dos anticorpos foi aplicada em camundongos com melanoma e, segundo as conclusões do artigo, também se revelou eficaz. Essa segunda etapa em modelo animal, contudo, não tem sustentação. A nota de retratação do artigo menciona os resultados de uma investigação externa que não encontrou correlação entre o número de roedores alegadamente usados na pesquisa e os registros oficiais de utilização de animais. “No balanço das possibilidades, é improvável que as experiências mostradas tenham sido realmente realizadas”, diz a nota. Enquanto trabalhava na instituição em Melbourne, Smyth recebeu quase 17 milhões de dólares australianos, o equivalente e R$ 54 milhões, em financiamento público para nove projetos de pesquisa. O nome do oncologista esteve ligado recentemente a um outro escândalo no QIMR Berghofer Medical Research Institute, em Brisbane, onde ele foi trabalhar depois que saiu de Melbourne, mas foi demitido no ano passado. Em abril, uma investigação concluiu que ele fabricou dados de pesquisa usados para lastrear pedidos de financiamento e protocolos de ensaios clínicos. Procurado pelo jornal The Sydney Morning Herald, Smyth não quis se pronunciar.
O ano de 2022 marcou 10 anos da aprovação da lei de cotas1 nas instituições federais de ensino superior para estudantes oriundos das redes públicas de ensino médio e para quem se declara de cor preta, parda ou indígena
O processo, iniciado uma década antes, culminou na lei que levou várias instituições de ensino superior, notadamente públicas, a adotarem programas de ação afirmativa com o objetivo de ampliar o acesso de grupos desfavorecidos ao ensino superior
n Indígena
n Amarela
n Parda
n Preta
n Branca
Seus efeitos atingiram todos os sistemas, mas sobretudo o público2, como mostra a mudança da composição dos concluintes3 entre 2011 e 2021 (acima)
POPULAÇÃO DE 25 A 34 ANOS:
TOTAL, POR GRUPO DE COR/RAÇA
No total de concluintes, a participação dos que se declararam de cor/raça preta, parda ou indígena passou de 32% para 45%. No sistema federal, a participação desse grupo passou de 39% para 52% e, no estadual, de 33% para 41%
Os sistemas privados, com ou sem fins lucrativos (CFL e SFL), apesar de não serem contemplados por aquela lei, sentiram efeitos de outros programas federais, como de bolsas (Prouni) e de financiamento (Fies), que, ao levarem em conta a situação econômica dos estudantes, também implicaram a maior inclusão desse grupo populacional
Apesar desses avanços, dados do Ministério da Educação mostram que, em 2023, na população de 25 a 34 anos4, os que se declaram pretos, pardos ou indígenas correspondem a 59% do total5, ou seja, a inclusão ainda não resultou em equilíbrio na representatividade desse grupo entre os concluintes do ensino superior
Além disso, para toda a população nessa faixa etária, 23% possuíam título de nível superior, proporção que chegava a 33% entre os que se declaravam de cor branca e apenas a 16% entre os de cor/raça preta, parda ou indígena, mostrando que ainda é longo o caminho a percorrer nesse campo
NOTAS (1) LEI FEDERAL Nº 12.711/2012 DE 29/08/2012 – HTTPS://WWW.PLANALTO.GOV.BR/CCIVIL_03/_ATO2011-2014/2012/LEI/L12711.HTM (2) O SISTEMA MUNICIPAL TAMBÉM PASSOU POR MUDANÇA SEMELHANTE; FOI DEIXADO FORA DO GRÁFICO POR NÃO SER SIGNIFICATIVO EM NÚMEROS ABSOLUTOS (APENAS 11,5 MIL CONCLUINTES QUE DECLARARAM COR/RAÇA EM 2021) (3) CONCLUINTES QUE DECLARARAM COR/RAÇA (4) A PRIMEIRA FAIXA ETÁRIA CONSIDERADA EM ANÁLISE DA ESCOLARIDADE EM NÍVEL SUPERIOR, NAS COMPARAÇÕES INTERNACIONAIS (5) DADOS DA PNAD CONTÍNUA 2º TRIMESTRE/2023; A MAIOR PARTE DOS CONCLUINTES EM 2021 JÁ SE ENCONTRAVA NESSA FAIXA ETÁRIA, O QUE JUSTIFICA A COMPARAÇÃO
FONTES MICRODADOS DO CENSO DA EDUCAÇÃO SUPERIOR, INEP/MEC; PNAD CONTÍNUA, IBGE. PROCESSAMENTO DA GERÊNCIA DE ESTUDOS E INDICADORES, FAPESP ELABORAÇÃO FAPESP, DPCTA/GERÊNCIA DE ESTUDOS E INDICADORES

Supercondutores expulsam campos magnéticos e provocam o fenômeno da levitação
Atemperatura não para de subir dentro e fora dos laboratórios que procuram por materiais supercondutores, capazes de conduzir eletricidade sem nenhuma perda de energia na forma de calor, ou seja, com resistência zero. Em 8 de março deste ano, uma equipe coordenada pelo físico Ranga Dias, da Universidade de Rochester, nos Estados Unidos, publicou um artigo científico na revista Nature em que relatava a síntese do que seria o primeiro supercondutor à temperatura ambiente. De acordo com o trabalho, o composto de fórmula LuNH – material baseado no lutécio, um metal de cor branca-prateada, misturado com nitrogênio e hidrogênio – apresentaria resistência zero a 294 Kelvin (K), 21 graus Celsius (°C).
O suposto feito, longe de ser comprovado por ora, teria um potencial revolucionário. Todos os supercondutores hoje disponíveis – instalados em aparelhos de ressonância magnética, no interior de grandes aceleradores de partículas e em alguns trens magnéticos de alta velocidade –funcionam apenas quando resfriados, de forma custosa, a temperaturas extremamente baixas, próximas do zero absoluto (0 K). Esses valores equivalem a centenas de graus Celsius negativos.
O parâmetro mais importante de um supercondutor é denominado temperatura crítica (Tc), valor geralmente dado na escala Kelvin abaixo do qual um material apresenta resistência zero à passagem de corrente elétrica. Ou seja, vira um supercondutor elétrico. Outra característica definidora é a capacidade de repelir campos magnéticos, propriedade que pode ser usada para produzir o fenômeno da levitação.
É verdade que, segundo o estudo da Nature, o LuNH precisava ser submetido a uma pressão 10 mil vezes superior à da atmosfera terrestre para atuar como um condutor perfeito de eletricidade. Ainda assim, desde a descoberta da supercondutividade em 1911 no elemento mercúrio a -269 ºC (4,15 K), ninguém tinha pleiteado a existência de um supercondutor com uma Tc tão alta. Ninguém a não ser o próprio Dias em um artigo anterior, publicado em outubro de 2020, também na Nature. No trabalho, ao lado de colegas da Universidade de Nevada e de seu time em Rochester, o físico alegava ter produzido um composto feito de carbono, hidrogênio e enxofre que se tornava supercondutor a 15 ºC se submetido a uma pressão 2,6 milhões de vezes maior do que a da Terra. Passados seis meses de sua divulgação, o composto LuNH exibe fissuras crescentes em sua alegada reputação de supercondutor à temperatura ambiente. “Tenho um ceticismo comedido com esse material. Nesse campo da ciência, o primeiro resultado é provisório enquanto não for confirmado por outros laboratórios”, comenta o físico Wilson Ortiz, coordenador do grupo de supercondutividade e magnetismo da Universidade Federal de São Carlos (UFSCar). Nenhum grupo de pesquisa independente conseguiu reproduzir, em laboratório ou computacionalmente, o experimento que teria indicado sua supercondutividade a 21 °C.
A situação do estudo anterior, de três anos atrás, com o composto feito de carbono, hidrogênio e enxofre, é ainda mais desconfortável. Em setembro do ano passado, a Nature retratou, à revelia de seus autores, o artigo de 2020 publicado em suas páginas pela equipe de Dias. “Depois da publicação [do artigo], questões foram levantadas sobre
Materiais que funcionariam como supercondutores à temperatura ambiente geram debate acalorado e não convencem os críticos
Marcos Pivetta
a maneira com que os dados desse paper foram processados e analisados”, escreveram os editores do periódico em um texto que explicava a decisão.
Para piorar ainda mais a situação, a prestigiada revista Physical Review Letters (PRL) retratou, em agosto de 2023, outro artigo que o grupo de Dias e os colegas de Nevada haviam publicado em uma de suas edições de 2021. O paper anulado não tratava especificamente de supercondutividade, mas das propriedades elétricas do dissulfeto de manganês (MnS2), que podia se comportar ora como isolante, ora como metal.
Quatro equipes independentes de especialistas examinaram o artigo da PRL e expressaram “sérias dúvidas” sobre os dados apresentados em uma figura sobre as curvas de resistência elétrica do material, de acordo com o comunicado emitido pelo periódico quando divulgou a retratação. Todos os 10 autores do paper concordaram com o veredicto da revista, com exceção de Dias, que tem evitado dar entrevistas recentemente sobre seus trabalhos.
Nascido no Sri Lanka, o físico da Universidade de Rochester concluiu o doutorado em 2013 na Universidade Estadual de Washington e fez pós-doutorado na Universidade Harvard antes de ser contratado como professor em 2017 pela Universidade de Rochester. Ao lado do físico Ashkan Salamat, da Universidade de Nevada, um colaborador de muitos de seus estudos, Dias fundou em 2020 a empresa Unearthly Materials, para vender (supostos) supercondutores que funcionariam à temperatura ambiente e a pressões modestas.
“O artigo mais recente da equipe de Ranga Dias não explica direito a composição desse material do sistema LuNH nem o método usado para obtê-lo”, comenta o engenheiro de materiais Luiz Eleno, da Escola de Engenharia de Lorena da Universidade de São Paulo (EEL-USP). Em parceria com pesquisadores das universidades Sapienza de Roma (Itália), de Cambridge (Reino Unido) e Tecnológica de Graz (Áustria), Eleno e o engenheiro físico Pedro Ferreira, que faz doutorado sob sua orientação, publicaram um estudo na Nature Communications em 4 de setembro em que descartam qualquer possibilidade de uma combinação dos elementos lutécio, hidrogênio e nitrogênio gerar um material supercondutor com características similares às defendidas pelo grupo de Rochester. O trabalho com participação dos brasileiros não foi de caráter experimental. Eles não foram ao laboratório e tentaram reproduzir o mesmo material e os resultados apresentados por Dias, como fizeram, também sem sucesso, alguns grupos internacionais. Escolheram uma abordagem de modelagem computacional em que desenham virtualmente um material e tentam prever suas propriedades eletrônicas, magnéticas e outros parâmetros com o emprego do conhecimento da física de estado sólido e de várias técnicas
Principais descobertas que impulsionaram a pesquisa em busca de materiais que conduzam eletricidade com resistência zero
1911
O físico holandês Heike Kamerlingh Onnes (1853-1926) descobre a supercondutividade no mercúrio. Resfriado a -269 ºC (4,15 K), o material passa, repentinamente, a transmitir uma corrente elétrica sem nenhuma perda de energia, ou seja, com resistência zero
1933
Os físicos alemães Walther Meissner (1882-1974) e Robert Ochsenfeld (1901-1993) identificam a segunda propriedade central dos supercondutores: a de repelir um campo magnético. O efeito faz um magneto (ímã) levitar sobre um material supercondutor
1930
A supercondutividade é medida no nióbio, o elemento puro da tabela periódica que apresenta a mais elevada temperatura crítica (Tc) conhecida, limite abaixo do qual um material apresenta resistência zero à corrente elétrica. A do nióbio é de -264 ºC (9,3 K)
Compostos elevam o valor da (Tc). Em 1941, é determinado que o nitreto de nióbio (NbN) se torna supercondutor a -257,15 ºC (16 K). Em 1953, é descoberta a Tc do vanádio-silício (V3Si), de -255,65 ºC (17,5 K), e, em 1954, a do nióbio-estanho (Nb3Sn), de -254.8 °C (18,3 K)
Três físicos norte-americanos, John Bardeen (1908-1991), Leon Cooper e John Schrieffer (1931-2019), propõem a teoria BCS, que explica em nível microscópico como
p. 47)
modernas de informática, como inteligência artificial e aprendizagem de máquina.
Dessa forma, simulam diferentes condições de temperatura e de pressão e criam, em um cluster de computadores, versões distintas de cristais a partir da combinação dos elementos químicos usados pela equipe de Rochester. O objetivo final do experimento computacional era averiguar se algum composto feito com essa receita poderia resultar em um material candidato a ser um supercondutor à temperatura ambiente.

No total, foram simulados no computador 200 mil compostos com estruturas atômicas diferentes. Dos pouco mais de 150 materiais que pareciam ser estáveis quando submetidos a uma certa corrente elétrica, o grupo identificou 52 que exibiam algum potencial para se comportar como
1962
O físico britânico
Brian Josephson prevê que uma corrente elétrica deve passar por dois supercondutores mesmo se estiverem separados por um material isolante. Essa propriedade, de tunelamento supercondutor, é conhecida como efeito Josephson
supercondutores – nenhum deles a temperaturas próximas às temperaturas em que vivem os seres humanos. “O composto que se saiu melhor poderia, segundo as simulações, transmitir uma corrente sem perda de energia apenas a 40 K, ou -233,15 ºC”, comenta Eleno.
Foi um trabalho de ocasião, que começou a ser concebido assim que o artigo do grupo de Rochester ganhou as páginas da Nature em março passado. Nessa época, Ferreira passava uma temporada na Universidade Tecnológica de Graz, na equipe de Christoph Heil, e pesquisava outro tema na área de supercondutividade. Mas, diante do enorme interesse e polêmica despertados pelo estudo da equipe de Dias, decidiram concentrar esforços em um estudo com o composto LuNH.
“Se ele fosse realmente um supercondutor à temperatura ambiente, como eles diziam, essa poderia ser a descoberta científica do século”, comenta Ferreira, que é o primeiro autor do estudo na Nature Communications e faz doutorado com bolsa da FAPESP. “Por isso, fizemos nosso estudo com rapidez. Sabíamos que os maiores grupos dedicados à procura de novos materiais, em especial da área de supercondutores, fariam o mesmo.”
Apesar de batida e talvez pretensiosa, a metáfora de que a busca por supercondutores de altas temperaturas é o Santo Graal da física – algo muito procurado, mas que ninguém encontrou – continua sendo comumente empregada. A alegoria faz sentido, ainda que não faltem outros objetivos com potencial revolucionário em vários campos científicos, inclusive na própria física. A descoberta de um material que atue como
1986
Descoberto o primeiro supercondutor de “alta temperatura”, o óxido de cobre-lantânio-bário (CuBa0.15La1.85O4), com Tc de -238,15 ºC (35 K). Não se esperava encontrar tal propriedade em um composto cerâmico, tipo de material que normalmente é um isolante elétrico
1987
Uma cerâmica feita de um óxido de ítrio, bário e cobre (YBCO) é o primeiro material conhecido a se tornar supercondutor a temperaturas superiores à do nitrogênio líquido, de -196,15 ºC (77 K), um meio mais barato de refrigeração do que o hélio líquido
Compostos submetidos a pressões milhões de vezes superiores à da atmosfera terrestre se tornam supercondutores a temperaturas mais elevadas. A Tc do hidreto metálico LaH10 é, por exemplo, de “meros” -23 ºC (250 K) a descomunais 190 gigapascal de pressão
ocorre a supercondutividade a baixas temperaturas em elementos puros e ligas simples (ver box nasupercondutor à temperatura (e pressão) ambiente poderia impulsionar novas aplicações em várias áreas, como computação quântica, transportes e na própria transmissão de eletricidade, além de gerar uma economia de energia sem paralelo.
“Hoje se gasta muito com sistemas de refrigeração que usam hélio líquido para manter os supercondutores abaixo de sua Tc”, comenta o físico Pascoal Pagliuso, da Universidade Estadual de Campinas (Unicamp), especialista em física da matéria condensada. Em tese, uma corrente elétrica circularia infinitamente em um material supercondutor – desde que mantidas as condições de temperatura e pressão que levam ao surgimento da resistência zero à passagem de eletricidade. Em um experimento no Reino Unido, a corrente em um anel supercondutor foi mantida por dois anos e meio e só se interrompeu em razão de uma greve de caminhoneiros, que atrasou a entrega do hélio líquido necessário para manter o material abaixo de sua temperatura crítica.
Além de problemas práticos, há questões teóricas mal resolvidas na supercondutividade de altas temperaturas. A chamada teoria BCS fornece as bases para a compreensão do surgimento do fenômeno da resistência elétrica zero em supercondutores clássicos, que funcionam geralmente em condições extremamente frias. Ela mostra como átomos e elétrons vibram de forma coordenada na malha estrutural de cristais supercondutores

sem acarretar perda de energia na passagem da eletricidade (ver texto na página 47). “Mas, em muitos supercondutores com temperatura crítica mais elevada, não conhecemos o mecanismo microscópico que levaria à supercondutividade e a BCS não dá conta de explicar esses casos”, comenta Ortiz.
Apassagem ou o bloqueio da corrente elétrica é um fenômeno quântico e a explicação que segue é uma simplificação do processo. Os elétrons, como seu nome indica, são as partículas responsáveis pela condução da eletricidade no interior dos materiais. Em isolantes, eles estão tão juntos do núcleo dos átomos que não conseguem se deslocar e fazer a corrente fluir. Em materiais que conduzem eletricidade, mas não são supercondutores, os elétrons se movimentam e conseguem transmitir apenas uma parte da corrente recebida.
No entanto, outros, em menor número, chocam-se com os núcleos dos átomos, que têm carga positiva e atraem os elétrons, de carga negativa. Essas colisões provocam perda de energia, na forma de calor. “É por isso que os fios de um metal condutor, como os de cobre, esquentam”, comenta o físico Mauro Doria, da Universidade Federal do Rio de Janeiro (UFRJ), especialista
Os aparelhos de ressonância magnética funcionam com o emprego de supercondutores mantidos a baixíssimas temperaturas
Apresentada em 1957 pelos físicos norte-americanos John Bardeen (1908-1991), Leon Cooper e John Schrieffer (1931-2019), a teoria BCS (alusão ao sobrenome de seus propositores) é a melhor explicação científica disponível até hoje sobre o mecanismo microscópico que estaria por trás da supercondutividade. Embora não seja atualmente considerada capaz de dar conta dos mecanismos que possibilitam a transmissão de eletricidade com resistência zero em materiais que se comportam como supercondutores a temperaturas mais altas, essa formulação de meados do século passado introduz um conceito fundamental para a compreensão geral desse fenômeno quântico: a formação dos chamados pares de Cooper.
Trata-se da contraintuitiva ligação de grupos de dois elétrons que, em certos materiais, em determinadas condições favoráveis, como a temperaturas perto do zero absoluto ou a grandes pressões, permite a passagem de corrente elétrica sem perda de energia. Por terem carga negativa, os elétrons não deveriam se atrair, mas se repelir. Entretanto, quando
um material apresenta supercondutividade, os pares de elétrons que fluem no interior da estrutura de um cristal se aproximam bastante (sem, no entanto, juntar-se ou colidir) e passam a interagir conjuntamente, como uma quase partícula, com os átomos do material, que têm carga positiva.
Os pares de Cooper se movem ordenadamente em um jogo de aproximação e distanciamento dos átomos – uma vibração ou excitação coletiva denominada fônon –e percorrem a malha estrutural do cristal sem provocar colisões. Grosso modo, são os choques dos elétrons com os núcleos dos átomos que fazem com que os materiais condutores ou semicondutores de eletricidade, como fios de cobre ou chips de silício, desperdicem parte de sua energia na forma de calor. “A teoria BCS é completa para descrever a supercondutividade, mas não explica realmente como os pares de Cooper se formam nos supercondutores de alta temperatura”, comenta o físico Pascoal Pagliuso, da Unicamp. Hoje, há praticamente um consenso de que, além da BCS, que
em supercondutividade, magnetismo e fluidos. “Sua resistência à passagem da corrente não é zero.” Pelo menos 15% da energia é dissipada como calor em materiais que transmitem correntes elétricas, mas não de forma perfeita como os supercondutores.
Os trabalhos de Ranga Dias não são os primeiros a pleitear a descoberta da supercondutividade à temperatura ambiente. Vários grupos fizeram o mesmo no passado, todos sem sucesso. Nos últimos meses, em paralelo às discussões e polêmicas sobre os estudos do grupo de Rochester, pesquisadores sul-coreanos do Centro de Pesquisa em Energia Quântica, de Seul, publicaram em julho passado, na forma de preprint no repositório arXiv, um artigo com uma reivindicação ainda mais espetacular. Diziam que tinham criado um material, u m composto de cobre, chumbo, fósforo e oxigênio denominado LK-99, com resistência zero à passagem de corrente elétrica à temperatura e pressão ambiente.
rendeu o Nobel de Física de 1972 a seu trio de formuladores, novas teorias precisam ser desenvolvidas para tentar explicar o surgimento da supercondutividade em temperaturas mais elevadas.
Apesar de ter causado muito barulho, o trabalho, que não foi aceito para publicação em nenhuma revista, carecia de rigor científico na opinião de muitos especialistas. “Eles cometeram erros de interpretação tanto no texto como nas figuras que indicariam a existência de supercondutividade”, diz Pagliuso. “Foram precipitados e amadores.” Quando um composto atinge a temperatura em que se torna um supercondutor, sua resistência à passagem de corrente elétrica cai abruptamente e chega a zero. “O trabalho dos coreanos registra uma grande queda repentina na resistência elétrica, mas ela não parecia se tornar nula nos dados mostrados.”
Não à toa, as dificuldades de encontrar materiais que deixem a corrente elétrica fluir totalmente livre, sem nenhum grau de resistência, em condições similares à do ambiente natural, levaram o físico argentino Elbio Dagotto, da Universidade do Tennessee, a afirmar, certa vez, que a supercondutividade de altas temperaturas era “o Vietnã da física teórica”. n
Dossiê reúne evidências de que estratégias não medicamentosas ajudaram a reduzir o impacto do novo coronavírus
Felipe FlorestiOuso de máscaras, a imposição de distanciamento social e outras três medidas não farmacológicas foram eficientes para conter a transmissão do novo coronavírus durante a pandemia de Covid-19 e, assim, evitar o colapso generalizado dos sistemas de saúde de diferentes países enquanto não surgiam as vacinas. Essas estratégias se mostraram úteis especialmente quando usadas em conjunto e nas fases mais iniciais, indicam as evidências científicas apresentadas em uma série de estudos de revisão publicados em agosto na revista Philosophical Transactions of the Royal Society A.
“Há evidências suficientes para concluir que a implementação precoce e rigorosa de pacotes de intervenções não farmacêuticas complementares foi inequivocamente efetiva em limitar as infecções por Sars-CoV-2”, afirmou em comunicado à imprensa o médico Mark Walport, secretário de Relações Exteriores da Royal Society, a academia britânica de ciências que edita a Philosophical Transactions, e líder do grupo de especialistas
que realizaram os estudos de revisão. “Isso não significa que todas as intervenções foram eficazes em todos os cenários ou o tempo todo, mas aprender as lições de toda a pesquisa gerada nessa pandemia será fundamental para nos prepararmos para a próxima”, concluiu.
A partir de março de 2020, bem antes de as vacinas estarem disponíveis, países ao redor do mundo adotaram conjuntos de medidas – com diferentes formatações, abrangências e intensidades – que alteraram o funcionamento da sociedade e o convívio entre as pessoas, representando a maior interferência no cotidiano da população global desde a Segunda Guerra Mundial. Com base na experiência de pandemias anteriores, como a da Gripe Espanhola de 1918, especialistas e autoridades da saúde orientaram os governos a recomendar ações como tornar obrigatório o uso de máscaras em certas situações, impor o distanciamento social e até lockdowns, antes mesmo que fosse possível conhecer em detalhes o comportamento do Sars-CoV-2 ou de ter certeza de que funcionariam contra ele. Algumas dessas medidas, em especial as duas últimas, foram bas-

Imposição de uso obrigatório de máscaras diminuiu a taxa de infecção pelo Sars-CoV-2
tante impopulares, por causarem um importante impacto econômico, além de social, em especial nas populações mais vulneráveis. Foram ações consideradas necessárias diante de um vírus que se dissemina muito rapidamente e contra o qual não se tinha imunidade.
Passada a fase crítica da pandemia, Walport reuniu seis grupos de especialistas e pediu que cada equipe revisasse os mais relevantes estudos que avaliaram cada uma das cinco principais medidas não farmacológicas adotadas para conter o vírus: uso de máscaras; distanciamento social ou imposição de lockdown; testagem, rastreio e isolamento; controle de fronteiras internacionais; e controle ambiental. Também foi analisado o impacto de ações de comunicação social sobre a aceitação dessas medidas.
O grupo liderado pelo epidemiologista Christopher Dye, da Universidade de Oxford, no Reino Unido, analisou 75 estudos que mediram em diferentes países se o uso de máscaras poderia reduzir a transmissão do Sars-CoV-2. Trinta e

cinco foram realizados nas comunidades e 40 conduzidos em unidades de saúde. Quase todos eram estudos observacionais, nos quais os realizadores acompanharam, sem interferir, os efeitos do uso versus os do não uso de máscaras. Dos 45 trabalhos que avaliaram se o aparato de proteção facial reduzia o número de infectados, 39 (87%) identificaram um efeito positivo – alguns registraram uma diminuição de pouco mais de 10% no total de indivíduos com o vírus ou com sinais de Covid-19. De 18 estudos que analisaram o impacto do uso obrigatório de máscaras, 16 concluíram que a medida reduzia a taxa de infecção. “De modo geral, o corpo de publicações analisadas demonstra que a máscara funciona”, afirma o epidemiologista Expedito Luna, da Faculdade de Medicina da Universidade de São Paulo (FM-USP), que avaliou o dossiê a pedido de Pesquisa FAPESP
Sete estudos indicaram que as máscaras do tipo N95 protegiam mais do que as cirúrgicas, embora outros cinco trabalhos não tenham encontrado diferença. “No início da pandemia, quando não havia máscaras disponíveis para todo mundo, o
Ordens para ficar em casa baixaram em 50%, em média, a transmissão do novo coronavírus
uso de máscaras de pano era melhor do que nada, mas o relatório deixa claro que aquelas de melhor qualidade reduzem mais a transmissão”, conta o epidemiologista Pedro Hallal, da Universidade Federal de Pelotas (UFPel), que também analisou os estudos da Philosophical Transactions. Entre todas as intervenções avaliadas, o distanciamento social foi a que se mostrou mais eficaz. Ordens para ficar em casa, manter uma distância
Análise de dezenas de estudos sobre cinco estratégias indica quais delas ajudaram a controlar a disseminação do vírus
Uso de máscaras
Distanciamento social e lockdown
Rastreio, checagem e isolamento
Restrições de viagens
Controle ambiental (ventilação, filtragem do ar, desinfecção)
EFEITO
Mais de 80% dos estudos mostraram que reduziu a proporção de infectados

Foram as estratégias mais eficazes. Diminuíram em média em 50% o número de casos e mortes
Não se chegou a um valor único, mas os dados sugerem que reduziram a transmissão
Em países específicos, causaram redução moderada na transmissão
Diminuiu a transmissão quando aplicada a ambientes fechados
mínima de outras pessoas e restringir o número de participantes de reuniões foram repetidamente associadas a uma redução importante na transmissão do Sars-CoV-2.
Aepidemiologista Christi Donelly, do Imperial College London, no Reino Unido, e sua equipe revisaram 338 estudos sobre nove medidas de distanciamento social. Quase metade dos trabalhos (151) avaliou o impacto da imposição de ficar em casa, que, em alguns casos, incluía ações mais restritivas, como lockdowns. Deles, 119 encontraram redução significativa no número de casos e na mortalidade. A queda média na transmissão do vírus foi de 50%, embora os valores tenham variado consideravelmente (de 6% a 81%) entre os estudos, que usaram desenhos diferentes, analisaram populações distintas nas quais foram adotadas formas diversas de restrição.
“Manter as pessoas em casa reduz bastante, e pode praticamente zerar, a transmissão do vírus por um período”, explica Hallal. “No Brasil, não funcionou porque se quis dar um ‘jeitinho’ no distanciamento para não atrapalhar as atividades econômicas.” Na opinião do epidemiologista Eliseu Waldman, da Faculdade de Saúde Pública da USP, o distanciamento social deixou mais claras as diferenças sociais no Brasil. “Boa parte da população não pôde pôr a medida em prática porque precisava sair de casa para conseguir o que comer a cada dia”, afirma.
A equipe da epidemiologista Elizabeth Fearon, da University College London, no Reino Unido, olhou 1.181 estudos e, entre eles, encontrou apenas 25 trabalhos que mediram empiricamente e em nível populacional a estratégia de testar as pessoas suspeitas de estarem infectadas, rastrear os indivíduos que tiveram contato com elas e isolar aqueles em que a infecção foi confirmada. No entanto, devido à diversidade de abordagens adotadas, não foi possível comparar os dados seguindo uma única métrica de impacto. “Em geral, esses estudos mostraram que a testagem e/ou o rastreio de contatos estavam associados a reduções na transmissão”, escreveram os pesquisadores.
Apesar de a maioria dos países ter introduzido restrições de viagem durante a pandemia, a especialista em políticas de saúde Karen Grépin, da Universidade de Hong Kong, e seus colaboradores encontraram poucos estudos examinando a eficácia dessas medidas. Segundo os pesquisadores, estudos de casos nacionais, como o da Nova Zelândia, mostraram que políticas abrangentes de controle de fronteiras podem reduzir, mas não eliminar, o número de viajantes infectados. As restrições de viagem de países específicos tiveram um efeito moderado na transmissão, mas
No final de agosto, a Agência Nacional de Vigilância Sanitária (Anvisa) aprovou o início da segunda fase de testes em seres humanos da SpiNTec, o único composto candidato a vacina contra a Covid-19 desenvolvido integralmente no Brasil. Essa é a penúltima etapa de ensaios clínicos antes da liberação para a comercialização.
A SpiNTec é um dos três candidatos a imunizante contra o novo coronavírus desenvolvido com a participação de brasileiros a chegar à fase de testes em pessoas (ver Pesquisa FAPESP nº 321). Ela foi criada pela equipe do Centro de Tecnologia de Vacinas (CTVacinas) da Universidade Federal de Minas Gerais (UFMG), em parceria com a Fundação Oswaldo Cruz (Fiocruz) em Minas Gerais e recebeu investimentos de instituições federais, da Prefeitura de Belo
Horizonte e da bancada mineira na Câmara dos Deputados.
Na segunda fase de testes, a formulação será administrada a cerca de 360 voluntários com idades entre 18 e 65 anos, saudáveis ou com doenças crônicas controladas, que receberam anteriormente doses de CoronaVac ou do imunizante da AstraZeneca e o reforço da vacina da Pfizer/BioNTech ou da AstraZeneca. “Esse é um importante passo para a obtenção do registro”, disse o imunologista Ricardo Gazzinelli, coordenador do CTVacinas e pesquisador da Fiocruz em Minas Gerais, à Agência FAPESP. Os participantes serão acompanhados por um ano.

O objetivo dessa segunda fase é continuar avaliando a segurança da formulação e identificar os efeitos indesejáveis que possam
rapidamente se tornaram menos eficazes à medida que o número de casos aumentou. Já a quarentena na fronteira de entrada foi considerada mais eficaz para reduzir a transmissão do vírus.
Aequipe coordenada pelo engenheiro Shaun Fitzgerald, da Universidade de Cambridge, no Reino Unido, buscou na literatura científica evidências de que medidas de controle ambiental – como melhorar a ventilação dos locais e realizar a filtragem do ar ou a desinfecção de superfícies, entre outras – poderiam ajudar a diminuir a transmissão do vírus. De 14 mil artigos identificados, apenas 19 haviam sido revisados por pares. Segundo os autores da revisão, esses trabalhos sugerem que essas medidas são capazes de reduzir a transmissão do Sars-CoV-2 se aplicadas a ambientes fechados.
A revisão coordenada pelo sociólogo Simon Williams, da Universidade de Swansea, no País de
surgir, além de avaliar marcadores imunológicos de eficácia.
Informações iniciais do ensaio clínico de fase 1, apresentadas em junho, indicaram que a SpiNTec é segura (não causa problemas graves de saúde) e capaz de induzir a resposta imunológica. Além de estimular a produção de anticorpos contra a proteína da espícula do Sars-CoV-2, como a maioria das vacinas disponíveis, a nova formulação potencializa a ativação dos linfócitos T, células que combatem as células infectadas pelo vírus. Essa dupla ação, em princípio, pode torná-la eficaz também contra novas variantes. Se tudo correr bem, a última etapa de testes deve ocorrer no próximo ano. “Já temos recursos da Finep aprovados para a fase 3, que serão liberados mediante o sucesso da atual fase do estudo”, contou Gazzinelli.
Gales, avaliou a eficácia das estratégias de comunicação para fazer as pessoas aderirem às medidas não farmacológicas de controle da Covid-19. Foram analisados 13 trabalhos, que levaram em conta exclusivamente o contexto do Reino Unido. A confiança – no governo, nos pesquisadores e nas autoridades da saúde – foi o fator que mais impactou a eficácia da comunicação, sendo mencionado em 10 dos 13 estudos. A baixa confiança no governo levou a uma menor adesão ou a uma maior crença em teorias conspiratórias. Igualmente importantes também foram a clareza e a consistência da mensagem. “Mensagens ambíguas” geraram confusão e, em alguns casos, falta de adesão, afirmaram os pesquisadores.
Estratégia de testar, rastrear e isolar infectados também mostrou potencial de reduzir a disseminação do vírus
Da leitura do dossiê, fica claro que ainda são necessários estudos mais específicos para mensurar melhor o efeito de cada medida. Nos trabalhos analisados, muitas haviam sido adotadas simultaneamente, o que dificultou a separação do efeito de cada uma. Luna, da USP, lembra ainda que não foram avaliadas as consequências sociais e econômicas dessas medidas. Apesar das limitações, Hallal afirma que o relatório organizado por Walport é importante por acrescentar evidências empíricas ao que já se sabia em teoria ou havia sido demonstrado pontualmente por estudos isolados. “Essas revisões mostraram serem efetivas várias medidas que recomendamos mil vezes durante a pandemia. Muitas mortes poderiam ter sido evitadas se essas ações tivessem sido tomadas no Brasil”, conclui o epidemiologista da UFPel. n
Agente causador da enfermidade circula de modo ininterrupto há
Em 30 de abril, um homem de 44 anos que morava em São João da Boa Vista, município a 210 quilômetros ao norte da capital paulista, morreu em consequência da febre amarela. Foi o segundo óbito provocado pela doença em 2023 no estado de São Paulo, onde havia três anos não se registravam casos humanos da enfermidade. Após a fase mais intensa do surto atual, o maior em décadas, que entre 2016 e 2020 deixou cerca de 2,3 mil pessoas doentes e matou mais de 600 nas regiões Sudeste, Centro-Oeste e Sul do país, a febre amarela arrefeceu. Sua ocorrência diminuiu muito, mas a circulação do vírus que a causa não cessou. Segundo dados da Organização Pan-americana da Saúde (Opas), de julho de 2022 a meados de março, houve 300 prováveis casos da
doença no Brasil, dos quais três foram confirmados, com uma morte – a segunda morte em São Paulo ocorreu posteriormente. No mesmo período, centenas de macacos foram achados sem vida em matas próximas a regiões urbanas, suspeitos de estarem infectados com o vírus, que provoca lesões no fígado, nos rins e no coração, e mata até metade das pessoas que desenvolvem a forma grave da doença.
“É a primeira vez que um surto fora da Amazônia dura tanto. São quase sete anos de transmissão ativa, em alguns períodos com duas variedades do vírus circulando simultaneamente”, afirma a virologista Camila Zanluca, pesquisadora do Instituto Carlos Chagas, unidade da Fundação Oswaldo Cruz no Paraná (ICC/ Fiocruz-PR). Zanluca e a virologista italiana Marta Giovanetti, da Fiocruz no Rio de Janeiro, são as autoras principais
de um artigo publicado em setembro na revista Science Advances descrevendo a dinâmica de dispersão recente do vírus no Brasil. No trabalho, pesquisadores de 46 instituições no país e no exterior sequenciaram o genoma de 147 amostras do vírus obtidas de seres humanos, macacos e mosquitos infectados entre 2015 e 2022 e confrontaram com outros 296 genomas de exemplares do patógeno que circularam nas últimas décadas em países das Américas Central e do Sul – a febre amarela é endêmica em 13 países da região, além de outros 34 da África.
A análise de um número tão grande de genomas do vírus – a maior já feita com material brasileiro – revelou surpresas. A primeira é que, no surto atual, o agente da febre amarela chegou ao Centro-Sul do país dois a três anos antes do que se pensava, vindo de algum ponto na Ama-

Células renais de macaco (com núcleo azul) infectadas pelo vírus da febre amarela (em verde)
zônia. “Os dados atuais indicam que o vírus entrou no Sudeste entre o final de 2013 e o início de 2014”, conta o virologista Luiz Carlos Júnior Alcântara, pesquisador do Instituto René Rachou, em Minas Gerais, também da Fiocruz, e um dos coordenadores do estudo atual. Ele participou de um trabalho anterior, publicado em 2018 na revista Science, que havia calculado, a partir da análise de 62 genomas, que o vírus teria alcançado a região, mais especificamente o estado de Minas Gerais, apenas no final de 2016.
A segunda novidade do artigo da Science Advances é que nos últimos sete anos três variedades do vírus circularam no Centro-Sul do Brasil, duas delas concomitantemente em certos períodos. Definidas com o nome técnico de clados Ia, IIb e IIIc, todas integram o genótipo sul-americano I, o mais comum no país. Elas, no entanto, diferem entre si por alterações pontuais, em especial no gene
que codifica uma enzima que auxilia a replicação do material genético do vírus no interior das células do hospedeiro (mosquito, macaco ou humano).
Ao combinar as características genéticas das amostras com o local em que foram coletadas, os pesquisadores conseguiram reconstruir ao menos parcialmente os caminhos trilhados por cada variedade do vírus. Vindos da região Norte, os integrantes do clado Ia entraram no Sudeste por Minas Gerais, perto do início de 2014, embora os primeiros casos em macacos e seres humanos só tenham sido detectados no fim de 2016. Dali, eles alcançaram o Espírito Santo e depois se espalharam para o Rio de Janeiro e a Bahia, no Nordeste, como já havia sido indicado em um artigo publicado em 2019 no Journal of Virology, também coordenado por Alcântara.


Quase ao mesmo tempo, o IIb emergiu em Goiás, no Centro-Oeste, e um ano mais tarde chegou a Minas, de onde se espalhou para o estado de São Paulo. A seguir, alcançou os estados da região Sul, onde permanece em circulação. “Ainda hoje recebemos amostras de vírus extraídas de primatas não humanos, principalmente dos estados do Sul, que per-
A partir do sequenciamento do vírus, pesquisadores reconstroem as rotas de dispersão
tencem ao clado IIb”, afirma a virologista Claudia Nunes Duarte dos Santos, chefe do Laboratório de Virologia Molecular do ICC/Fiocruz-PR, e também coordenadora do estudo atual.
Do clado IIIc, há menos informação, uma vez que havia menos de 20 genomas disponíveis. Sabe-se que ele é geneticamente mais próximo que os outros dois de uma variedade ancestral, detectada em 2002 em Roraima. Ele surgiu na região Norte, em 2017, e depois seguiu para o Centro-Oeste, antes de chegar ao Sudeste.
“A circulação do vírus da febre amarela no eixo Norte-Sul já havia sido sugerida por outros autores, a partir de observações empíricas”, lembra o virologista Renato Souza, especialista em febre amarela da unidade de Taubaté do Instituto Adolfo Lutz, que não participou do estudo. “O artigo atual se baseia em dados de sequenciamento genético de alta qualidade para reconstruir a história de difusão do vírus no espaço e no tempo, permitindo traçar os caminhos mais prováveis de espalhamento”, afirma.
Para o infectologista Marcos Boulos, da Universidade de São Paulo (USP) e assessor da coordenadoria de Controle de Doenças da Secretaria de Estado da Saúde de São Paulo, o trabalho é revelador por mostrar que o vírus permanece em circulação o tempo todo desde o início do surto atual. “A análise dos casos clínicos não permitia observar isso de modo tão evidente”, comenta. “É um resultado que amplia o conhecimento científico sobre o comportamento do vírus, mas que não altera o tratamento.”
Cerca de 90% das pessoas infectadas não apresentam ou têm poucos sintomas, nem sabem que tiveram o vírus. Os outros 10% se dividem entre casos leves e graves. A forma mais eficaz de prevenir a doença é por meio da vacinação. Produzido com vírus vivo atenuado de uma variedade africana, o imunizante é seguro e oferece proteção pela vida toda. No Brasil, o Programa Nacional de Imunizações recomenda a administração de uma dose inicial aos 9 meses de idade, com um reforço aos 4 anos. n
Avariedade de vírus da gripe aviária que vem se disseminando pelo Brasil é muito provavelmente originária da região costeira do Chile ou do Peru. Pesquisadores brasileiros sequenciaram o genoma do patógeno que infectou a primeira ave brasileira identificada com a doença – um trinta-réis-de-bando (Thalasseus acuflavidus) encontrado morto em maio deste ano em Marataízes, no litoral sul do Espírito Santo – e concluíram que ele é geneticamente similar à variedade do vírus que circula desde 2022 nos dois vizinhos sul-americanos. Os resultados da análise se tornaram disponíveis em 21 de agosto em um artigo disponibilizado no repositório de preprints da Social Science Research Network (SSRN), que armazena os documentos ainda não revisados por pesquisadores independentes.
“Nosso estudo é um breve relato do primeiro caso identificado no Brasil”, conta o microbiologista Aristóteles Góes-Neto, da Universidade Federal de Minas Gerais (UFMG). Ele participou do sequenciamento e da análise do genoma do vírus em parceria com pesquisadores ligados ao Hospital Israelita Albert Einstein, em São Paulo, e ao Ministério da Agricultura, Pecuária e Abastecimento
(Mapa). “A espécie infectada, o trinta-réis-de-bando, é muito comum no país, encontrada do Amapá ao Rio Grande do Sul, inclusive nas ilhas oceânicas.”
A variedade de alta patogenicidade do vírus da influenza A (H5N1) que hoje circula por aqui surgiu em 2020 na Europa e, de lá, alcançou outros continentes. Chegou aos Estados Unidos em 2021 e, no ano seguinte, já estava na costa do Pacífico da América do Sul (ver reportagem “Brasil declara emergência zoossanitária para prevenir espalhamento de gripe aviária”, disponível no site). Em maio deste ano, ou até mesmo antes, entrou no Brasil, possivelmente trazida por aves migratórias.
Transmitida por meio de contato com secreções respiratórias ou fezes infectadas, essa cepa do vírus provoca uma forma grave de gripe em certos grupos de aves, letal para quase todos os animais infectados. Em geral resistentes, as aves aquáticas migratórias atuam como hospedeiros naturais e reservatórios dos vírus e têm papel importante na sua evolução, manutenção e disseminação. “O H5N1 gera sintomas clínicos nos tratos respiratório e digestório e no sistema nervoso das espécies sensíveis a essa infecção, embora também existam casos de animais assintomáticos”, conta a veterinária Helena Lage Ferreira, professora da Universidade de São Paulo
(USP) e presidente da Sociedade Brasileira de Virologia.
De maio a 21 de setembro, equipes do Mapa registraram 106 focos da doença no Brasil, sendo 103 em aves silvestres e três em aves criadas para subsistência –até o momento, nenhum em granjas de produção comercial. Outros dez potenciais focos da doença continuavam em investigação.
“A vigilância e o monitoramento constantes são necessários para o controle rápido e a redução de danos, caso o vírus chegue aos criatórios comerciais, evitando, assim, uma epidemia”, afirma Góes-Neto. Se o vírus atingir a produção comercial no país, pode haver um impacto importante na economia. O Brasil é o segundo maior produtor de carne de frango do mundo e o maior exportador. Para reduzir o risco de que isso ocorra, os especialistas recomendam que os estabelecimentos de produção avícola adotem medidas de biosseguridade, como manter as aves domésticas em ambientes telados, para reduzir a exposição às aves silvestres; desinfectar equipamentos e veículos; limitar a entrada de visitantes em granjas; e usar equipamentos de proteção pessoal durante o trabalho.

ECOLOGIA
Uma cena do Cerrado brasileiro: uma mosca sobrevoa a vegetação em busca do local ideal para depositar as centenas de ovos que carrega no abdômen. Eis que se depara com uma flor repleta de afídeos, pequenos insetos conhecidos como pulgões, ingrediente único da dieta das larvas dessa mosca. Talvez a mosca nem tenha tempo de perceber que os afídeos são falsos, porque, assim que pousa para iniciar a oviposição, escorrega e despenca para dentro da flor. A descrição da armadilha de Phragmipedium vittatum foi publicada pela equipe liderada pelo biólogo João Custódio Cardoso, da Universidade Federal de Uberlândia (UFU), na edição de fevereiro da revista Annals of Botany. Durante as observações, os pesquisadores identificaram principalmente duas espécies de moscas-das-flores: Allograpta exotica e Dioprosopa clavata, ambas da família dos sirfídeos.

A flor que engana as moscas, P. vittatum, é uma espécie de orquídea do Brasil Central, bastante visada por colecionadores e por isso ameaçada de extinção. O gênero Phragmipedium é um dos que abrigam espécies conhecidas como orquídeas-sapatinho, que se distinguem por uma modificação na pétala de baixo (labelo), que lhes dá um formato de bolsa ou sapato.
Depois de depositar pequenos ovos brancos junto aos falsos pulgões pretos, mosca escorrega e tenta, sem sucesso, voltar à plataforma de pouso

Entre os polinizadores da orquídea-sapatinho (no alto), típica do Brasil Central, está a mosca-das-flores Allograpta exotica (embaixo)
As moscas-das-flores são consideradas excelentes polinizadoras de algumas plantas e também costumam ser usadas na agricultura em procedimentos de controle biológico de pragas, justamente pelo intenso apetite de suas larvas por pulgões que sugam a seiva de algumas plantas e podem danificar safras inteiras. Outra característica marcante desse grupo de moscas é que elas lembram abelhas, o que as protege, por exemplo, de ataques de aves.
Cardoso explica que, em geral, as orquídeas-sapatinho não fornecem aos insetos recursos como néctar ou óleos, mas os atraem com formas, cores e odores específicos. Uma vez enganadas, as moscas realizam a polinização sem receber nada em troca. O percurso da polinização começa quando a orquídea chama a atenção da mosca que pode carregar aderidos às costas, como uma grande mochila, milhares de grãos de pólen de uma visita anterior. A atração das moscas se deve tanto aos pontinhos pretos das flores que imitam pulgões, o alimento para as larvas, quanto a características mais usuais que chamam a atenção desses insetos, como a cor amarela.

Após escorregar pelo amplo e viscoso labelo, a mosca tenta voltar pelo mesmo caminho e ganhar a liberdade, mas não consegue. O único caminho possível é atravessar o labirinto interno
e sair por um dos dois minúsculos orifícios no topo da flor. Durante o esforço de se esgueirar pelo espaço apertado, ela deixa pólen no estigma (o órgão reprodutivo feminino da flor). Mais adiante, ela recolhe um novo pacote de pólen ao passar por uma das anteras (o órgão masculino), que poderá carregar para a flor seguinte. Da experiência, a mosca leva o prejuízo de tempo e energia. Frequentemente, deixa ovos pelo caminho, que são desperdiçados, uma vez que as larvas não encontram os pulgões necessários a seu desenvolvimento.
Ogrupo da UFU também descobriu que a superfície do tecido vegetal por onde a mosca escorrega é composta por células voltadas para baixo, em formato de telhado. Essa característica anula a capacidade de aderência das moscas, que depende de as garras de suas pernas se engancharem em superfícies rugosas. Essa região da flor é também coberta por mucilagem, uma substância viscosa. Nessas condições, as pequenas ventosas adesivas que as moscas têm distribuídas nas pernas não conseguem se prender. “Não é um ou outro atributo que garante que ela escorregue”, explica Cardoso. “A combinação dos dois dribla as adaptações da mosca.” A superfície do caminho de saída é revestida por tricomas (estruturas análogas aos pelos dos animais) nos quais a mosca se agarra, facilitando o caminho para fora.
Superfícies escorregadias e aderentes não são novidade em flores-armadilha e algumas plantas carnívoras, mas a observação é inédita em orquídeas. O caso de P. vittatum também é único por ser o primeiro mimetismo de afídeos relatado nas Américas. “Isso mostra que espécies ameaçadas de extinção podem guardar segredos incríveis, e devem ter a oportunidade de ser estudadas”, comenta o pesquisador.

UM CRIME PERFEITO?
Segundo os pesquisadores, é admirável que a evolução possa ter dado origem a uma interação na qual uma das partes não recebe nada em troca e ainda por cima pode perder a própria prole. Como poderia existir um encaixe, à primeira vista tão perfeito, entre as estruturas da orquídea e essas moscas?
O biólogo Anselmo Nogueira, da Universidade Federal do ABC (UFABC), estuda como interações ecológicas podem mudar o curso da evolução das plantas e explica que há um viés temporal no olhar humano sobre esses sistemas. Para ele, é necessário sempre levar em conta o saldo energético dessas interações. Ao longo do tempo evolutivo, o surgimento desse sistema de-
Estrutura das flores obriga insetos a contribuírem para a reprodução da planta
5
1
Mosca fêmea é atraída pela falsa presença de pulgões…
2
… e pousa em uma plataforma escorregadia que a faz descer como por um tobogã
Um pouco mais adiante, recolhe outro pacote de pólen que poderá levar à próxima flor
4
… para passar por um espaço estreito onde deixa o pólen que traz de outra flor
3
No caminho de saída, encontra pelos onde pode se agarrar…
Microscopia eletrônica permite enxergar o alto relevo dos falsos pulgões (à esq.) e, olhando mais de perto, as células escorregadias em forma de telhado


pende do balanço entre custos e benefícios, que varia de acordo com as condições do ambiente.
“Isso que chamamos de condicionalidade do resultado da interação é um aspecto teórico mais recente, muito importante para os estudos das interações ecológicas, incluindo antagonismos e mutualismos”, afirma. “Por exemplo, um polinizador pode sair no prejuízo se gastar muito tempo e energia visitando uma flor que impede seu acesso ao recurso floral, em relação ao que aconteceria com outras espécies de planta. Esse raciocínio só faz sentido se no ambiente houver flores com pólen ou néctar mais acessível para esse visitante”, continua Nogueira. “Em um ambiente com escassez, a relação poderia valer a pena, pois, apesar do gasto energético, pequenas porções de pólen ou néctar poderiam fazer toda a diferença”, diz ele.
No caso da orquídea-sapatinho e das duas espécies de mosca-das-flores, é difícil imaginar em um primeiro momento que a evolução tenha mantido um comportamento tão custoso para o inseto caso as fêmeas escolham com frequência depositar os ovos na orquídea traiçoeira. Os custos, afinal, são altos demais: o sacrifício da prole e, ocasionalmente, a morte do próprio adulto quando não conseguisse passar pelo canal. Investigações mais profundas do significado evolutivo do “golpe do berçário da orquídea-sapatinho” dependerão de outros fatores a serem estudados. Entre eles: analisar a presença de outras espécies de plantas utilizadas pelas moscas; o número de vezes que uma mesma mosca insiste no engano até aprender com a experiência negativa e passar a depositar seus ovos em outra superfície; e a proporção de ovos perdidos em relação ao conjunto total de uma fêmea. n
Insetos polinizadores
teriam surgido há
120 milhões de anos no supercontinente
Gondwana Ocidental, formado pelas atuais
América do Sul e África
Sarah SchmidtHá cerca de 120 milhões de anos, início do período Cretáceo, grupos de dinossauros ainda caminhavam pela Terra quando as primeiras abelhas surgiam nas atuais América do Sul e África, então conectadas como parte do supercontinente Gondwana. “O ancestral comum das abelhas provavelmente surgiu em meio ao clima mais árido que essa região tinha. Até hoje, a maioria das mais de 20 mil espécies já catalogadas prefere áreas mais secas, onde são mais diversificadas”, contou o biólogo Eduardo Almeida, do campus de Ribeirão Preto da Universidade de São Paulo (USP), enquanto se preparava para apresentar os resultados em um workshop sobre evolução das abelhas na cidade de Portal, no Arizona, Estados Unidos, em meados de agosto.
Ao lado do colega alemão Silas Bossert, da Universidade Estadual de Washington, ele liderou o estudo publicado em agosto na revista científica Current Biology, que tornou mais nítido esse quadro esboçado em estudos anteriores pela
análise de sequências de DNA de diferentes partes do genoma de 216 espécies de abelhas de todas as sete famílias e 28 subfamílias conhecidas hoje. As amostras vieram dos cinco continentes onde as abelhas vivem (todos, exceto a Antártida), graças aos dados e espécimes depositados em museus de pesquisa – Almeida é curador da coleção entomológica Prof. J. M. F. Camargo, que abriga centenas de milhares de exemplares de abelhas. Os pesquisadores compararam estimativas genéticas de idade e dados da distribuição geográfica dessas espécies com informações provenientes de 220 fósseis e locais onde foram coletados. Todas essas informações permitiram ao grupo traçar a árvore genealógica (filogenia) das abelhas, estimando as relações de parentesco evolutivo entre as principais linhagens e as idades dos eventos evolutivos. O resultado é uma linha do tempo que indica onde e quando as primeiras espécies teriam surgido e como os grupos se dividiram, diversificaram cores, formas, comportamentos e modos de organização, e se dispersaram pelo pla-

neta ao longo do tempo, acompanhando a reacomodação dos continentes.
Segundo os resultados do grupo de Ribeirão Preto, a partir do momento em que surgiu o ancestral comum das abelhas, por volta de 124 milhões de anos atrás, um processo contínuo de diversificação foi influenciado pela configuração dos continentes na época, a subida e descida do nível do oceano e as mudanças no clima que ocorreram nos diferentes períodos geológicos.
“A separação do supercontinente levou a uma mudança na configuração de como as abelhas se distribuíam pelo mundo”, diz Almeida. Os dados sugerem que, das sete famílias atuais, apenas Melittidae ainda não existia há cerca de 100 milhões de anos na região hoje correspondente à América do Sul. Talvez graças a isso, as abelhas resistiram à queda do asteroide tido como responsável pela extinção em massa dos dinossauros, no golfo do México, há cerca de 60 milhões de anos. “Elas já estavam espalhadas pelo planeta, em uma distribuição próxima da atual”, pondera Almeida. Ele lembra que, a partir desse período, alguns ambientes tropicais começaram a se expandir para latitudes mais elevadas, o que permitiu que os grupos que viviam nas regiões tropicais e subtropicais no hemisfério Sul avançassem rumo à América do Norte, Europa, Ásia e norte da África.
Grupos de abelhas provavelmente chegaram à Austrália entre 70 e 35 milhões de anos atrás, com os primeiros originados na América do Sul e percorrido uma rota atravessando a Antártida, que fazia a ligação ao sul entre os dois continentes e tinha um clima mais ameno que o atual.
Tempos depois, outras abelhas que já estavam no continente asiático também teriam colonizado a Austrália. Já na Índia, elas devem ter chegado por volta de 50 milhões de anos atrás, depois que o território do atual país indiano, que havia se desprendido da Gondwana antes da origem das abelhas, chocou-se com o continente asiático e encontrou a fauna local.
A aparência da abelha ancestral ainda é uma incógnita: seria grande ou pequena, vivia em sociedades organizadas em colmeias ou era solitária? Almeida arrisca um palpite: provavelmente seria solitária, já que hoje 85% das espécies têm esse tipo de hábito, com seus integrantes vivendo em tocas individuais no chão. Almeida vem investigando também meios de reconstruir a morfologia ancestral desses insetos.
Aproposta de que as abelhas surgiram na porção ocidental da Gondwana, que incluía América do Sul e África, não é nova. Ela foi aventada pelo entomólogo norte-americano Charles Michener (1918-2015) ainda em 1979 em um artigo publicado na revista Annals of the Missouri Botanical Garden. Michener, “avô” acadêmico de Almeida, é uma referência no estudo da evolução das abelhas e chegou a passar um ano no Brasil em 1956, trabalhando com o entomologista brasileiro Jesus Santiago Moure (1912-2010), conhecido como padre Moure, na UFPR em Curitiba. “Quarenta anos depois, o avanço nas análises genéticas e computacionais, além da descoberta de muitos fósseis de abelhas, permitiu que trouxéssemos mais evidên-

cias e novos dados para sua hipótese”, observa o pesquisador de Ribeirão Preto.
A bióloga Vera Lucia Imperatriz Fonseca, do campus paulistano da USP, que não participou do estudo, observa que a pesquisa é a mais ampla filogenia de abelhas já feita. “Antigamente estudávamos as abelhas do nosso quintal. Hoje podemos estudar as abelhas do mundo”, diz ela, que ressalta a importância da preservação e expansão das coleções de insetos do país, inclusive de abelhas, para que esse tipo de pesquisa seja ampliado.
“A associação entre as abelhas e as flores ao longo dos milhões de anos é outro ponto que o trabalho ajuda a pensar”, diz o biólogo Guilherme Cunha Ribeiro, da Universidade Federal do ABC (UFABC), que também não participou do estudo. Em artigo publicado em 2022 na revista Cretaceous Research, Ribeiro e colegas descrevem na família Crabronidae uma nova espécie de vespa extinta, que ganhou o nome Exallopterus spectabilis, cujo fóssil foi localizado na formação Crato, em Nova Olinda, no Ceará. Sua idade foi estimada entre 125 e 115 milhões de anos.
“Argumentamos que, se a família Crabronidae, considerada por alguns estudos como irmã das abelhas, já existia nesse intervalo, então as abelhas também teriam que existir”, diz Ribeiro. Como ainda não foram encontrados fósseis de abelhas na região, apesar da grande abundância de insetos já coletados, ele sugere que uma das explicações pode ser que elas tenham se diversificado mais ao sul da Gondwana.
Almeida explica que, em algum momento, vespas carnívoras se tornaram vegetarianas, passaram a se alimentar de pólen e, depois disso, surgiram as abelhas. “Elas se tornaram dependentes das flores e o principal grupo responsável pela polinização.” Por isso, uma das conclusões do trabalho coordenado por ele é de que a rica biodiversidade de plantas da América do Sul está relacionada com o fato de ser o continente onde as abelhas estão há mais tempo. Elas levaram milhões de anos para se estabelecer, adaptar-se e se diversificar. “Se as mudanças climáticas transformarem os ambientes de maneira radical, não sabemos se elas vão conseguir se adaptar”, alerta. n
Abate para a subsistência em reservas extrativistas tem impacto limitado sobre a população de animais silvestres
Felipe FlorestiUm impasse se instalou anos atrás em Periquito, uma das comunidades espalhadas nas proximidades e no interior da Reserva Extrativista Riozinho da Liberdade, próxima à cidade de Cruzeiro do Sul, no Acre. Percebendo que precisavam percorrer distâncias cada vez maiores para encontrar uma paca, um veado ou queixada para se alimentar, os moradores instituíram uma norma: de um lado do rio, era permitido caçar com a ajuda de um cão; do outro, não. O auxílio canino tornava a captura mais eficiente, talvez até demais, exaurindo a oferta de alimento.
Ricardo Sampaio, biólogo e analista ambiental do Instituto Chico Mendes de Conservação da Biodiversidade (ICMBio), chegou a Periquito em 2018 em meio às discussões sobre a efetividade
da restrição autoimposta. Seu objetivo era investigar o impacto da caça sobre as populações de mamíferos e aves das reservas extrativistas, as Resex, unidades de conservação que também se destinam à preservação dos meios de vida e da cultura de populações tradicionais por meio da exploração sustentável dos recursos naturais. Além das 8 comunidades da Resex Riozinho da Liberdade, ele e colaboradores coletaram dados em outras 91 localizadas em mais 8 unidades de conservação de uso sustentável do centro e do sudoeste da Amazônia. Publicados em agosto na revista Biological Conservation, os resultados sugerem que a caça de subsistência, permitida exclusivamente para a alimentação de quem vive nessas áreas, produz um impacto importante sobre as populações de algumas espécies silvestres apenas nas proximidades – a menos de 5 quilômetros (km) – das comuni -
dades humanas. A distâncias maiores, o efeito diminui.
“Em outras florestas tropicais, esse impacto da caça se estende por distâncias maiores, de 7 km a 10 km”, afirma Sampaio. Segundo o biólogo, a ausência de um comércio legal de carne de caça no Brasil contribui para reduzir o impacto. “No Peru e em países da Ásia e da África nos quais a caça é permitida, a área em que as espécies silvestres são afetadas é maior”, conta Sampaio.
“Em ecossistemas muito fragmentados, como os encontrados mais ao sul do Brasil, esses 5 km podem parecer muito. Na Amazônia, é pouco”, comenta o ecólogo australiano William Ernest Magnusson, pesquisador do Instituto Nacional de Pesquisas da Amazônia (Inpa), que não participou do estudo.
Entre 2013 e 2019, Sampaio e seus colaboradores percorreram as 100 comuni-

dades situadas próximas ou no interior de nove Resex e, em cada uma delas, instalaram cerca de 10 armadilhas fotográficas que permitiram registrar a presença de 29 espécies de mamíferos e aves. As câmeras foram posicionadas em linha a distâncias que variavam de 75 metros a 15 km do centro de cada comunidade e permaneceram ativas por 42 dias, em média. “Eram necessários quase uns 30 dias para instalar as câmeras em cada Resex e mais 30 para retirá-las”, lembra Sampaio.
Os registros das armadilhas fotográficas foram usados por ele e pelos pesquisadores Ronaldo Morato, também do ICMBio, e Adriano Chiarello, da Faculdade de Filosofia, Ciências e Letras de Ribeirão Preto da Universidade de São Paulo (FFCLRP-USP), para calcular a diversidade de espécies e o número de indivíduos a diferentes distâncias das comunidades. Além da proximidade dos povoa-
Veado-cinza (Mazama nemorivaga) e grupo de queixadas (Tayassu pecari), flagrados por uma das armadilhas fotográficas usadas no estudo
dos, os pesquisadores levaram em conta a influência de mais seis variáveis sobre a diversidade e a população de animais silvestres: número de habitantes e densidade populacional humana na comunidade, distância e número de habitantes do centro urbano mais próximo, disponibilidade de proteína proveniente da pesca e localização dentro ou fora da Resex.
De longe, o fator que mais contribuiu para diminuir a diversidade de espécies e o tamanho de suas populações foi a proximidade das comunidades rurais. A menos de 5 km dos povoados, o tamanho da população das 29 espécies silvestres era menor do que a 15 km de distância. Treze dessas espécies apresentaram uma redução superior a 50%. As populações de anta, mutum, queixada, veado-cinza e cutiara sofreram algum grau de declínio mesmo a distâncias maiores, enquanto as de veado-vermelho, paca e cutia, mais
adaptadas a ambientes alterados, foram encontradas em maior abundância a menos de 5 km das comunidades.
Na opinião dos pesquisadores, as três últimas espécies, em teoria, poderiam se tornar candidatas a ter suas populações manejadas por meio de caça controlada por essas comunidades, com a possibilidade de comercialização do excedente, o que já é permitido pela legislação que rege o funcionamento das Resex, a Instrução Normativa nº 26 do Instituto Brasileiro do Meio Ambiente e dos Recursos Naturais Renováveis (Ibama), de 2002. Em contrapartida, moratórias protegeriam as espécies mais sensíveis.
No Brasil, a Lei de Proteção da Fauna, de 1967, proibiu a caça e ajudou a controlar o mercado de carne e de pele de animais silvestres, mas deixou no limbo as populações que vivem em áreas onde essa é uma das poucas fontes disponíveis de proteína animal. Embora a norma do Ibama permita a exploração da fauna em áreas de uso sustentável e a Lei de Crimes Ambientais, de 1998, determine que não é crime a caça realizada em “estado de necessidade, para saciar a fome”, nenhuma norma define o que é “estado de necessidade”. Assim, fica a cargo dos juízes decidir se em determinada situação a caça ocorreu de modo ilegal ou se foi para subsistência.


“A caça está proibida há tanto tempo no país que não temos mais a cultura dessa atividade e não sabemos, por exemplo, quantos indivíduos de queixada, veado ou caititu poderiam ser explorados por quilômetro quadrado sem afetar a conservação da espécie”, afirma Chiarello, da USP, um dos autores do estudo. “Isso talvez pudesse mudar.”
O trabalho de Sampaio ajudou a comunidade de Periquito a tomar uma decisão. Os dados mostraram que a abundância e a diversidade de espécies eram maiores na margem do rio em que os cães haviam sido banidos. “Depois de um ano, eu recebi uma ata de uma reunião em que eles reforçavam o acordo de não usar cachorros. Eles também passaram a controlar a reprodução dos cães”, conta o pesquisador. n

Pesquisadores analisaram ostras e mexilhões para verificar a ocorrência de microplásticos no estuário de Santos, no litoral paulista

Estuário de Santos se apresenta como um dos locais com a mais alta concentração desses resíduos, já encontrados na praia, na água e no fundo do mar, do Pará ao Rio Grande do Sul
Domingos Zaparolli
Acosta brasileira está acumulando microplásticos, partículas plásticas com diâmetro inferior a 5 milímetros (mm), e nanoplásticos, que medem menos de 0,001 mm. É o que revela uma série de estudos feitos por diferentes grupos de pesquisa do país nos últimos anos. Uma investigação recente, realizada com apoio da FAPESP, estabeleceu o estuário de Santos, no litoral paulista, como um dos locais do mundo mais contaminados por microplásticos, numa comparação de amostras colhidas em 40 países. Com o objetivo de verificar a ocorrência desse resíduo no ambiente, os pesquisadores analisaram ostras e mexilhões, animais que filtram a água para se alimentar. Artigo publicado em maio na revista científica Science of the Total Environment revelou que foram detectadas, em média, 12 a 16 partículas plásticas por grama (g) de tecido dos moluscos, uma quantidade grande, considerando que os animais pesam em média 5 g.
Invisíveis a olho nu, micro e nanoplásticos não contaminam apenas a costa brasileira. Já foram detectados em rios, no solo onde são cultivados alimentos e no ar que respiramos (ver Pesquisa FAPESP nº 281). Absorvidos involuntariamente por seres vivos, chegam ao sistema digestivo, aos pulmões, à corrente sanguínea e à placenta de mulheres grávidas. Cientistas do mundo todo estão dedicados à tarefa de identificar o quanto esses resíduos estão dispersos na natureza e os riscos ao ambiente e à saúde de humanos e animais provocados por sua presença.
Não foi surpresa o nível abundante das partículas no estuário de Santos, cidade com elevada densidade urbana e que abriga o maior porto do país. O litoral santista recebe água de rios que atravessam diversas cidades, bem como efluen-
tes industriais e esgoto residencial levados por emissários submarinos da região.
A variedade de elementos geradores de microplásticos é enorme, mas o principal item encontrado no estuário paulista foi fibra têxtil sintética composta por poliamidas, elastanos e poliéster, possivelmente oriunda de fábricas de tecidos, confecções e também do desgaste gerado na lavagem doméstica de roupas.
“A água utilizada para lavar os tecidos é direcionada ao esgoto, que não é tratado, mas despejado no mar pelo emissário submarino”, observa o biólogo marinho Ítalo Braga de Castro, do Instituto do Mar da Universidade Federal de São Paulo (IMar-Unifesp) e coordenador do estudo, realizado pelo aluno Victor Vasques Ribeiro durante seu mestrado.
Os microplásticos podem ser divididos em dois grupos. Os primários, que já são fabricados em pequenas dimensões, como pellets, granulados milimétricos empregados pela indústria de transformação plástica, e os utilizados como esfoliante em cosméticos e pastas dentárias. O outro grupo são os microplásticos secundários, resultado da degradação de plásticos maiores em microfragmentos. Nesse caso, as origens são as mais diversas. Sacolas, tecidos, garrafas plásticas, bitucas de cigarro, pneus e isopor são alguns exemplos.
Em um dos primeiros estudos de abrangência nacional sobre a presença de microplásticos na costa brasileira, o biólogo marinho Tommaso Giarrizzo, professor visitante do Instituto de Ciências do Mar da Universidade Federal do Ceará (Labomar-UFC), colheu amostras de areia de praia em 22 localidades do Pará ao Rio Grande do Sul. Depois, quantificou e caracterizou os microplásticos encontrados de acordo com os materiais que os originaram e o perfil de ocupação
humana das localidades onde foram coletados, considerando a proximidade de centros urbanos, a frequência turística e a imediação de portos ou de indústrias da cadeia produtiva do petróleo. Um manuscrito com os principais achados encontra-se em fase de análise na Science of the Total Environment
“Nosso estudo tem a intenção de dar uma contribuição para a criação de um protocolo de diagnóstico, análise e monitoramento da presença de microplásticos no litoral do país”, diz Giarrizzo, que também já estudou a ocorrência de fragmentos plásticos nos rios amazônicos e na costa da Amazônia. Em artigo publicado em outubro de 2020 na revista científica Marine Pollution Bulletin, um grupo da Universidade Federal do Pará (UFPA), onde Giarrizzo foi professor visitante, relatou microplásticos em resíduos estomacais de arraias-brancas (Hypanus guttatus) pescadas na região.
No Ceará, o Labomar-UFC mapeou em 2020 os 573 quilômetros da costa cearense e detectou as partículas plásticas por todo o litoral. As maiores concentrações foram identificadas nas praias da capital, Fortaleza. “O microplástico é
leve e se dispersa com grande facilidade. Resíduos gerados em uma localidade circulam e logo chegam a outras e também às águas profundas. Seus efeitos para a vida marinha ainda estão sendo estudados”, diz o biólogo Marcelo de Oliveira Soares, do Labomar e coordenador da pesquisa. “O microplástico é uma das causas do branqueamento e da morte de corais, não só o aquecimento global, mas ainda precisamos entender qual é a participação de cada fator no problema.”
Há também estudos na costa fluminense, especificamente na baía de Guanabara. Em um artigo de 2016, publicado na revista Ocean & Coastal Management, pesquisadores do Instituto de Geociências da Universidade Federal Fluminense (UFF) concluíram que o nível desse micropoluente muda conforme a estação do ano. Durante o verão, as concentrações de microplásticos variaram de 12 a 1.300 partículas por metro quadrado (m2) nas praias, informaram os autores no trabalho, enquanto nos meses de
Conheça a origem dos microplásticos e o caminho até o oceano
n Microfibras de roupas sintéticas foram o principal item encontrado no estuário de Santos. Elas se soltam durante a lavagem e acabam chegando aos rios, de onde seguem para o mar
n Microesferas plásticas de cosméticos e de produtos de higiene seguem por efluentes até estações de tratamento de água, chegando à população
n Estações de tratamento de esgoto podem reter parte dos microplásticos, que ficam misturados no lodo, usado depois na agricultura
n O lixo plástico deixado na rua, em lixões e aterros sanitários é levado pela chuva até os rios
n O descarte inadequado de pellets nos processos industriais também é fonte de fragmentos plásticos
PRIMÁRIOS
Liberados no ambiente como pequenas partículas
n Pellets, esferas usadas como matéria-prima para a produção de plásticos maiores
n Microesferas adicionadas em cosméticos, pastas dentais, esfoliantes e em outros produtos de higiene
Resultam da degradação de objetos maiores
n Fibras oriundas de roupas sintéticas, carpetes e tapetes, e liberadas pelo atrito de pneus com o asfalto
n A perda acidental de contêineres e material plástico, como pellets, durante o transporte marítimo contribui para o problema
n Resíduos plásticos descartados por plataformas de petróleo podem transformar-se em microplásticos
n Redes de pesca perdidas ou abandonadas se fragmentam em partículas micrométricas
n Micropartículas liberadas pelos pneus dos carros são levadas pelo vento e pela chuva, depositando-se nos cursos de água das cidades
n Fragmentos de sacolas de supermercado, garrafas PET e redes de pesca
n Resíduos plásticos expostos às intempéries ambientais (raios UV, temperatura, umidade, ação das ondas)
n Restos de material empregado no cultivo agrícola, como estufas, telas de sombreamento e filmes para cobertura do solo
inverno, o nível caiu para 3 a 743 partículas por m2. Isso ocorre porque, no verão, estação das chuvas no Sudeste brasileiro, mais resíduos plásticos são lançados na baía de Guanabara levados pelas dezenas de rios e riachos que deságuam nela.
Outra investigação, conduzida por cientistas do Instituto de Biologia Marinha da Universidade Federal do Rio de Janeiro (UFRJ), mostrou que existem, em média, cinco partículas de microplásticos flutuantes por metro cúbico (m3), enquanto em sedimentos do fundo da baía de Guanabara o nível é de 26 mil partículas por m2 nas áreas estudadas. “A altíssima concentração de microplásticos no sedimento da baía de Guanabara, em comparação com a maioria dos estudos ao redor do mundo, sugere alto risco de contaminação para organismos bentônicos e peixes demersais, pois podem estar ingerindo microplásticos”, concluem os autores do estudo em artigo de 2019 na Marine Pollution Bulletin. Organismos bentônicos e peixes demersais vivem em contato constante com o fundo do mar.

“Um terceiro trabalho de nosso grupo, também na mesma baía, comparou a elevada concentração de itens plásticos com a densidade de organismos [de mesmas dimensões] presentes no sedimento, conhecidos como macrobentos. Encontramos mais fragmentos plásticos que poliquetas [tipo de verme aquático] e quantidades similares de microplásticos com crustáceos – ambos os animais são itens importantes na alimentação de peixes e siris”, destaca a bióloga Gisela Mandali de Figueiredo, que conduziu os estudos. “Logo, esses organismos têm grande risco de ingerir microplásticos ao se alimentar, por confundi-los com suas presas ou, incidentalmente, por serem abundantes no sedimento.”
Para o oceanólogo Fabian Sá, do Departamento de Oceanografia e Ecologia da Universidade Federal do Espírito Santo (Ufes), uma preocupação
associada a esses poluentes plásticos é seu efeito na cadeia alimentar marinha. Os zooplâctons, organismos na base da pirâmide, ingerem nanopartículas plásticas, diz Sá, e são consumidos por pequenos peixes e crustáceos. Estes, por sua vez, servem de alimento para animais marinhos maiores e também fazem parte da dieta humana.
“Hoje há uma grande redução da biodiversidade marinha no mundo, mas é muito difícil determinar o quanto dessa perda é gerada por microplásticos e quanto é resultado da ação de outros poluentes ou da combinação de efeitos desses diferentes contaminantes”, diz o pesquisador, destacando que diversos estudos evidenciam a perda de biodiversidade por poluição plástica. Sá coordenou a pesquisa com zooplâncton, executada durante o mestrado de sua aluna Jennifer Bernardino.
Além de gerar problemas para o aparelho digestivo quando ingerido, o microplástico pode causar intoxicação. Fuligens, hidrocarbonetos, partículas de metais tóxicos, pesticidas e outros poluentes aderem ao material quando entram em contato com ele. Com isso, os fragmentos passam a transportar esses poluentes.
As partículas plásticas ainda carregam em sua composição elementos químicos potencialmente nocivos quando adsorvidos. Isso porque a maioria dos plásticos é produzida com polímeros sintéticos, elaborados a partir de derivados de petróleo. Eles têm propriedades físicas distintas dependendo de suas funções e aplicações e, portanto, apresentam diferentes composições de insumos e aditivos químicos que geram características como rigidez, maleabilidade, flexibilidade, cor e resistência.
Uma substância química utilizada para conferir rigidez e transparência às formulações plásticas é
o bisfenol-A (BPA), considerado potencialmente cancerígeno em certas circunstâncias e, por isso mesmo, proibido de ser usado em vários países, inclusive no Brasil, na fabricação de mamadeiras. Outro exemplo é o ftalato, ingrediente empregado para tornar maleável o produto final, mas potencialmente prejudicial à saúde.
Especialistas advertem que os impactos de micro e nanoplásticos vão além dos efeitos fisiológicos gerados pela ingestão das partículas. A intoxicação pode ocorrer mesmo sem seu consumo direto, como efeito da lixiviação das partículas. Lixiviação é o processo de dissolução de um material pela ação da água. “Um pellet plástico que cai de um navio cargueiro no mar estará liberando toxinas em 24 horas”, alerta o biólogo marinho Caio Rodrigues Nobre, autor de um artigo sobre o tema publicado em 2015 na Marine Pollution Bulletin.
Nobre verificou que a decomposição de pellets plásticos no mar gera toxicidade suficiente para impactar o desenvolvimento embrionário do ouriço-do-mar (Lytechinus variegatus). “Algumas larvas de ouriço expostas aos pellets plásticos demoram para crescer, outras não crescem adequadamente e muitas nem mesmo se tornam ouriços”, relata o biólogo, destacando que, durante o estudo, isolou o efeito do pellet de outros fatores que poderiam afetar o desenvolvimento embrionário do ouriço. Segundo Nobre, os efeitos tóxicos dependem da composição de cada microplástico e não são idênticos nos diferentes organismos marinhos. Uma compreensão maior do problema exigirá que sejam realizados estudos sobre diversos elementos da fauna aquática.
Durante seu doutorado, com bolsa da FAPESP, Nobre estudou os efeitos de microplásticos que adsorvem o bactericida triclosan, ingrediente de cosméticos e produtos de higiene pessoal, sobre ostras Crassostrea e caranguejo-uçá (Ucides cordatus), como detalhado em artigos publicados nas revistas científicas Archives of Environmental Contamination and Toxicology, em 2020, e Chemosphere, em 2022. Adsorção é o processo pelo qual moléculas ou íons ficam retidos na superfície de um material por meio de interações químicas ou físicas.
“Nos dois casos, os efeitos contaminantes dos microplásticos expostos ao triclosan foram maiores do que a exposição a microplásticos comuns. Também foi possível verificar que os efeitos nocivos sobre as brânquias dos caranguejos foram significativamente maiores do que os observados nas ostras”, descreve o biólogo, atualmente em estágio de pós-doutorado no Instituto do Mar da Unifesp.
Em outra vertente de pesquisa, uma equipe do Instituto de Ciência e Tecnologia da Universidade Estadual Paulista (Unesp), em São José dos Campos, investigou a contaminação por microplásticos em piscinões da Grande São Paulo, reservatórios de detenção que recebem e regulam a vazão da água da chuva nas cidades. Uma avaliação em uma estrutura localizada no bairro paulistano de Aricanduva detectou 109 mil unidades de microplásticos por quilo (kg) de sedimentos recolhidos no leito do local. Do material encontrado, 53% eram resíduos de pneus. A borracha também gera micropartículas danosas ao ambiente.
Em uma comparação com amostras coletadas pelo grupo em um reservatório em Poá (SP), em 2020, a presença de microplásticos no bairro paulistano de Aricanduva é quase o dobro. Em Poá, a concentração do contaminante foi de 57,5 mil unidades por kg de resíduo. “Quanto mais densa a urbanização de uma região, maior a geração de microplásticos e, consequentemente, o impacto ambiental”, diz o engenheiro civil especializado em saneamento básico, Rodrigo Moruzzi, coordenador do estudo, publicado na revista Environmental Pollution em dezembro de 2022. A densidade demográfica de Poá, de 6 mil habitantes por quilômetro quadrado (km2), é pouco menos da metade da verificada no bairro de Aricanduva (12,8 mil habitantes por km2).
As águas pluviais que recebem e carregam microplásticos nas áreas urbanas das cidades não são destinadas para as estações de tratamento de esgoto, mas despejadas diretamente em rios. As águas dos rios se direcionam ao mar, mas muitas vezes abastecem estações de tratamento para o consumo da população. Essas estações, contudo, não foram dimensionadas para lidar com o microplástico.
“Não existem protocolos estabelecendo procedimentos para a retirada do material e os valores máximos de microplásticos permitidos na água potável”, constata Moruzzi. Mesmo as estações de tratamento de esgoto não têm protocolos definidos para a remoção de microplásticos dos efluentes. “O material não é alvo dos processos estabelecidos. É removido eventualmente por tecnologias que visam reter outros poluentes em suspensão”, afirma.
Moruzzi usa um argumento comum entre os pesquisadores da área para definir a dispersão das partículas plásticas na natureza. “Só não tem microplástico onde não se mede. Medindo, encontra-se”, salienta. Apesar da existência dos microplásticos ser conhecida desde os anos 1970, apenas nos últimos 15 anos se intensificaram as pesquisas científicas que buscam dimensionar o problema e entender os riscos gerados à vida. n
Estudos com culturas de diferentes tipos
celulares mostram que microplásticos podem causar lesões estruturais


e inflamatórias

Domingos Zaparolli

As pesquisas sobre os impactos dos microplásticos na saúde humana ainda são incipientes. Uma equipe do Departamento de Patologia da Faculdade de Medicina da Universidade de São Paulo (FM-USP), em um dos primeiros estudos nesse campo, detectou esses resíduos em pulmões humanos, como detalhado em artigo publicado na Journal of Hazardous Materials em 2021 (ver Pesquisa FAPESP no 305). “Os microplásticos estão no ar e é inevitável que sejam inalados. Vimos que eles chegam aos pulmões, mas ainda precisamos saber qual é o impacto na saúde”, diz a médica patologista Thais Mauad, coordenadora do estudo.

Segundo ela, pesquisas com culturas que simulam tecidos humanos indicam que os fragmentos plásticos causam lesões celulares e podem gerar inflamações, mas ainda não é possível determinar a quantidade de partículas necessárias para provocar uma lesão grave ou mesmo o impacto da absorção de aditivos químicos presentes nos plásticos.



Em janeiro de 2021, cientistas italianos da Universidade Politécnica de Marche, em Ancona, relataram na Environment International a presença de microplásticos na placenta de mulheres grávidas. Apesar de reconhecerem que os efeitos eram desconhecidos, os cientistas alertaram para o risco de malformação dos fetos, que ainda precisavam ser mais bem estudados. Em maio de 2022, pesquisadores da Universidade Vrije, em Amsterdã, nos Países Baixos, revelaram






Diferentes tipos de microplástico encontrados em peixes e no sedimento marinho da costa brasileira

que 77% dos doadores de sangue do país carregavam grande número de partículas plásticas no sangue.
Em um estudo mais recente, divulgado em julho na revista científica Environmental Science & Technology, uma equipe médica do Hospital Anzhen, de Pequim, capital da China, encontrou pela primeira vez microplásticos em corações humanos. Ao avaliar o músculo cardíaco de 15 pacientes que seriam submetidos a uma intervenção cirúrgica, os médicos encontraram nove diferentes tipos de plástico em cinco tecidos cardíacos distintos.

O Programa Ambiental das Nações Unidas (Pnuma) calcula que a humanidade produza por volta de 460 milhões de toneladas de plástico por ano e esse total tem potencial de triplicar até 2060. Boa parte do resíduo plástico acaba parando no mar – apenas o Brasil lança 3,44 milhões de toneladas de lixo plástico no litoral por ano (ver Pesquisa FAPESP nº 321). De acordo com os especialistas ouvidos por Pesquisa FAPESP, é necessária uma solução global para o problema. Por ora, adotar a chamada regra dos 3R da sustentabilidade – reduzir, reutilizar e reciclar –, apesar de ser considerada por eles como apenas um paliativo, já seria um avanço. As atenções estão voltadas para o Tratado Global contra a Poluição Plástica, que a Organização das Nações Unidas (ONU) pretende concluir com o apoio de 175 países até o final de 2024. n

Os diversos componentes das baterias de lítio; e o óxido metálico recuperado na forma de um pó preto

Pesquisadores desenvolvem técnicas para separar e reciclar metais contidos em baterias usadas em smartphones, notebooks e veículos elétricos
Domingos Zaparolli
Essenciais para promover a mobilidade elétrica, as baterias de íons-lítio conseguem concentrar muita energia em um espaço reduzido e pesam bem menos do que modelos que utilizam outros materiais. Essas duas características – alta densidade energética e leveza – fazem com que sejam as mais utilizadas não apenas em veículos elétricos, mas também em smartphones e notebooks. Ao chegarem ao fim da vida útil e serem descartadas, contudo, as baterias de lítio transformam-se em um problema ambiental. Para contornar essa situação, grupos de pesquisa em todo o mundo estudam formas de reciclar e reaproveitar os metais que compõem esses módulos, como cobalto, lítio, cobre, grafite e alumínio. No Brasil, um dos trabalhos mais avançados é conduzido no Center for Advanced and Sustainable Technologies (Cast), da Faculdade de Engenharia da Universidade Estadual Paulista (Unesp) em São João da Boa Vista (SP).
“Nossas técnicas possibilitam a recuperação e o reaproveitamento de materiais com potencial tóxico e estimulam a economia circular. Com isso, é possível reduzir o impacto ambiental que seria gerado por novas atividades minerais”, destaca o engenheiro ambiental José Augusto de Oliveira, coordenador do Cast. As metodologias em desenvolvimento recorrem a processos de hidrometalurgia, que preveem a lixiviação, ou seja, a separação dos metais contidos nas baterias por sua contínua dissolução em meio aquoso.
Uma bateria de íons-lítio é composta por várias pequenas pilhas, chamadas de células, que formam um pacote maior, ou pack, no jargão dos engenheiros (ver Pesquisa FAPESP no 261). A primeira etapa de qualquer processo de reciclagem ou reaproveitamento de baterias é o desmembra-
mento do pack. O procedimento mais tradicional prevê a detecção das células que ainda estão aptas a formar um novo pacote, dando origem a uma bateria de segunda vida. As células que chegaram ao fim de sua vida útil são encaminhadas para o descarte. São essas células o foco do trabalho dos pesquisadores do Cast.
A sequência do processo desenvolvido na Unesp, conforme descrição de Oliveira, envolve a separação de todos os componentes das células, como os plásticos contidos no invólucro e usados como isolante entre a estrutura metálica e o material interno. Esse último é constituído pelo cátodo (polo positivo da bateria), uma lâmina de alumínio onde estão os óxidos de lítio e de cobalto, pelo ânodo (polo negativo), uma lâmina de cobre envolvida em grafite, e por uma membrana plástica que faz a separação entre os dois polos. Por estar em contato com ambos, essa membrana pode conter grafite e óxidos metálicos.
O desmanche da célula é feito manualmente, com o auxílio de máquinas para cortar. As folhas metálicas obtidas são submetidas a um banho com uma solução química aquosa criada para remover o cobre e o alumínio, que já saem do processo prontos para a reutilização. Já o grafite e os óxidos de lítio e de cobalto com alto grau de pureza são obtidos após a filtração das respectivas soluções. O processamento da membrana exige, igualmente, uma filtração e uma etapa posterior de separação para a purificação dos óxidos metálicos presentes nela.
“Os reagentes químicos utilizados são de fontes orgânicas. Foram escolhidos para minimizar impactos ambientais e maximizar o benefício econômico e a segurança laboral”, explica a química Mirian Paula dos Santos, pesquisadora responsável pelo processo de extração dos óxidos metálicos. “A tecnologia está sendo aprimo-
Campo de mineração de lítio no deserto do Atacama, no Chile

rada. Só no final do processo, vamos conseguir calcular os impactos ambientais e a viabilidade econômica”, ressalta. Por ora, diz ela, a técnica está validada em escala laboratorial.
Opotencial econômico da metodologia, de acordo com Oliveira, é favorável. “Estudos iniciais indicam que a venda do óxido de lítio gera recursos suficientes para cobrir os gastos da reciclagem”, diz. A etapa atual de desenvolvimento da técnica, que gerou um depósito de patente no Instituto Nacional da Propriedade Industrial (INPI) em 2020, proporciona uma taxa de recuperação de 90% do óxido de lítio com 98% de pureza; quando contaminado com grafite, a taxa é de 50% de pureza. Os componentes restantes da bateria são totalmente recuperáveis, de acordo com artigo publicado em 2021 na revista científica Resources, Conservation and Recycling
Esses resultados permitiram à Unesp fechar um acordo de desenvolvimento tecnológico e de licenciamento de uma versão de seu processo de reciclagem, com novos reagentes, com uma empresa brasileira com atuação global. Em um primeiro momento, o objetivo é utilizar a tecnologia para reciclar as baterias dos veículos que ela produz. Posteriormente, antecipa Oliveira, a companhia, cujo nome não pode ser revelado por questões contratuais, avalia com a Unesp uma estratégia comercial para viabilizar a oferta do serviço de reciclagem de forma abrangente a terceiros. A cooperação entre a universidade e a multinacio -
nal conta com apoio da FAPESP por meio do programa Pesquisa em Parceria para Inovação Tecnológica (Pite).
Outra técnica para reciclagem das baterias de íons-lítio em desenvolvimento no Cast segue uma rota não convencional, que utiliza água em condição supercrítica como solvente para recuperar os óxidos metálicos. “Para isso, a água deve ser submetida a uma temperatura superior a 374 graus Celsius [oC] e a uma pressão de 240 atmosferas [atm]. Sob essas condições, já não há mais diferença entre seu estado líquido e gasoso”, descreve o engenheiro químico Lúcio Cardozo Filho, responsável pelo projeto de pesquisa. “A água supercrítica, submetida a temperatura e pressão extremas, tem uma reatividade adequada para processar, tratar e extrair compostos inorgânicos, como os óxidos metálicos encontrados nas baterias de lítio.”
Embora levar a água à condição supercrítica não seja trivial, o fluido utilizado, segundo Cardozo, não precisa ser de boa qualidade, podendo ser água de reúso, e o processo não emprega nenhum reagente químico adicional para a extração dos óxidos metálicos. “O sucesso na separação dos metais supera 98%”, informa o engenheiro. O resultado alcançado é uma mistura de óxidos metálicos, conhecido como black mass, que ainda precisará passar por um processo de separação e purificação comumente usado na hidrometalurgia convencional. “Nosso próximo desafio é conseguir recursos adicionais para escalar o processo”, antecipa Cardozo Filho.
A reciclagem de baterias de íons-lítio é um processo mais sustentável e econômico do que a reti-
rada dos minerais da natureza. No caso do lítio, são necessários 100 quilos (kg) do mineral bruto para produzir 1,6 kg de lítio. Já um processo de reciclagem é capaz de recuperar 7 kg de óxido de lítio em cada 100 kg de bateria. A extração do minério tem alto impacto ambiental pelo uso intensivo de água, além de o refino ser eletrointensivo, com os materiais rochosos aquecidos a temperaturas acima de 1.000 ºC, o que consome muita energia.
A demanda global por armazenamento em baterias de lítio deve crescer de 700 gigawatts-hora (GWh) em 2022 para 4,7 mil GWh em 2030, de acordo com estudo da consultoria McKinsey. O aumento da demanda, dizem especialistas, faz com que a recuperação e o reaproveitamento dos materiais metálicos que formam essas baterias se imponham.
O setor automotivo é o principal destino das baterias de lítio, com cerca de 80% da produção sendo direcionada às montadoras. Uma bateria veicular típica para veículos elétricos pesa mais de 200 kg e tem vida útil entre 8 e 10 anos. A Agência Internacional de Energia (AIE) estima que a produção de lítio precisará crescer quase dez vezes até 2050 para atender ao aumento da demanda mundial do produto.

“A produção de insumos corre o risco de não acompanhar a crescente demanda global. O resultado é que poderemos ter escassez de baterias até 2030”, alerta o físico Hudson Zanin, da Faculdade de Engenharia Elétrica e Computação da Universidade Estadual de Campinas (Feec-Unicamp), coordenador de uma pesquisa que visa desenvolver uma bateria à base de sódio (ver Pesquisa FAPESP no 329). “A reciclagem e a integração progressiva dos materiais recuperados nas novas baterias oferecem vantagens tanto do ponto de vista ambiental quanto econômico, garantindo o suprimento de insumos”, afirma.
Zanin explica que os principais processos de reciclagem empregados no mundo são os pirometalúrgicos e os hidrometalúrgicos, que, segundo o pesquisador, alcançam uma eficiência superior a 80%. Na pirometalurgia, a incineração do material pode liberar gases tóxicos, o que é indesejável.
Já os processos de hidrometalurgia, apesar de consumirem água, poluem menos e demandam menos energia. “O gasto de água é bem menor do que o da mineração do lítio. Nos processos de reciclagem por hidrometalurgia, utiliza-se em torno de 5 litros [L] de água para a obtenção de 100 gramas [g] de sal de lítio. Na mineração, o consumo de água pode variar de 50 a 90 L para se obter 100 g de carbonato de lítio”, informa Oliveira.
Aremanufatura de baterias de lítio em novos packs com o aproveitamento das células que perderam rendimento, mas ainda não chegaram ao fim de seu ciclo de vida, é foco de um projeto que o centro de inovação CPQD desenvolve em Campinas (SP) em parceria com a CPFL Energia e a BYD, fabricante chinesa de baterias e veículos elétricos. Como explica o engenheiro Aristides Ferreira, gerente de soluções de sistemas de energia do CPQD, as baterias utilizadas pelos veículos elétricos são tracionárias, ou seja, são usadas para a tração do veículo e, para isso, são submetidas a condições operacionais intensas. Após um período que varia de 8 a 10 anos, dependendo do uso, perdem capacidade de armazenar energia e gerar a tração necessária para movimentar um veículo. Mas ainda podem ser úteis em aplicações menos exigentes, como baterias estacionárias, sistemas de backup e módulos de armazenamento de energia de fontes de geração solar e eólica, que são intermitentes. Permitem, por exemplo, acumular a energia gerada durante o dia em um painel solar fotovoltaico para o aproveitamento noturno ou a energia de fonte eólica quando não há vento.
O projeto do CPQD envolveu a criação de algoritmos capazes de verificar a qualidade das células retiradas de uma bateria veicular de íons-lítio e determinar sua longevidade, sem a necessidade de longos ensaios laboratoriais, facilitando a seleção das melhores células em uma segunda vida em baterias estacionárias. O CPQD já desenvolveu um protótipo de bateria de segunda vida, que se encontra em fase de testes em um laboratório que possui planta de geração de energia fotovoltaica na Unicamp. n
Um sensor descartável de baixo custo e uso simples, feito de papelão e contendo nanopartículas de ouro, poderá vir a ser uma ferramenta útil para monitorar a qualidade da água consumida pela população. Em fase final de desenvolvimento, o dispositivo analítico foi projetado pela equipe do químico Thiago Regis Longo Cesar da Paixão, do Instituto de Química da Universidade de São Paulo (IQ-USP) e coordenador do Laboratório de Línguas Eletrônicas e Sensores Químicos da mesma instituição. A pesquisa, apoiada pela FAPESP, resultou em um artigo publicado no início deste ano na revista científica Sensors & Diagnostics. Um pedido de patente do processo de fabricação está sendo elaborado pelo grupo.
“Produzir sensores baratos que possam estar espalhados pelo Brasil possibilita o monitoramento em tempo real da água servida à população. Os dados colhidos podem orientar a criação de políticas públicas por agentes governamentais e ajudar a tomada de decisão das empresas de tratamento de água”, destaca Paixão. O custo estimado do sensor, sujeito à confirmação, é de R$ 0,50.
Sensor de papelão modificado com partículas de ouro poderá ajudar a monitorar a qualidade da água consumida pela população

Yuri Vasconcelos
O processo de fabricação do dispositivo, um pequeno retângulo de papelão medindo 15 milímetros (mm) de largura por 20 mm de comprimento e 1 mm de espessura, é praticamente isento de reagentes químicos, comumente utilizados na fabricação de sensores, e quase totalmente automatizado. Além do papelão, que pode ser proveniente de um processo de reciclagem, os pesquisadores usaram cola adesiva, spray impermeabilizante e um pequeno volume de solução de ouro (30 microgramas). Um laser de dióxido de carbono (CO2) aplicado sobre o papelão é responsável por criar as trilhas condutoras, a base dos eletrodos de detecção. A solução de ouro é adicionada às trilhas e, em seguida, uma nova aplicação de laser sintetiza as nanopartículas de ouro (ver infográfico ao lado).
“As nanopartículas são responsáveis por melhorar o desempenho do dispositivo”, explica o pesquisador. “O sensor realiza medidas de corrente elétrica oriunda de uma reação eletroquímica que ocorre na superfície condutora ao se aplicar um potencial elétrico. Quanto maior a concentração da substância química que se quer identificar na amostra de água colocada no sensor, maior será a corrente gerada.” O potencial elétrico que deve ser aplicado ao
Laser de dióxido de carbono incide sobre o papelão criando uma trilha condutora que dará origem aos eletrodos do sensorProcesso é quase todo automatizado e leva por volta de 5 minutos para ser concluído
PREPARAÇÃO DO PAPELÃO
Duas folhas de papel kraft são unidas com cola e colocadas em uma prensa térmica. Um spray impermeável de verniz branco é aplicado para evitar a absorção da solução da amostra pelo papel durante a realização das medidas
CRIAÇÃO DO ELETRODO DE DETECÇÃO
Laser de dióxido de carbono aplicado no papel converte a celulose em carbono e cria trilha condutora que dá origem a três eletrodos de detecção. Adiciona-se uma solução de ouro à trilha
eletrodo central para fazer o dispositivo funcionar é de -0,2 volt (V), inferior ao de uma pilha pequena do tipo AAA (1,5 V).
O fato de ser produzido sem manipulação humana confere vantagens. “Muitas vezes temos em laboratório uma série de etapas manuais para a elaboração de sensores. Elas fazem com que os dispositivos não tenham muita reprodutibilidade. Quando recorremos a máquinas, como a que emite o laser, evitamos essa intervenção artesanal no processo de fabricação do dispositivo”, conta Paixão.
O químico Wendell Karlos Tomazelli Coltro, diretor do Instituto de Química da Universidade Federal de Goiás (IQ-UFG), que não participou do estudo, concorda. “A tecnologia baseada no uso do laser é muito atrativa por permitir escalar a produção com alta reprodutibilidade”, avalia. Para Coltro, o dispositivo apresenta elevado nível de inovação. “A equipe da USP foi pioneira na proposição do emprego do laser para produzir sensores em papelão. O uso desse material torna o dispositivo sustentável e permite que venha a ser fabricado em qualquer lugar do mundo”, diz.
Nos ensaios em laboratório para avaliar o desempenho do sensor, os pesquisadores usaram como prova de conceito o hipoclorito de sódio. Popularmente
Nova aplicação de laser é feita para sintetizar as nanopartículas de ouro. Nesse processo os íons de ouro são convertidos em ouro metálico a partir da energia do laser
conhecida como cloro, a substância é usada como desinfetante em águas de piscina. Em altas concentrações, pode ser prejudicial à saúde. O nível máximo de cloro livre permitido pela Organização Mundial da Saúde (OMS) em piscinas é de 3 a 5 partes por milhão (ppm). No estudo feito no Instituto de Química, segundo o artigo publicado na Sensors & Diagnostics, foi possível detectar até 0,50 ppm de hipoclorito de sódio na água.
Para identificar outras espécies químicas em amostras de água, a plataforma teria que ser adaptada – o termo espécie química refere-se às diversas formas que as substâncias químicas se encontram na natureza, como átomos, moléculas, íons. “Já projetamos sensores para medir metais tóxicos, pesticidas e fármacos, além de outras espécies de interesse ambiental, como nitrito e nitrato”, diz o pesquisador da USP. Para cada substância seria preciso projetar um sensor específico, mas há a possibilidade de montar um arranjo de sensores para realizar a detecção simultânea de várias substâncias.
Por enquanto, apenas o sensor foi criado, mas os pesquisadores da USP dizem
IMPERMEABILIZAÇÃO DA SUPERFÍCIE
Uma cola de silicone é depositada na superfície do sensor a fim de criar uma barreira para confinar a solução da amostra de água durante o processo de sensoriamento
ter capacidade para projetar o sistema completo, o que inclui o dispositivo que faz a leitura dos dados, ainda sem custo estimado. É possível também usar um modelo de leitor portátil disponível no mercado – algo parecido com o que se faz hoje com as fitas para medir os níveis de glicose no sangue, que são inseridas em instrumentos chamados glicosímetros.
O próximo passo da pesquisa é criar um plano-piloto para testagem do sensor em larga escala, na residência das pessoas, por usuários não treinados. O ensaio com a população ajudará no aperfeiçoamento do dispositivo. Numa etapa posterior, o grupo pretende encontrar uma empresa que se interesse por fazer a produção comercial do sensor.
“Já há conversas em andamento”, revela Paixão, destacando que a busca por sensores de papelão ou arranjos desses dispositivos para monitorar a qualidade da água em tempo real não ocorre apenas no Brasil. As startups LAIIER, em Londres, na Inglaterra, iFlux, em Niel, na Bélgica, e OmniVis, em São Francisco, nos Estados Unidos, informa o pesquisador, também trabalham no projeto de aparelhos desse tipo. n
projeto e o artigo científico consultados para esta reportagem estão listados na versão on-line.
Em 2020, acidente com cinco motocicletas e outros 17 veículos em São José dos Pinhais (PR) deixou ao menos oito pessoas mortas e mais de 20 feridas

Acidentes com motociclistas aumentam o número de mortes no trânsito no Brasil, exigindo a adoção de melhorias em estradas e a criação de campanhas educativas
Christina QueirozSinistros com transporte terrestre são a principal causa de mortalidade juvenil na América Latina, segundo a Organização das Nações Unidas (ONU). No Brasil, 392 mil pessoas morreram em decorrência de acidentes de trânsito entre 2010 e 2019, um aumento de 13,5% em comparação com a década anterior, conforme relatório do Instituto de Pesquisa Econômica Aplicada (Ipea), divulgado no começo de agosto. Excesso de velocidade, consumo de bebidas alcóolicas e distrações ao volante, especialmente o uso de celulares, são alguns dos principais fatores de risco, que têm afetado de forma mais intensa homens e usuários de motocicletas. Para ampliar a segurança viária no país, especialistas defendem que é preciso realizar investimentos combinados tanto em infraestrutura de vias e mecanismos de fiscalização, como também na criação de campanhas para educar a população em relação ao cumprimento de leis e a adoção de comportamentos adequados no trânsito.
Cerca de 1,35 milhão de pessoas morrem anualmente no mundo por causa de acidentes viários. Quarenta e nove por cento são pedestres, ciclistas e motociclistas, de acordo com o sociólogo Victor Pavarino, oficial de Segurança Viária e Prevenção de Lesões da Organização Pan-americana da Saúde (Opas) e da Organização Mundial da Saúde (OMS). “Em nível mundial, mais de 90% do total de mortes no trânsito ocorre em países de baixa e média renda, como são os casos de nações latino-americanas”, destaca. Dados da ONU mostram, ainda, que países da região registram
17 óbitos por acidente de trânsito a cada 100 mil
habitantes, valor que representa quase o dobro da média europeia, de nove por 100 mil habitantes. No mundo, um dos principais fatores de risco à insegurança viária é o excesso de velocidade. “Cada aumento de 1% na velocidade média produz um crescimento de 4% no risco de acidente fatal e um avanço de 3% no risco de acidente grave”, afirma Pavarino. Segundo ele, o risco de morte para pedestres atingidos frontalmente por automóveis também aumenta, sendo 4,5 vezes mais alto quando a velocidade passa de 50 quilômetros por hora (km/h) para 65 km/h. “Quando pensamos no choque entre carros, o risco de morte para os ocupantes é de 85% quando o veículo está a 65 km/h.” Outro elemento complicador é dirigir alcoolizado ou sob o efeito de substâncias psicoativas. “Mesmo baixos níveis de concentração de álcool no sangue do motorista já aumentam o risco de sinistros, enquanto o risco de acidente fatal para quem consumiu anfetaminas é cerca de cinco vezes mais alto se comparado com quem não fez uso desse tipo de substância”, compara o sociólogo. Coordenado pela farmacêutica e bioquímica Vilma Leyton, da Universidade de São Paulo (USP), o projeto concluído em 2019 investigou o uso de drogas, como cocaína, maconha e anfetaminas, entre motoristas de caminhão e motociclistas parados por operações policiais. O estudo analisou amostras de saliva de 202 usuários de motos na cidade de São Paulo, sendo que 12,9% do total apresentou resultado positivo para uso de maconha e cocaína e mais da metade dos motociclistas testou positivo apenas para o consumo de maconha. Participaram do levantamento 504 caminhoneiros que circulavam em rodovias federais do estado de São Paulo. “Detectamos que 6% dos motoristas de caminhão tinham feito uso de alguma droga – 3,8% de cocaína e 1,4% de anfeta-

minas. A ocorrência de resultados positivos para o consumo de maconha foi pequena, de apenas um caminhoneiro”, conta Leyton. Na avaliação da pesquisadora, o uso de estimulantes por motoristas de caminhão ocorre por causa de longas jornadas de trabalho, prazos curtos para entrega de mercadorias, falta de locais adequados para descanso, entre outras dificuldades. “Melhorias nas condições de trabalho, mecanismos de fiscalização e campanhas de conscientização sobre os efeitos nocivos de drogas são estratégias fundamentais para aumentar a segurança viária no país”, propõe a pesquisadora.
No Brasil, a Lei nº 11.705, de 2008, conhecida como Lei Seca, determina que conduzir veículos com qualquer teor de álcool no organismo é infração de trânsito gravíssima. Além da multa de R$ 2.934,70, o motorista penalizado tem a Carteira Nacional de Habilitação (CNH) suspensa por 12 meses. Criada a partir de diretrizes da Associação Brasileira de Medicina do Tráfego (Abramet), a lei salvou 50 mil pessoas desde sua promulgação, de acordo com o médico Flávio Adura, diretor científico da instituição. Antes de 2008, a legislação brasileira autorizava a condução de veículos

com até 0,6 grama de álcool por litro no sangue, o equivalente a quatro ou cinco doses de bebida. “Estudos desenvolvidos pela Abramet mostraram que não há limites seguros para o consumo de álcool e a condução de veículos”, afirma Adura (ver Pesquisa FAPESP nº 327). No final de 2020, a socióloga Marina Kohler Harkot, que fazia doutorado na USP sobre mobilidade urbana, andava de bicicleta e foi atropelada por um motorista acusado de dirigir alcoolizado em alta velocidade. Ele fugiu sem prestar socorro e Harkot faleceu.
Oartigo 64 do Código de Trânsito Brasileiro (CTB), criado pela Lei nº 14.071/20, que passou a vigorar em 2021, determina que crianças com idade inferior a 10 anos e com menos de 1,45 m de altura devem ser transportadas em bancos traseiros em dispositivos de retenção adequados à sua idade, peso e altura. “Esse artigo aperfeiçoou a Resolução nº 277/2008 do Conselho Nacional de Trânsito [Contran]. Ambos permitiram evitar 28 mil mortes de crianças entre 2008 e 2023”, estima o médico a partir de levantamentos desenvolvidos pela Abramet no último ano. Adura, também pesquisador do Instituto de Estudos Avançados da USP, conta que, atualmente, a Abramet realiza estudos para mostrar a importância do uso de capacetes por ciclistas. Em sua avaliação, o uso desse equipamento de proteção por usuários de bicicleta deveria ser obrigatório. “Há 15 anos, a taxa de óbitos de ciclistas em sinistros viários era insignificante nos registros do Sistema Único de Saúde [SUS] e, hoje, respondem por 3,5% do total.”
“Comportamentos arriscados e falta de proteção agravam as consequências de acidentes de
trânsito, que causam internações e tratamentos prolongados”, alerta o médico. “Isso afeta de forma intensa a integridade física de pessoas jovens e traz impactos financeiros significativos para o SUS.” Estudo elaborado pelo Ipea em agosto corrobora a afirmação de Adura. Segundo o documento, um terço dos óbitos decorrentes de acidentes viários no Brasil envolve pessoas com até 15 anos e cerca de dois terços do total são de indivíduos com menos de 50 anos. Segundo o engenheiro civil Carlos Henrique Ribeiro de Carvalho, um dos autores do estudo, a pesquisa teve como base dados do Ministério da Saúde. Pelo critério do órgão, mortes ocorridas até 30 dias depois do sinistro são computadas como acidente por transporte terrestre. Em 2019, esse quadro provocou um prejuízo de cerca de R$ 320 milhões para o SUS (ver gráfico na página 79). Pesquisa coordenada pela engenheira civil Ana Paula Camargo Larocca, da Escola de Engenharia de São Carlos (EESC) da USP, mostrou que homens de 18 a 25 anos apresentam risco 42% mais alto de se expor em manobras de ultrapassagem em pista simples, considerado o tipo de rodovia mais perigoso, se comparados a homens mais velhos ou mulheres. Concluído em 2019 com financiamento da FAPESP, o estudo foi feito a partir de análises do comportamento de 100 voluntários de diferentes faixas etárias e com habilitação, que utilizaram um simulador de direção capaz de reproduzir estradas virtualmente de forma realista. No trabalho, foi projetada uma rodovia de pista simples com mão dupla e os motoristas precisavam fazer ultrapassagens em momentos que considerassem adequados. “Jovens do sexo masculino se arriscaram mais, colando na traseira de outros veículos e fazendo tentativas perigosas de ultrapassagem”, comenta a engenheira. Atual-
mente, Larocca coordena outro estudo, também financiado pela FAPESP, para identificar problemas na infraestrutura viária por meio do uso de simulador de direção. Prevista para ser concluída em 2024, a pesquisa está sendo realizada em parceria com uma concessionária de rodovias, identificando lugares das vias em que é preciso mudar a sinalização e o revestimento do pavimento. “A concessionária adotou as mudanças recomendadas pela pesquisa até agora e, entre 2021 e 2022, reduziu os acidentes fatais em 18%”, conta a pesquisadora.
Se as mortes por sinistros de trânsito foram agravadas em todas as modalidades de transporte, entre usuários de motocicleta a situação é alarmante. De 2010 a 2019, os óbitos de motociclistas totalizaram 120 mil vítimas fatais, em comparação com o número de 60 mil registrado na década anterior, segundo levantamento do Ipea, desenvolvido a partir de informações do SUS. Acidentes com motocicletas respondem hoje por 44% das mortes no trânsito de pessoas entre 15 e 29 anos, enquanto atropelamentos são responsáveis pela maior parte dos óbitos de indivíduos com mais de 70 anos. “Em 2021, das 33,8 mil mortes no trânsito, 11,9 mil foram de motociclistas”, enumera o engenheiro civil Jorge Tiago Bastos, da Universidade Federal do Paraná (UFPR). Segundo o pesquisador, esse número está relacionado, entre outros motivos, ao crescimento da frota de motocicletas registrado nos últimos 25 anos, à expansão dos serviços prestados por esse tipo de condutor e às condições laborais precárias a que estão submetidos, com jornadas extensas e a necessidade de fazer um número grande de entregas.
Empenhado em identificar o papel do comportamento humano no panorama nacional de

acidentes de trânsito, Bastos realiza no Paraná estudo observacional para analisar como motoristas reagem em diferentes situações ao volante. Por meio de veículos equipados com câmeras e sistemas de geoprocessamento (GPS), o pesquisador detectou que os condutores costumam aguardar momentos de redução de velocidade, como ocorre em semáforos e locais de interação com pedestres, para enviar mensagens de texto pelo celular. “Porém, por outro lado, eles não esperam reduzir a velocidade para enviar mensagens de voz ou fazer ligações, sendo que esse tipo de atividade também distrai a atenção”, comenta.

Adura concorda que o uso de celular na direção foi um fator preponderante para a piora da segurança viária no Brasil em 2021, quando as mortes em decorrência de sinistros de trânsito aumentaram 3,4% em comparação com 2020. Em sintonia com Bastos e Adura, Pavarino, da Opas-OMS, informa que esse tipo de distração é preocupação crescente para a segurança no trânsito em todo o mundo. “Condutores que utilizam celulares enquanto dirigem têm cerca de quatro vezes mais risco de se acidentarem”, diz Pavarino. “O uso do telefone diminui os reflexos do motorista, bem como aumenta sua dificuldade de manter o veículo na pista correta e respeitar distâncias de segurança.”
Ainda em relação à pesquisa de Bastos, da UFPR, foi constatado que episódios de excesso de velocidade são mais intensos em vias locais, justamente em áreas com maior presença de pedestres e ciclistas. Para o engenheiro, esse tipo de comportamento arriscado poderia ser evitado por meio de investimentos em educação para o trânsito, que estão previstos no Código de Trânsito Brasileiro (CTB), a Lei nº 9.503. Sancionada em 1997, a legislação define atribuições de autoridades de trânsito e estabelece normas de conduta, além de determinar infrações, crimes e penalidades para motoristas. “Cidades e estados não têm colocado em prática projetos de educação para o trânsito, apesar de previstos na legislação”, alerta o pesquisador. O Observatório Nacional de Segurança Viária (ONSV), por exemplo, tem material paradidático, aprovado em 2017 pelo Ministério da Educação (MEC), voltado para uso em sala de aula de alunos do 1º ao 9º ano do ensino fundamental. Pedro Borges, responsável pela área de Mobilidade Segura do ONSV, explica que os documentos se apoiam na ideia de que a educação no trânsito é um princípio de cidadania. “A proposta é fazer com que a população compreenda que acidentes podem ser evitados, mas isso depende de nossa atitude nas vias”, observa.
A respeito da legislação, Bastos recorda que a Década de Ação pela Segurança no Trânsito 2011-2020, criada pela ONU para reduzir pela metade a mortalidade no trânsito, teve como um de seus efeitos no Brasil a criação do Plano Nacional de
Redução de Mortes e Lesões no Trânsito (Pnatrans), a Lei nº 13.614, de 2018. Como a meta de redução não foi atingida em grande parte do mundo, a ONU renovou a iniciativa em 2021. “Um dos pilares dessa nova fase é o conceito de sistemas seguros, abordagem integrada que reconhece o trânsito como um ambiente complexo, estabelecendo que é preciso projetar estradas prevendo a ocorrência de erros humanos e minimizando as consequências de acidentes”, explica o pesquisador da UFPR.
Com tese de doutorado defendida na área de engenharia de transportes em 2019, Cintia Isabel de Campos Roque Guerrero, da Faculdade de Ciência e Tecnologia da Universidade Federal de Goiás (UFG), explica que, no passado, 95% das ocorrências eram atribuídas a falhas humanas. “A abordagem de sistemas seguros, que ganhou protagonismo em estudos de segurança viária na última década, prevê que é inadmissível que pessoas paguem por erros com a própria vida”, explica. Segundo a pesquisadora, essa proposta tem motivado engenheiros a desenvolver tecnologias para aumentar a segurança de veículos, incluindo alertas de fadiga quando identificam que o condutor está piscando muito ou reduz a pressão sobre o volante; emissão de avisos sonoros quando o motorista muda de faixa sem dar pisca-
Moto na ciclofaixa em São Paulo: de 2010 a 2019, os óbitos de motociclistas totalizaram 20 mil vítimas no país
De 2010 a 2019, foram registrados 1,7 milhão de internações hospitalares e despesas de cerca de R$ 3,8 bilhões
-alerta; sensores para ampliar a visão noturna, em pontos cegos ou para detectar redução abrupta de velocidade de carros à frente, entre outros. Esses sistemas já vêm embutidos em alguns carros de alto padrão e o desafio é ampliar sua incorporação para veículos de todas as faixas de preço. Além dessas diretrizes, outras recomendações da ONU abarcam a necessidade de países melhorarem a estrutura de atendimento às vítimas, priorizar a circulação de ciclistas e pedestres em vias, adotar políticas de redução de velocidade, desestimular o uso de veículos particulares em áreas urbanas de muita densidade e fornecer treinamentos em primeiros-socorros para operadores leigos, como motoristas de táxi ou de transporte público. Para além de recomendações gerais, a engenheira civil Magaly Romão, da Faculdade de Tecnologia de Jaú (Fatec-Jahu), no interior paulista, sustenta que cada município deve desenvolver planos alinhados às suas características e necessidades. Nesse sentido, a pesquisadora participou de estudo, coordenado pelo engenheiro civil Antonio Clóvis Pinto Ferraz, da EESC-USP, que apresenta dados comparativos de áreas associadas ao nível de desenvolvimento socioeconômico de municípios paulistas com mais de 100 mil habitantes, entre eles de mobilidade urbana. “Cidades do mesmo porte e com frotas semelhantes podem apresentar níveis distintos de acidentalidade, dado que nos permite desconstruir a ideia de que municípios grandes, com muita circulação de carros e pessoas, necessariamente são os mais inseguros no trânsito”, comenta. Segundo Romão, mais do que o porte de cidades e o tamanho de frotas, a insegurança viária está associada a baixos índices de desenvolvimento e de renda per capita. “É preciso municipalizar as estratégias para redução de sinistros, entendendo as especificidades de cada contexto”, defende.
Em 2017, Romão desenvolveu projeto para a prefeitura de Rio Verde (GO), com o objetivo de reduzir acidentes e melhorar a mobilidade urbana. Realizado entre 2016 e 2017, a ideia se apoiou na reforma e na mudança do paisagismo da cidade, reorganização de placas e sinalizações de trânsito, como faixas de pedestres, colocação de estruturas para ampliar a acessibilidade em ruas e calçadas. Além disso, foram elaboradas medidas educativas, como cursos voltados a gestores e à comunidade e campanhas de conscientização. Devido a essa iniciativa, entre 2017 e 2019, a cidade conseguiu reduzir as vítimas fatais de sinistros viários em 64% e a prefeitura registrou uma economia de R$ 80 milhões em gastos hospitalares e danos patrimoniais. “Nas últimas décadas, o Brasil teve uma grande ampliação de sua frota, incentivada por políticas que facilitaram o acesso a crédito para a aquisição de veículos de transporte individual, sem adotar contrapartidas envolvendo campanhas de educação. Esse cenário agravou os níveis de acidentalidade”, considera a pesquisadora.
Ainda de acordo com Romão, nos últimos anos, problemas de engenharia em estradas deixaram de ser a causa principal da insegurança viária, de forma que hoje é preciso trabalhar com mais intensidade questões culturais e comportamentais. “Isso significa que investimentos para reformar estradas devem ser acompanhados de campanhas de conscientização. Caso contrário, em vias muito modernas, por exemplo, o usuário pode se sentir tão seguro a ponto de exceder limites de velocidade, ou deixar de usar cinto de segurança”, finaliza a pesquisadora. n
Fiéis em culto da igreja Assembleia de Deus, no Rio de Janeiro: estado concentra o maior número de igrejas evangélicas no país, ao lado do Espírito Santo

Aprincipal fonte de informações sobre a afiliação religiosa da população brasileira é o Censo Demográfico, realizado a cada 10 anos pelo Instituto Brasileiro de Geografia e Estatística (IBGE). Para sociólogos e outros pesquisadores da religião, esse intervalo é longo demais. A população evangélica no Brasil passou a crescer em ritmo acelerado desde a década de 1960, deixando os dados do Censo rapidamente defasados.
“Fala-se muito que a população evangélica está aumentando no país, mas não sabemos exatamente de que forma isso vem acontecendo nem onde esse crescimento começou, por exemplo”, afirma o cientista político brasileiro Victor Araújo, da Universidade de Reading, no Reino Unido.
“O Censo é uma fotografia e não temos dados dinâmicos do que acontece entre as edições da pesquisa do IBGE.”
Se na década de 1960 mais de 90% dos brasileiros se declaravam católicos, até 2040 o evangelicalismo, em suas diversas denominações, deverá ser o maior grupo religioso do país. O fenômeno que o Brasil atravessa é conhecido como “transição religiosa”. Em parte da Europa isso aconteceu de forma estendida durante as guerras religiosas dos séculos XVI e XVII, mas aqui, de acordo com Araújo, o processo poderá ser mais breve e levar menos de 100 anos.
Para identificar como as igrejas evangélicas se distribuem no território nacional, Araújo recorreu a outra fonte de informação: utilizou dados da Receita Federal, disponíveis on-line. Como há mais de 152 mil estabelecimentos religiosos inscritos no país, o cientista político desenvolveu um algoritmo na linguagem de programação R,
com código aberto, que pode ser acessado por pesquisadores e demais interessados no tema.
O método permitiu detectar e classificar os templos registrados na Receita Federal de acordo com as categorias empregadas nos censos do IBGE. São elas: as missionárias, mais antigas, como a Batista, a Presbiteriana e a Metodista; as pentecostais, cuja doutrina contém elementos ausentes das missionárias, como a crença em milagres, e incluem Assembleia de Deus, Congregação Crist ã do Brasil e Deus é Amor; e as neopentecostais, fenômeno surgido no fim da década de 1970 no Brasil que enfatiza a teologia da prosperidade e inclui igrejas como Universal do Reino de Deus, Sara Nossa Terra e Renascer em Cristo. Há ainda as igrejas de “classificação não determinada”.
Os resultados foram publicados na nota técnica “Surgimento, trajetória e expansão das igrejas evangélicas no território brasileiro ao longo do último s é culo (1920-2019)”, divulgada recentemente pelo Centro de Estudos da Metrópole (CEM), da Universidade de São Paulo (USP), ao qual Araújo está associado no Brasil. O CEM é um dos Centros de Pesquisa, Inovação e Difusão (Cepid) financiados pela FAPESP. “O levantamento traz um dado adicional para nós, pesquisadores desse campo, porque o Censo Demográfico do IBGE nada diz a respeito da criação de templos”, afirma o sociólogo Ricardo Mariano, da Faculdade de Filosofia, Letras e Ciências Humanas (FFLCH-USP).
Graças ao recurso digital, o pesquisador mapeou a história da transição religiosa no país entre 1920 e 2019. Araújo assinala que a legislação sobre igrejas foi alterada diversas vezes, mas o registro mais antigo ainda ativo na Receita Federal é de
1922. Trata-se de uma igreja de denominação batista em Nova Iguaçu (RJ). Como escreve na nota técnica, isso não significa que essa seja a primeira igreja evangélica inaugurada no Brasil. Registros históricos indicam, por exemplo, a existência de uma congregação da Assembleia de Deus fundada em 1911 em Belém (PA).
No Brasil, as organizações religiosas são obrigadas a ter o Cadastro Nacional de Pessoa Jurídica (CNPJ) desde 2002, como estabelece o artigo 44 do Código Civil. A exigência também é prevista na Lei n° 10.825/2003. “A legislação institui que as igrejas são pessoas jurídicas de direito privado. Portanto, necessitam ter inscrição na Receita Federal e, por consequência, o CNPJ para, por exemplo, abrir conta bancária e contratar funcionários”, informa Armando Rovai, presidente da Comissão Especial de Advocacia Empresarial da Ordem dos Advogados do Brasil, seção São Paulo (OAB-SP). O CNPJ foi criado em 1998. Antes havia o Cadastro Geral de Contribuintes (CGC), instituído em 1964.
Na avaliação de Araújo, a transição religiosa é “um dos fenômenos demográficos mais importantes do Brasil contemporâneo”. O processo se acelerou principalmente a partir da década de 1960, acompanhando a urbanização e a industrialização do país. “Quando as pessoas se mudavam para as novas periferias das cidades, ainda não havia
ali paróquias católicas. Quem chegou primeiro nessas localidades foram os evangélicos porque podiam abrir templos sem precisar recorrer ao Vaticano, como era o caso dos católicos”, relata o pesquisador, autor do livro A religião distrai os pobres? O voto econômico de joelhos para a moral e os bons costumes (Edições 70, 2022).
Até hoje, as regiões que mais se urbanizaram são os maiores bastiões do evangelismo brasileiro. Dentre as unidades da federação, Espírito Santo e Rio de Janeiro concentram o maior número de igrejas evangélicas – mais de 80 templos por 100 mil habitantes, em ambos os casos. Ou seja, nessas localidades existe uma igreja evangélica para cada 1.250 moradores, revela o levantamento. Já o Nordeste continua sendo amplamente católico, embora os evangélicos predominem nas regiões metropolitanas das capitais.

Para o antropólogo Ronaldo de Almeida, coordenador do Laboratório de Antropologia da Religião da Universidade Estadual de Campinas (LAR-Unicamp), o mapeamento dos templos realizado por Ara újo corrobora pontos que os estudos da religião vêm buscando mostrar nesses últimos anos. Um deles é a aceleração do crescimento do evangelismo na década de 1980, quando o Censo começou a sinalizar com maior acuidade a presença dessa população no país.
Outro ponto é a expansão territorial dessas igrejas detectada no Censo de 2000. “É possível perceber o crescimento de igrejas evangélicas em áreas de imigração recente”, acrescenta
Pico de crescimento aconteceu entre 2000 e 2016
Almeida, que também é pesquisador do Centro Brasileiro de Análise e Planejamento (Cebrap).
“As regiões Norte e Centro-Oeste, fronteiras da expansão agrícola nas últimas décadas, receberam muitos agricultores do Sul do país, onde a presença protestante é historicamente forte.”
As primeiras igrejas a se instalarem, junto com os migrantes, eram de orientação missionária. Na última década, porém, igrejas pentecostais e neopentecostais avançaram mais rapidamente. É o caso de Rondônia. De acordo com o mapeamento, no ranking dos estados com maior número de igrejas evangélicas, Rondônia ocupava o antepenúltimo lugar em 1970. Entretanto, a partir de 2000 passou a figurar entre os cinco primeiros colocados. Em 2019, abrigava 60 templos por 100 mil habitantes e era um dos estados brasileiros mais próximos de completar a transição religiosa, ao lado de Rio de Janeiro, Mato Grosso do Sul e Espírito Santo.
Acontagem dos templos não expressa com precisão a quantidade desses fiéis no Brasil. Afinal, uma capela e uma catedral têm um único registro no CNPJ, mas comportam públicos incomensuráveis. “Como em todo estudo, há limitações. É difícil captar a expansão dos evangélicos no último século no país, mas o registro dos templos é uma variável complementar que contribui para enxergar o que ocorreu no Brasil ao longo desse recorte temporal”, afirma Almeida.


Além disso, muitas igrejas operam clandestinamente, sem CNPJ: um líder religioso pode, por exemplo, realizar cultos na sala ou garagem de sua casa. “Muitas pequenas congregações não se
sentem na obrigação de se formalizarem. A subnotificação é grande”, observa Mariano. Também não constam do levantamento igrejas que foram abertas no período analisado, mas que, por algum motivo, já não estavam ativas em 2019. É possível, ainda, que indivíduos registrem CNPJ de igrejas com finalidade não religiosa, mas esses casos não são identificáveis nos dados do Fisco, como alerta Araújo.
Ainda assim, os dados relativos aos anos em que houve Censo, como 2000 e 2010, estão alinhados aos números divulgados pelo IBGE. “Para os anos não censitários, quando não é possível fazer a comparação, é provável que a classificação também esteja próxima do que seria se os dados fossem coletados todo ano”, diz Araújo.
Segundo o cientista político, a disponibilização da ferramenta para outros pesquisadores é um dos objetivos de seu estudo. “Qualquer pessoa com um conhecimento intermediário de programação e um computador com capacidade padrão de processamento pode replicar os procedimentos”, afirma Araújo. O pesquisador pretende atualizar as informações contidas no estudo à medida que novos dados forem disponibilizados no site da Receita Federal, bem como comparar os resultados com os números que serão divulgados pelo Censo de 2022. n

Dezenas de fotógrafos italianos atuaram no Brasil durante o Império e a Primeira República, mas a maior parte de sua produção não sobreviveu ou não está acessível hoje. Atualmente, nos museus e arquivos brasileiros, não é possível localizar mais de uma dezena de fotografias da maioria desses profissionais, de acordo com a pesquisadora Livia Raponi, diretora do Instituto Italiano de Cultura do Rio de Janeiro. A escassez desses registros contrasta com a riqueza numérica dos acervos de outros estrangeiros, como os franceses Victor Frond (1821-1881), Augusto Stahl (1828-1877) e Marc Ferrez (1843-1923). No entanto, os italianos estiveram em todas as regiões do país, receberam prêmios em exposições nacionais e títulos oficiais do Império, registraram obras públicas e transformações urbanas e foram pioneiros da exibição cinematográfica.
Nove desses fotógrafos foram reunidos no livro Italianos detrás da câmera (Editora Unesp, 2022), organizado por Raponi e pelo historiador da fotografia Joaquim Marçal Ferreira de Andrade, curador, pela Biblioteca Nacional, do portal Brasiliana Fotográfica. Os critérios de escolha foram a disponibilidade de imagens digitalizadas em instituições de memória e a representação de diferentes partes do território brasileiro, do sul à Amazônia. Apoiado pela embaixada da Itália no Brasil e acompanhado da exposição Fotógrafos italianos no florescer da fotografia brasileira, realizada no Centro Cultural Banco do Brasil (CCBB) do Rio de Janeiro, em outubro e novembro de 2022, e de Brasília, de março a
junho passados, o volume pretende incentivar pesquisas sobre esses artistas.
A baixa disponibilidade de imagens reflete a relativa obscuridade em que caiu a maior parte dos fotógrafos italianos pioneiros no país. Em 2005, no artigo “O exórdio de uma cultura urbana no Brasil no final do século XIX e início do século XX”, a arquiteta e historiadora da arte Maria Pace Chiavari, da Universidade Federal do Rio de Janeiro (UFRJ), escreveu: “A produção de fotógrafos franceses, alemães e ingleses que trabalharam no Brasil inspirou inúmeras publicações; faltam, porém, estudos sobre os italianos que se espalharam por todo o país e deixaram uma importante documentação de sua passagem”. Para Marçal, a lacuna permanece e o estudo desses profissionais continua sendo “um campo completamente aberto”.
Marçal compara o legado dos italianos com o dos franceses, que deixaram sua marca no Brasil a partir da chegada da Missão Artística Francesa, em 1816. Os italianos aportaram no país em condições diferentes. Havia imigrantes que buscavam ganhar a vida, engenheiros que fotografavam suas obras, profissionais de outras áreas que também se dedicavam a registrar imagens. “Os italianos não vinham com o mesmo apoio institucional dos franceses. Vinham para trabalhar. E, quando olhamos mais de perto para a história da fotografia brasileira, vemos que boa parte dos fotógrafos locais teve professores italianos. Muitos dos viajantes, que retratavam as pessoas em rincões e cidades menores, eram da Itália”, afirma Marçal. Algumas vezes, a existência desses indivíduos ficou registrada quase exclusivamente em menções e anúncios na imprensa local.
Entre os itinerantes encontram-se nomes como Nicola Maria Parente (1847-1911), nascido na região da Basilicata, sul da Itália. Parente, que também era dentista, montou ateliês em cidades como Goiana (PE) e João Pessoa (PB), ganhando a vida com a venda de cartões de visita e retratos de família. Em 1897, ao retornar de uma viagem à França, trouxe um exemplar do cinematógrafo dos irmãos Lumière, com o qual realizou a primeira sessão de cinema da capital paraibana nesse mesmo ano. Em maio de 1911, quando morava na cidade de Abaeté, hoje Abaetetuba (PA), o fotógrafo morreu em um acidente: experimentava um gerador de oxigênio que havia criado para sua atividade de dentista quando o invento explodiu.
Atualmente, um dos nomes mais divulgados entre os antigos fotógrafos italianos é Vincenzo Pastore (1865-1918), que manteve ateliês em São Paulo a partir de 1894 e, durante alguns anos, em Potenza e Bari, na Itália. Sua obra mais célebre é uma série de imagens de trabalhadores urbanos, realizadas nas décadas de 1900 e 1910, hoje pertencentes ao Instituto Moreira Salles (IMS). Mas nem sempre foi assim. Essas imagens, guardadas em uma caixa de sapato, permaneceram esquecidas durante quase todo o século XX e só atingiram seu atual grau de notoriedade graças à doação feita pelo pianista Flavio Varani, neto do fotógrafo, ao IMS, em 1996.
As fotografias mostram engraxates, lavadeiras e carregadores circulando pela cidade que começava a se modernizar e crescer. O conjunto tem uma particularidade: em sua época, as impressões não foram comercializadas, mas estampadas em restos de papel fotográfico e expostas
nas paredes de seu ateliê de São Paulo. Pastore era reconhecido como retratista e teve grande sucesso comercial, de acordo com a historiadora Fabiana Beltramim, pesquisadora de estudos visuais e autora do livro Entre o estúdio e a rua: A trajetória de Vincenzo Pastore, fotógrafo do cotidiano (Edusp, 2016). A obra é baseada na tese de doutorado que defendeu no ano anterior no Departamento de História da Faculdade de Filosofia, Letras e Ciências Humanas da Universidade de São Paulo (FFLCH-USP).
“Essas imagens não fazem parte de uma tradição que retratava o exotismo e a escravidão do Brasil para satisfazer a curiosidade de turistas estrangeiros”, afirma Beltramim. A pesquisadora defende que Pastore, em suas fotografias de trabalhadores egressos da escravidão e imigrantes europeus feitas após a Abolição da escravatura, exercitou um estilo conhecido na Itália como arte per via (arte nas ruas), que mostra as pessoas em suas ocupações diárias. Segundo Beltramim, as cenas urbanas de Pastore mobilizam essa tradição de um repertório visual de tipos e costumes, mas ele se interessava pelas contradições da vida urbana paulistana. “Ele estava atento às sociabilidades das camadas populares, que faziam das ruas seu espaço de vida e trabalho. E entendia as ambiguidades da nossa modernidade. Por causa de seu olhar atento ao trabalho informal, eu o
chamei de ‘fotógrafo do cotidiano’”, diz. Em alguns outros estados, os registros são mais abundantes. É o caso do Rio Grande do Sul, de acordo com a historiadora da arte Zita Rosane Possamai, da Universidade Federal do Rio Grande do Sul (UFRGS). No mesmo período, italianos também se destacaram nas imagens urbanas de outra capital que se modernizava: Porto Alegre. Na virada do século, uma certa rivalidade chegou a se instalar entre os fotógrafos Virgilio Calegari (1868-1937), italiano, e Jacintho Ferrari (?-1935), filho de italiano. Calegari – presente no livro editado por Raponi e Marçal – registrou as transformações que a cidade atravessou na primeira década do século XX, quando os antigos quarteirões coloniais davam lugar à metrópole republicana.
“Calegari se radicou em Porto Alegre, onde viveu até o fim da vida. Ele acompanhou todo o processo de modernização da cidade”, afirma Possamai, que publicou diversos artigos sobre o trabalho do fotógrafo. “Por isso, ele constrói um olhar que reflete essa metamorfose. Suas imagens contêm elementos novos, como desembarques no cais do porto, o que remete à presença da multidão, uma novidade naquele momento.” O resultado é o álbum Porto Alegre, produzido entre 1908 e 1912. Segundo Possamai, o autor se inspirou em outros conjuntos de imagens urbanas daquele período – em sua
biblioteca, havia um álbum sobre Nova York. “Virgilio Calegari e Jacintho Ferrari eram os dois principais fotógrafos da cidade. Disputavam a clientela, sobretudo a classe dominante, que tinha recursos para contratá-los”, relata Possamai.

Também era italiano um dos primeiros fotógrafos dos quais se tem registro em Porto Alegre. Trata-se de Luís Terragno (1831-1891), que se instalou na capital em 1853 e percorreu diversas cidades da então província de São Pedro. Além de registrar imagens, o genovês estudou os processos químicos da fotografia e chegou a criar uma emulsão a partir da mandioca, o sulfomandiocato de ferro. Terragno buscava adaptar as técnicas fotográficas às condições climáticas do Brasil, de acordo com Marçal.
O fotógrafo é autor de imagens do imperador dom Pedro II (1825-1891) e de seu genro, Gastão de Orléans, o conde d’Eu (1842-1922), em trajes gaúchos. As fotografias, de teor propagandístico, foram realizadas em 1865, durante a passagem do Exército brasileiro pelo Rio Grande do Sul, rumo à Guerra do Paraguai (1864-1870). Na ocasião, Terragno teria apresentado um pedido ao imperador para acompanhar as tropas até o front e registrar as batalhas. Assim como ocorreu com todos os demais fotógrafos,
teve o pedido negado. “Como grande promotor da fotografia, o imperador tinha perfeita consciência do poder que as imagens têm e não queria que ficassem registros do conflito”, afirma Marçal.
Italianos detrás da câmera também ressalta a produção imagética de dois autores mais conhecidos por sua atuação em outro campo. Trata-se de Ermanno Stradelli (1852-1926) e Guido Boggiani (1861-1902), que se dedicaram a trabalhos etnográficos no século XIX. O primeiro foi objeto da tese de doutorado de Raponi, defendida no Departamento de Letras Modernas da FFLCH em 2018. Nascido em uma família abastada de Piacenza, Stradelli foi influenciado pela mentalidade romântica de sua época, o que lhe incutiu o gosto pelas explorações. Interessou-se pelos costumes e as cosmologias dos povos indígenas da Amazônia e organizou, mesmo sem apoio institucional, expedições com objetivos tanto geográficos, como o mapeamento de rios, quanto antropológicos. Sua obra mais conhecida é o Vocabulário português-nheengatu – Nheengatu-português, idioma desenvolvido a partir de línguas indígenas amplamente falado no Brasil colonial. Ela veio a público postumamente, em 1929, na Revista do Instituto Histórico e Geográfico Brasileiro. Desde 2014, o livro integra o catálogo da Ateliê Editorial. O antropólogo, historiador e folclorista Luís da Câmara Cascudo (1898-1986) afirmou que a obra era “uma verdadeira enciclo -
pédia amazônica”. Para Raponi, o interesse de Cascudo, que resultou no livro Em memória de Stradelli (Livraria Clássica, 1936), foi responsável por manter viva a lembrança do fotógrafo-explorador.
Já o piemontês Boggiani era pintor reconhecido na Itália, onde viveu até os 27 anos. Amigo do escritor Gabriele d’Annunzio (1863-1938), foi conduzido pelo mesmo espírito aventuresco de Stradelli a viajar para a América do Sul e acompanhar expedições para o norte da Argentina, Paraguai e oeste do Brasil. Fotografou e escreveu sobre as etnias Chamacoco e Kadiwéu, o que lhe rendeu citações do antropólogo Darcy Ribeiro (1922-1997), que fez trabalhos etnográficos na mesma região.
De posse de tecnologias de revelação mais avançadas do que as de Stradelli, Boggiani pôde realizar retratos notáveis, sobretudo por captar aspectos singulares dos seus modelos, que parecem estar à vontade na frente da câmera, em particular as mulheres, observa Raponi. Seu olhar treinado como pintor enfatizou elementos como a pintura facial e corporal e as vestimentas femininas. Em algumas imagens, os indígenas sorriem, algo que não era habitual nos retratos do século XIX.
Apesar da cumplicidade e talvez por causa dela, Boggiani teve morte precoce, violenta e misteriosa. Seus restos
mortais foram encontrados na região do Chaco paraguaio em 1904, com o crânio esmagado e a câmera fotográfica enterrada a uma certa distância. O motivo do assassinato pelos indígenas que o haviam fascinado não foi esclarecido. “Há muitas especulações, que vão do ciúme por seu envolvimento com mulheres indígenas até uma reação à própria câmera, com seu poder de ‘roubar a alma’”, observa Raponi.


O acesso ainda limitado às fotografias ajuda a explicar a queixa de Chiavari sobre a insuficiência de estudos históricos sobre fotógrafos italianos no Brasil. As imagens sobreviventes de Stradelli estão no Arquivo Fotográfico da Sociedade Geográfica Italiana. As de Boggiani se encontram em coleções europeias, tanto públicas quanto privadas. Possamai aponta que também no Rio Grande do Sul muitas das fotografias de Terragno, Calegari e Ferrari pertencem a coleções particulares.
Marçal espera que outras imagens possam ser encontradas em posse de herdeiros. Recuperá-las seria uma maneira de reescrever a história dos italianos que se instalaram no Brasil. “Veja o que aconteceu com Pastore: depois que os descendentes doaram suas fotografias, ele se tornou um monumento”, conclui o historiador. n
Galves se dedicou a formar uma rede internacional de pesquisadores em probabilidade e estatística
Galves-Löcherbach”, usado em pesquisas de neurocomputação e simulação do comportamento do cérebro e uma das contribuições de maior impacto do pesquisador brasileiro.
Claudio Landim, diretor-adjunto do Instituto de Matemática Pura e Aplicada (Impa), destaca dois artigos de Galves. O primeiro, de 1981, em coautoria com os matemáticos Claude Kipnis (1949-1993), francês, e Carlo Marchioro e Errico Presutti, italianos, é um dos primeiros a estudar sistemas termodinâmicos fora do equilíbrio e contém uma dedução estatística da lei de Fourier, que trata do fluxo de calor em um material. O segundo, de 1984, com o físico-estatístico italiano Marzio Cassandro, o italiano Enzo Olivieri e a brasileira Maria Eulália Vares, ambos matemáticos, inaugura o “estudo sistemático da metaestabilidade”, de acordo com Landim.
 Diego Viana
Diego Viana
Em julho e agosto, a 26a edição da Escola Brasileira de Probabilidade, evento internacional que reúne pesquisadores e estudantes de estatística, homenageou um de seus principais promotores: o matemático paulistano Antonio Galves, do Departamento de Estatística do Instituto de Matemática e Estatística da Universidade de São Paulo (IME-USP). A homenagem foi o último contato que muitos de seus colegas tiveram com Galves, que morreu no dia 5 de setembro, em Campinas (SP), aos 76 anos, de causa não divulgada.
Ele é considerado o pai da rede de pesquisadores em probabilidade e estatística no Brasil devido a seus esforços para formar e fortalecer os vínculos entre os profissionais desse campo. Além disso, buscou estabelecer pontes com colegas de outros países da América Latina e da Europa.
Galves formou-se em matemática em 1968, na USP, onde também cursou o mestrado em estatística (1972) e o dou-
torado na mesma área (1978). Em 1969 tornou-se professor nessa instituição de ensino, onde permaneceu até se aposentar em 2022 como professor titular. Era coordenador do Núcleo de Apoio à Pesquisa em Matemática, Computação, Linguagem e Cérebro (MaCLinC-USP).
O ponto de partida de seus trabalhos foram os sistemas markovianos de partículas, cuja trajetória independe de eventos passados, isto é, da memória. Galves, porém, introduziu a memória nesses sistemas, conforme explica a matemática alemã Eva Löcherbach, da Universidade de Paris 1 Panthéon-Sorbonne. Ele estudava as cadeias de ordem variável, ou seja, sistemas cuja dependência de eventos passados pode ser mais extensa ou mais curta.
Em 2013, o brasileiro e a alemã publicaram artigo em que apresentam um cálculo para o tempo que um estímulo (spike) emitido por um neurônio em uma rede neural leva para retornar a seu emissor. Essa é a origem do “modelo de
O termo designa estados de sistemas com um longo período de aparente equilíbrio, seguido de uma rápida alteração ao equilíbrio estável. Casos típicos são os líquidos super-resfriados. Por exemplo, uma garrafa de cerveja colocada no congelador, a uma temperatura abaixo de zero ºC, que congela de repente quando sofre uma perturbação externa.
O físico-matemático José Fernando Perez, diretor científico da FAPESP entre 1993 e 2005, exemplifica o caráter agregador de Galves por meio de seu esforço de aproximar profissionais do IME e do Instituto de Física da USP. “Nos anos 1980 e 1990 estabelecemos uma sólida parceria entre as duas instituições e muitos dos meus alunos acabaram sendo contratados pelo IME, embora fossem físicos.”
Desde 2013, Galves coordenava o Centro de Pesquisa, Inovação e Difusão em Neuromatemática (NeuroMat), um dos Centros de Pesquisa, Inovação e Difusão (Cepid) apoiados pela FAPESP. Entre os projetos do NeuroMat, há um videogame em que o participante é convidado a prever para que lado um atacante cobrará um pênalti, com base em seu comportamento passado. Essa ferramenta já foi utilizada para detecção precoce da doença de Parkinson.
Galves era casado com Charlotte Chambelland Galves e tinha duas filhas e um filho. n
Setzer: trabalho com queimadas levou o governo a lançar programas de prevenção e combate a incêndios

Evocar frio e calor ajudam a contar a trajetória do engenheiro ambiental Alberto Waingort Setzer e suas contribuições para a ciência brasileira. De 1984 a 2010 ele coordenou o projeto de Meteorologia Antártica do Brasil e em 1985 idealizou o programa de monitoramento de queimadas do Instituto Nacional de Pesquisas Espaciais (Inpe), que comandou até 2020. No dia 8 de setembro, Setzer, de 72 anos, jogava tênis em Ubatuba (SP) quando um infarto o matou.
Paulistano, formado em engenharia mecânica pela Escola de Engenharia Mauá (1973), Setzer cursou o mestrado (1977) no Technion Institute of Technology, em Israel, e o doutorado (1982) na Universidade Purdue, nos Estados Unidos, ambos em engenharia ambiental. Ingressou no Inpe em 1977, onde ficou por toda a carreira.
No verão entre os anos de 1984 e 1985, realizou a primeira de 25 missões na Antártida que faria à Estação Antártica Comandante Ferraz. O objetivo era instalar o sistema de meteorologia do Programa Antártico Brasileiro, que começou a funcionar em 1986 para dar suporte às equipes de pesquisa de campo na estação e às dos navios de pesquisa oceanográfica Barão de Teffé e Ary Rongel, da Marinha do Brasil. “De 1995 a 2002 estive em várias missões de campo na Antártida e era o Alberto quem me atualizava com a previsão do tempo ou alguma notícia
relevante para o deslocamento das equipes sobre o gelo. Ele implementou uma rede de pesquisa meteorológica que é reconhecida internacionalmente por sua qualidade”, diz Francisco Eliseu Aquino, climatologista da Universidade Federal do Rio Grande do Sul (UFRGS).
Entre as características relatadas pelos que o conheciam, a preocupação social parece ter sido a mais importante. “O Alberto resolveu entrar nas questões das queimadas porque viu que era um tema altamente relevante para o país”, afirma o físico Ricardo Galvão, presidente do Conselho Nacional de Desenvolvimento Científico e Tecnológico (CNPq) e diretor-geral do Inpe entre 2016 e 2019. Em 1985, durante um trabalho conjunto do Inpe com a Nasa, a agência espacial norte-americana, Setzer sobrevoou a Amazônia para investigar a composição química do que se pensava ser o ar mais puro do planeta. Os expressivos índices de poluição do ar deixaram os pesquisadores surpresos. Setzer, então, solicitou as imagens do satélite meteorológico Noaa-9, dos Estados Unidos, que mostraram focos de calor na porção sul do bioma amazônico. Foi o primeiro indício científico de que as queimadas aconteciam em proporções tais que eram capazes de mudar a composição da atmosfera e, em larga escala, afetar o clima do planeta.
A confirmação da dimensão de seu impacto foi a motivação para que enca-
beçasse o Projeto de Monitoramento de Queimadas por Satélite. Em ação desde setembro de 1987, escancarou ao mundo o grande volume de queimadas no país e forçou o governo brasileiro a lançar, em 1988, o Pacote Ecológico Nossa Natureza, além de criar a Comissão de Prevenção e Combate aos Incêndios Florestais. Em 1989, nascia o Instituto Brasileiro do Meio Ambiente e dos Recursos Naturais Renováveis (Ibama) e o Sistema de Prevenção e Combate aos Incêndios Florestais.
Setzer esteve à frente do Programa Queimadas por 35 anos. Segundo Galvão, a iniciativa do Inpe de tornar as imagens de satélites disponíveis gratuitamente, em 2004, apoiada por Setzer, teve um impacto enorme. O material é usado por órgãos de governo, organizações não governamentais e empresas privadas. “Somente depois que o Brasil liberou as imagens, a Nasa e a Agência Espacial Europeia fizeram o mesmo.”
A meteorologista Renata Libonati, da Universidade Federal do Rio de Janeiro (UFRJ), comprova o reconhecimento que o pesquisador tinha entre seus pares. “Há 20 anos viajo pelo mundo em conferências e reuniões científicas da área de sensoriamento remoto do fogo, em que ele foi pioneiro, e não há lugar que eu tenha ido em que as pessoas não conhecessem o Alberto e seu trabalho”, conta.
Alberto Setzer deixa a mulher, Adriana Prest Mattedi, e uma filha, Joana Setzer. n
Identificado há 40 anos, o HIV mudou a visão sobre doenças infecciosas

Suzel Tunes
Em uma sexta-feira, 20 de maio de 1983, uma equipe do Instituto Pasteur de Paris liderada pelo virologista francês Luc Montagnier (1932-2022) anunciou em um artigo publicado na Science uma descoberta ansiosamente aguardada por médicos e cientistas: a identificação do vírus causador da nova doença que vinha destruindo o sistema imunológico dos pacientes, jovens na maioria, deixando-os vulneráveis a infecções oportunistas e tipos raros de câncer. Desde 1982, a enfermidade era conhecida como Síndrome da Imunodeficiência Adquirida, ou Aids ( Acquired Immunodeficiency Syndrome ). Seu agente causador receberia em 1985 o nome de Human Immunodeficiency Virus, HIV, ou Vírus da Imunodeficiência Humana.
Em paralelo a Montagnier, o virologista norte-americano Robert Gallo, que também trabalhava na identificação do novo agente infeccioso no Instituto de Virologia Humana da Universidade de Maryland, nos Estados Unidos, reivindicou a paternidade da descoberta. Depois de disputas na Justiça, os dois cientistas seriam reconhecidos como codescobridores do vírus, com direito partilhado à patente de exames diagnósticos. Mas quem recebeu o Prêmio Nobel de
Medicina e Fisiologia de 2008 em razão dessa descoberta foi Montagnier e sua colega Françoise Barré-Sinoussi.
Em abril de 1984, a então secretária de Saúde norte-americana, Margaret Heckler (1931-2018), previa que uma vacina contra o vírus estaria pronta em dois anos. Quatro décadas depois, essa estratégia de combater a Aids ainda parece distante. “O desenvolvimento de uma vacina acabou se mostrando uma tarefa mais difícil do que pensávamos”, reconhece o infectologista Esper Kallás, diretor do Instituto Butantan, que pesquisa formas de deter a Aids desde 1996 na Faculdade de Medicina da Universidade de São Paulo (FM-USP).


“O HIV tem uma imensa capacidade de mutação e, até o momento, conseguiu escapar da resposta imune estimulada pelas vacinas experimentais.”
No início, os médicos não conseguiam explicar como os casos de pacientes seriamente debilitados se multiplicavam nos serviços de saúde, muitos com quadros graves de pneumonia por Pneumocystis carinii, que acomete pessoas imunossuprimidas, ou sarcoma de Kaposi, um tipo raro de câncer que costuma ter evolução lenta em idosos, mas nos pacientes jovens com Aids avançava de forma rápida e agressiva.
“Entrávamos nos ambulatórios com máscaras e roupas especiais, assim como fizemos recentemente com a Covid-19, para atender os pacientes com Aids”, lembra a infectologista Rosa de Alencar Souza, diretora adjunta do Centro de Referência e Treinamento-DST/Aids do
Estado de São Paulo. Em sua residência médica, de 1986 a 1988, ela já atendia casos de Aids, que desde o ano de 1983 avançava pelo país. Enfrentar uma doença até então pouco conhecida lhe trouxe o que considera um dos aprendizados mais importantes de sua carreira: “Cuidar, no sentido mais amplo”.

“Na infectologia trabalhamos muito com infecção bacteriana, que em geral se cura com antibiótico, mas logo ao entrar na vida profissional me deparei com uma doença que não tem cura e pode evoluir rapidamente para óbito”, comenta Souza. Segundo ela, diante do sentimento de impotência trazido por esse cenário, o cuidado médico ganhava outra dimensão. Além de tratar as infecções oportunistas, buscava-se dar mais conforto e dignidade ao paciente. E nesse modelo de
cuidado integral, um só profissional não bastava. “Era necessário trabalhar com profissionais da saúde mental, das ciências sociais, da enfermagem. O trabalho multiprofissional ganhou importância”, relata a médica.
Cuidar de um paciente com sintomas de Aids significava, também, acolher com empatia uma pessoa duplamente vitimizada: aos sintomas físicos da doença fatal somavam-se os sofrimentos causados por preconceito e marginalização. Como inicialmente a epidemia atingiu sobretudo homens homossexuais, não demorou para que termos preconceituosos como “peste gay” ou “câncer gay” começassem a ser disseminados pelos meios de comunicação. Os homossexuais continuaram a ser vistos como “grupo de risco” mesmo depois que a doença alcançou homens e
mulheres heterossexuais e se comprovaram outras vias de transmissão além da sexual, como a sanguínea.
“Naquela época, a ignorância era brutal”, recordou o oncologista Drauzio Varella em entrevista em 2019 (ver Pesquisa FAPESP nº 279). O médico viu o início da epidemia quando estava em Nova York em 1983. De volta a São Paulo, atendeu alguns dos primeiros pacientes com a doença e orientou a população por meio de programas inicialmente de rádio e depois de televisão. Atualmente, a expressão “grupo de risco” deixou de ser usada, em razão da discriminação que acarreta.
Do sofrimento, emergiram a solidariedade e a mobilização da comunidade homossexual e de organizações não governamentais (ONG) em defesa dos pacientes com Aids e dos indivíduos soropositivos, que participaram da formulação de um plano governamental de combate à epidemia. “A articulação com a sociedade civil foi uma das principais marcas da resposta brasileira à epidemia de Aids”, afirma a médica sanitarista Maria Clara Gianna, uma das criadoras do CRT/Aids em 1988, atualmente na Secretaria de Vigilância em Saúde e Ambiente do Ministério da Saúde (MS). “O enfrentamento da Aids uniu ONG, pessoas com HIV, médicos e pesquisadores. Vários projetos financiados pela FAPESP impulsionaram essa resposta, com a avaliação e a incorporação de novas tecnologias”, destaca Gianna.

Para Artur Kalichman, sanitarista da Gerência de Vigilância Epidemiológica do CRT desde 1988, o combate à epidemia sustentou-se em três bases: as evidências científicas para a formulação de
políticas públicas de prevenção e tratamento (em contraposição a discursos preconceituosos e moralistas); a reação da sociedade civil organizada contra a discriminação das pessoas vivendo com HIV/Aids; e a criação do Sistema Único de Saúde (SUS), que materializou o conceito de saúde como um “direito de todos e um dever do Estado”, expresso na Constituição de 1988.
“Ter o SUS organizado fez toda a diferença. A Covid-19 mostrou isso novamente”, diz Kalichman. Por meio da rede de atendimento do SUS, preservativos, medicamentos e testes diagnósticos de HIV chegaram à população e mudaram a história da Aids no Brasil.
O uso de medicamentos antirretrovirais começou em 1987, logo após a agência que controla medicamentos e alimentos (FDA) dos Estados Unidos aprovar a zidovudina (AZT). A evolução do tra-
tamento se consolidaria em 1996 com a terapia tripla, com três medicamentos em dois comprimidos, que aumentou a qualidade de vida das pessoas com HIV.
Também em 1987, o imunologista brasileiro Bernardo Galvão, pesquisador emérito da Fundação Oswaldo Cruz (Fiocruz), isolou, pela primeira vez na América Latina, o HIV (ver Pesquisa FAPESP no 118). A partir daí a Fiocruz foi capaz de produzir kits para diagnóstico, barateando o custo e ampliando o acesso.

A disseminação dos testes trouxe mais segurança aos hemocentros, estancando a crescente transmissão do HIV por transfusão de sangue. “A epidemia de HIV/Aids foi decisiva para o controle de doenças transmitidas pelo sangue no Brasil”, ressalta Galvão. Ele conta que, na década de 1980, bancos de sangue de todo o país não tinham a menor regulamentação ou controle: “Para estimular a doação, muitos ofereciam dinheiro em troca da coleta, o que atraía pessoas em situação de rua, com a saúde precária e frequentemente contaminadas por HIV”.
Com a Portaria nº 1.376, de 1993, o MS proibiu a comercialização de sangue humano e tornou obrigatória a triagem de agentes infecciosos transmitidos por via sanguínea. Essas orientações foram ratificadas oito anos depois, quando se aprovou a Lei nº 10.205, de 21 de março de 2001, que seria chamada de “Lei Betinho”, em homenagem póstuma ao sociólogo Herbert de Souza (1935-1997) e a seus irmãos – o cartunista Henfil (1944-1988) e o músico Chico Mário (1948-1988) –, todos hemofílicos, que contraíram HIV em transfusões de sangue. Betinho foi um dos fundadores da Associação Brasileira Interdisciplinar de Aids (Abia), que presidiu até sua morte.
Cartaz da campanha de 1988, com uma imagem de mulher, criticada na Constituinte, e de 1990, com alertas sobre as formas de transmissão do vírus
A Lei nº 9.313, de 1996, foi outro marco. “A lei garantiu que todas as pessoas vivendo com HIV tivessem acesso gratuito, por meio do SUS, aos antirretrovirais. Não tem faltado até hoje”, comemora Gianna. Além de pessoas com Aids, foram beneficiadas as gestantes, que têm acesso a medicamentos para a prevenção da transmissão vertical do HIV, ou seja, da mãe para o bebê durante a gestação, parto ou amamentação. As mulheres recebem também fórmula láctea artificial, para evitar a transmissão do vírus pelo

leite materno. “Com essas medidas, foi possível eliminar a transmissão vertical no município de São Paulo. O estado de São Paulo está na beira de conseguir isso. A meta é certificar todo o país até 2025.”
As estratégias de tratamento e prevenção, integradas a campanhas de informação em meios de comunicação de massa, permitiram a redução contínua dos casos de Aids no país, do ápice de 43.850 casos notificados em 2013 para 15.412 registrados em 2022. Os resultados se devem em boa parte à médica Lair Guerra de Macedo, criadora do Programa Nacional de DST [Doenças Sexualmente Transmissíveis] e Aids do Ministério da Saúde, que ela coordenou de 1985 a 1996, quando se afastou em consequência de um acidente de carro.
Os avanços no combate à Aids não são homogêneos. A epidemiologista Maria Amélia Veras, da Faculdade de Ciências
Tenofir, um dos medicamentos da Profilaxia Pré-exposição Sexual (PrEP), para evitar a transmissão do HIV

Médicas da Santa Casa de São Paulo, que acompanha a epidemia desde os anos 1980, quando trabalhava no Recife, alerta para o aumento de casos de infecção e óbitos em estados do Norte e Nordeste. “De modo geral, entre 2011 e 2021 houve um declínio nas taxas de detecção de HIV em 16 estados, mas o crescimento continua em 11”, diz ela. “Quanto às mortes por Aids, o Ministério da Saúde registrou uma queda de 24,6% entre 2011 e 2021 na maioria dos estados, com exceção de Acre, Paraíba, Amazonas, Rondônia, Rio Grande do Norte, Piauí, Alagoas, Pará e Mato Grosso do Sul.”
Para Kalichman, mesmo o registro de 15.412 casos de Aids em 2022 – uma queda de 56,27% em relação ao ano anterior, um possível efeito da subnotificação durante a pandemia de Covid-19 – precisa ser visto com olhar crítico: “A ocorrência de Aids, hoje, é uma falha do sistema de saúde. Depois que uma pessoa contrai o HIV, leva cerca de oito anos para aparecerem os sintomas. Dá tempo para fazer o diagnóstico, iniciar o tratamento e permitir ao paciente ficar com carga viral indetectável”, diz ele. “O problema é quem está ficando para trás por falta de acesso aos serviços de saúde.”
As populações periféricas, negras e de menor renda e escolaridade são as mais afetadas. Travestis e mulheres trans figuram no extremo da vulnerabilidade social e econômica. Na cidade de São Paulo, enquanto a prevalência do HIV na população adulta em geral é de 0,4%, nesses

grupos pode chegar a 40%, segundo um dos estudos do grupo de pesquisa Nudhes (saúde, sexualidade e direitos humanos da população LGBT+), coordenado por Veras. Segundo ela, travestis e mulheres trans são alvo de uma confluência de estigmas baseados em gênero, raça e posição social. Vivendo sob extrema marginalização, elas têm dificuldade de acesso aos serviços públicos de saúde e a recursos eficazes para a prevenção da doença, como a Profilaxia Pré-Exposição (PrEP).
Disponível no SUS desde 2018, a PrEP consiste no uso diário de um medicamento antirretroviral para evitar a reprodução do HIV no organismo, caso a pessoa tenha contato com o vírus. Segundo Kallás, essa estratégia previne 99% de novas infecções. A oferta de PrEP visa especialmente às pessoas em situação de maior vulnerabilidade para o HIV, mas tem sido mais utilizada por pessoas cisgênero brancas e de maior escolaridade. “Em março de 2023, havia 23.302 usuários de PrEP no município de São Paulo, mas apenas 3,9% eram travestis ou mulheres trans”, comenta Veras.
A Aids mostrou que inclusão e igualdade social são tão decisivas quanto os medicamentos. De acordo com a Organização Mundial da Saúde (OMS), em 2022, 39 milhões de pessoas viviam com HIV, principalmente em países pobres. Ainda que a mortalidade associada à Aids tenha caído 55% entre mulheres e 47% entre homens desde 2010, em 2022 as doenças relacionadas à Aids foram a causa de morte de 630 mil pessoas. Mundialmente, o HIV ainda é um sério problema de saúde pública.
O Brasil terá de reforçar a atenção com os grupos ainda pouco atendidos se quiser atingir a meta “95-95-95”, estabelecida pelo Programa Mundial de Aids das Nações Unidas (Unaids) para 2030 – diagnosticar 95% das pessoas soropositivas, tratar 95% delas com antirretrovirais e atingir carga viral indetectável em 95% das pessoas em tratamento. Até o momento atingiu 88-83-95, respectivamente. “O tratamento da Aids teve um desenvolvimento tecnológico muito rápido”, observa Kalichman. “Hoje, o controle da doença não é mais questão de tecnologia, mas de cidadania e respeito aos direitos humanos.” n
Há quase 40 anos, o biólogo e taxidermista Paulo César Balduíno monta animais para coleções científicas e mostras museológicas
Taxidermia é uma palavra de origem grega que significa “dar forma à pele”. É a arte de montar animais para exibição em museus e coleções científicas. No decorrer de meus quase 40 anos de carreira, montei milhares de bichos. Para o Museu de Zoologia da Universidade de São Paulo (MZ-USP), por exemplo, foram mais de 10 mil exemplares, enquanto para o Instituto Nacional de Pesquisa da Amazônia (Inpa) preparei ao menos 4 mil. Trabalho no Laboratório de Taxidermia do Departamento de Biologia Animal, no Instituto de Biologia da Universidade Estadual de Campinas (IB-Unicamp) e perdi as contas de quantos vertebrados preparei para a instituição. Foram inúmeros animais para coleções científicas e didáticas do Museu de Diversidade Biológica (MDBio), para pesquisas de mestrado e doutorado, além de inúmeros trabalhos de campo.
Entrei na Unicamp aos 16 anos para trabalhar como mensageiro da secretaria do IB, em 1982. Minha função era distribuir a correspondência entre os docentes e ajudar na organização de documentos. Eu passava pelos corredores do departamento e ficava olhando fascinado para os animais de todo o Brasil que estavam expostos nas vitrines. Nos dois anos em que fui mensageiro, vi pela primeira vez vários bichos taxidermizados que eu nem sequer sabia que existiam.
Certo dia, fui levar a correspondência para o responsável pelo Laboratório de Taxidermia. Eu nunca tinha visto ninguém entrando lá e estava curioso. Bati à porta e Antonio Corrêa Filho, o primeiro taxidermista do IB, me convidou para entrar. Ele estava sentado na bancada, preparando uma saíra-sete-cores [Tangara seledon]. Fiquei espantado. Nunca tinha visto ninguém realizar aquele trabalho e
tampouco uma ave daquela espécie. Logo que bati os olhos no animal, lembro de ter me perguntado como era possível retirar toda a sua pele sem que as penas caíssem. Aquela pergunta ficou na minha cabeça e pedi para Antonio para voltar no dia seguinte, em meu horário de almoço.
Comecei, então, a frequentar o laboratório e a acompanhar o trabalho dele. Após alguns meses, Antonio se aposentou e um novo taxidermista assumiu o laboratório. Era Otávio Cardozo de Oliveira, até então motorista do diretor do IB, que havia sido treinado por Antonio para substituí-lo. Porém Otávio também estava perto de se aposentar e precisava começar a pensar em um sucessor. Pedi a ele que me ensinasse o ofício e ele aceitou.
Na mesma época, Pierre Montouchet tornou-se chefe do Departamento de Zoologia e eu decidi pedir transferência para o Laboratório de Taxidermia. Ele ficou

Peças preparadas por Balduíno no Museu de Diversidade Biológica, da Unicamp: trabalho minucioso para fazer com que anatomia, postura e olhar dos bichos se assemelhem à realidade
surpreso porque enquanto todo mundo fugia daquele laboratório, eu queria entrar. Depois de algumas semanas, eu estava na secretaria e o professor Pierre apareceu. Colocou a mão em meu ombro e disse: “Você fica aqui até a hora do almoço e, depois, está liberado para ir para a taxidermia”. Naquele mesmo dia comecei a trabalhar com Otávio. Em 1989, quando ele se aposentou, eu assumi o laboratório.
A taxidermia é um processo que pode ser feito com qualquer animal vertebrado, mas eu trabalho com mais frequência com aves e mamíferos. Quando chega um animal no laboratório, pergunto para o professor, pesquisador ou estudante qual seria a finalidade. A artística é voltada à exposição em museus, a didática para o uso em sala de aula, enquanto na científica o foco está em preparar o bicho para compor coleções que serão estudadas por distintos pesquisadores.
Na artística, o primeiro passo é deitar o animal na bancada e fazer um corte longitudinal da genitália até a ponta do nariz para descolar a pele da musculatura. Com muita delicadeza, vou desvestindo a pele como se fosse uma roupa e separo o corpo da cabeça. Faço um molde de gesso fundido em uma estrutura de arame que dará sustentação à peça. Depois, passo uma solução conservante na pele e encaixo o molde da cabeça. Utilizo outras estruturas de arame como se fossem o esqueleto e, depois, preencho a peça com palha e costuro as partes. Além disso, coloco o animal em uma postura específica, fixado em uma base de madeira. O desafio é deixar a peça o mais
similar possível da morfologia real do bicho e em uma postura natural, imitando seus gestos em vida. A parte final da montagem envolve a inserção de olhos de vidro e a injeção de formol.
Para animais que vão para a coleção científica, o processo é mais metódico. Antes de mexer com o animal, realizo a biometria, identifico o sexo, registro sua procedência, data e nome de quem o coletou, peso e tiro medidas. Com esses dados, etiqueto o bicho. Depois, sigo o mesmo procedimento adotado na coleção artística, com exceção da postura. Geralmente, o animal de coleções científicas não fica colado em uma base. Para as duas finalidades, eu me guio por minha memória, que é fotográfica.

No ano 2000, um aluno que tinha realizado mestrado no IB e fazia doutorado na USP passou pelo laboratório. Eu trabalhei com os bichos dele no mestrado e ele me contou que seu doutorado estava parado, pois não conseguia um taxidermista para montar seis tangarás [Chiroxiphia caudata] coletados como parte do estudo. Eu pedi para ver as aves, que estavam congeladas e muito bem conservadas. Disse a ele que faria o trabalho e entreguei todo o material em 15 dias.
Sentia vontade de cursar biologia e decidi prestar vestibular em 2007. Entrei no Centro Universitário Nossa Senhora do Patrocínio, em Itu (SP). Mas eu estava há tantos anos sem estudar que pensei que seria impossível concluir a graduação. Minha ideia era finalizar o primeiro ano com a reprovação em apenas uma disciplina. Caso fosse reprovado em mais de uma, desistiria do curso. Para minha surpresa, fui aprovado em todas as matérias no primeiro ano e em todos os outros. Durante a graduação, conheci uma professora que me apoiou e me convidou para dar aulas de taxidermia na faculdade, já que existem poucos profissionais capacitados no Brasil.
Entre 2010 e 2016, nas últimas viagens que fiz a trabalho pelo Brasil, foram tantos animais coletados que não dava tempo de montá-los em campo. Comecei a trazê-los para casa para fazer as preparações e Bárbara, minha filha caçula, hoje com 27 anos, ficava olhando, cada vez mais interessada. Ela começou a me acompanhar nas viagens. Em uma delas, precisei ir embora mais cedo e Bárbara ficou para dar suporte aos pesquisadores. Tenho 59 anos e vou me aposentar em 2024, mas não pretendo parar totalmente. Mesmo assim, preciso de alguém qualificado para me substituir e minha filha é a principal candidata para assumir a função.
SAIBA MAIS
Passo a passo ilustrado do processo de taxidermia
Semanas mais tarde, esse mesmo aluno me falou sobre um projeto desenvolvido pela USP para levantar a fauna na Amazônia, que estava em busca de um taxidermista para pesquisa de campo. Ele me indicou para o coordenador. Eu jamais tinha me envolvido com uma pesquisa tão grande. Desde então, fui convidado para mais de 20 viagens, o que me deu a oportunidade de trabalhar de forma mais próxima com pesquisadores e aprimorar as habilidades de montar animais para estudos científicos. Nessas ocasiões, muitas vezes, faço a montagem de bichos rodeado de pesquisadores que nunca viram um taxidermista em ação.


Voltando à pergunta que fiz na primeira vez que entrei no Laboratório de Taxidermia: por que as penas das aves não caem? Na verdade, as penas podem cair. Principalmente em trabalhos de campo, quando coletamos uma ampla variedade de bichos, de gaviões a beija-flores. Nesses momentos, é preciso ser delicado e cuidadoso e também saber trabalhar com peles de diferentes texturas e resistências, algumas mais grossas, outras mais gordurosas, aplicando técnicas específicas. Caso contrário, todo trabalho para coletar o animal pode ser perdido.
Gosto de pensar que mais pessoas poderão ver e estudar os bichos taxidermizados. Alguns animais, infelizmente, dentro de alguns anos, não existirão mais na natureza. Quando estou imerso no processo de montagem, me sinto feliz. E fico ainda mais satisfeito quando finalizo e olho o animal, observando a beleza de cada um de seus detalhes. Sinto que com meu trabalho consigo trazer o bicho de volta à vida. É quase como se ele se tornasse eterno. n
Com linguagem didática que não compromete a qualidade conceitual e teórica, Juventude e contracultura , escrito pelo historiador Marcos Napolitano, da Universidade de São Paulo (USP), abrange amplamente a diversidade do movimento contracultural, apresentando seus significados em outras localidades além do epicentro norte-americano, como na Europa, Caribe e América Latina. Inicialmente, aborda a relevância do estudo da contracultura, um movimento frequentemente lembrado e pouco compreendido, de cunho multiculturalista, que teve como mote a luta contra opressões que vão desde aquelas comportamentais, enraizadas na mente e no corpo do indivíduo, resultantes do condicionamento ao sistema instituído, até aquelas que se estendem às esferas política, econômica e cultural.

O autor apresenta as diferentes fases da contracultura, tendo como ponto de partida o cenário pós-guerra e o boom do rock. Nesse período, marcado pela era de ouro do capitalismo, emerge a rebeldia comportamental (1955-1962), personificada pelos “rebeldes sem causa” que impulsionaram a indústria cultural através do consumo de discos de rock, vestuário e outros produtos criados para esse segmento. No cinema, filmes como O selvagem (1953) e Sementes de violência (1955) foram referências significativas para entender a juventude, pois retrataram os medos, os anseios e a profunda insatisfação existencial gerada pelo American way of life. Nesse cenário também se destaca a importância dos poetas beatniks, cujas criações não apenas desafiaram as normas estabelecidas, mas também provocaram uma reflexão profunda sobre os valores e as limitações impostas pelo sistema capitalista e tecnocrático.
O arquétipo juvenil assumiu papel de destaque, solidificando sua rebeldia em formas mais organizadas de resistência e provocação ao sistema. Essas tendências se tornam evidentes na segunda fase da contracultura (1962-1970), quando as manifestações de rebeldia, sociabilidade e expressão cultural se tornam mais conscientes e radicais, fundamentadas no existencialismo de Sartre e na “grande recusa” de Marcuse, que se opõe à ideia do indivíduo unidimensional, aprisionado e sem autonomia sobre sua própria vida. A luta
pelos direitos civis dos negros, homossexuais, mulheres e a inclusão dos jovens como atores sociais significativos são exemplos da politização do movimento contracultural, analisados minuciosamente. Além disso, destacam-se a conscientização ambiental, o pacifismo e outras propostas inovadoras que não encontravam espaço na chamada política tradicional.
Na América Latina, a trajetória da contracultura se deu em um cenário de modernização capitalista, no qual coexistiram estruturas sociais ultraconservadoras evidenciadas em regimes ditatoriais. No Brasil, ao lado da repressão militar iniciada em 1964, havia o anseio pela liberdade percebido na rebeldia comportamental da juventude transviada, passando pelas lutas engajadas do movimento estudantil e chegando ao tropicalismo no final dos anos 1960. Nessa fase, é perceptível a difícil trajetória das lutas juvenis e suas rupturas promovidas no âmbito estético e político, algo que o autor explora ao tratar do “desbunde” ou “udigrudi” na década de 1970, uma versão tropical e antropofágica do movimento hippie, que se diluiu ideologicamente na próxima fase, denominada “contracultura histórica” (1980-1990). Nesse momento, as ideias juvenis se disseminaram por diversas regiões, indo além dos países centrais do capitalismo.
As possibilidades oferecidas pelo horizonte contracultural são apresentadas com um manancial de obras literárias e acadêmicas, filmes de ficção, documentários, entre outros. Nas considerações finais, analisa a fragmentação da contracultura manifestada sob a forma de subculturas superficiais, que se tornaram irrelevantes como crítica global ao sistema. No entanto, enfatiza que, embora o idealismo original dos jovens românticos do século XX possa ter se enfraquecido, o legado da contracultura mantém sua importância na crítica à sociedade dominante, representando uma resistência à extrema direita, que emerge como uma ameaça constante, colocando em risco as liberdades individuais e as lutas coletivas em prol da democracia.
PRESIDENTE
Marco Antonio Zago
VICE-PRESIDENTE
Ronaldo Aloise Pilli
CONSELHO SUPERIOR
Carmino Antonio de Souza, Helena Bonciani Nader, Herman Jacobus Cornelis Voorwald, Ignácio Maria Poveda Velasco, Liedi Legi Bariani Bernucci, Mayana Zatz, Mozart Neves Ramos, Pedro Luiz Barreiros Passos, Pedro Wongtschowski, Thelma Krug
CONSELHO TÉCNICO-ADMINISTRATIVO
DIRETOR-PRESIDENTE
Carlos Américo Pacheco
DIRETOR CIENTÍFICO
Marcio de Castro
DIRETOR ADMINISTRATIVO
Fernando Menezes de Almeida
COMITÊ CIENTÍFICO
Luiz Nunes de Oliveira (Presidente), Agma Juci Machado Traina, Américo Martins Craveiro, Anamaria
Aranha Camargo, Ana Maria Fonseca Almeida, Angela Maria Alonso, Carlos Américo Pacheco, Claudia Lúcia Mendes de Oliveira, Deisy das Graças de Souza, Douglas Eduardo Zampieri, Eduardo de Senzi
Zancul, Euclides de Mesquita Neto, Fabio Kon, Flávio Vieira Meirelles, Francisco Rafael Martins Laurindo, João Luiz Filgueiras de Azevedo, José Roberto de França Arruda, Lilian Amorim, Lucio Angnes, Luciana
Harumi Hashiba Maestrelli Horta, Luiz Henrique Lopes dos Santos, Mariana Cabral de Oliveira, Marco Antonio Zago, Marie-Anne
Van Sluys, Maria Julia Manso Alves, Marta Teresa da Silva Arretche, Reinaldo Salomão, Richard Charles Garratt, Roberto Marcondes
Cesar Júnior, Wagner Caradori do Amaral e Walter Collii
COORDENADOR CIENTÍFICO
Luiz Nunes de Oliveira
DIRETORA DE REDAÇÃO
Alexandra Ozorio de Almeida
EDITOR-CHEFE
Neldson Marcolin
EDITORES Fabrício Marques (Política C&T), Carlos Fioravanti, Marcos Pivetta, Maria Guimarães e Ricardo Zorzetto (Ciência)
Ana Paula Orlandi (Humanidades), Yuri Vasconcelos (Tecnologia)
REPÓRTER Christina Queiroz
ARTE Claudia Warrak (Editora)
Júlia Cherem Rodrigues e Maria Cecilia Felli (Designers), Alexandre Affonso (Editor de infografia), Felipe Braz (Designer digital), Amanda Negri (Coordenadora de produção)
FOTÓGRAFO Léo Ramos Chaves
BANCO DE IMAGENS Valter Rodrigues
SITE Yuri Vasconcelos (Coordenador), Jayne Oliveira (Coordenadora de produção), Kézia Stringhini (Redatora on-line)
MÍDIAS DIGITAIS Maria Guimarães (Coordenadora), Renata Oliveira do Prado (Editora de mídias sociais), Vitória do Couto (Designer digital)
VÍDEOS Christina Queiroz (Coordenadora)
RÁDIO Fabrício Marques (Coordenador) e Sarah Caravieri (Produção)
REVISÃO Alexandre Oliveira e Margô Negro
REVISÃO TÉCNICA Américo Craveiro, Ana Maria Fonseca de Almeida, Célio Haddad, Deisy de Souza, Douglas Zampieri, Francisco Laurindo, José Roberto Arruda, Marta Arretche, Rafael Oliveira
COLABORADORES David Lapola, Diego Viana, Domingos Zaparolli, Felipe Floresti, Giselle Soares, Joana Santa Cruz, Laura Segovia Tercic, Maurício Oliveira, Patrícia Marcondes de Barros, Rodrigo Cunha, Sarah Schmidt, Suzel Tunes, Renato Pedrosa
MARKETING E PUBLICIDADE Paula Iliadis
CIRCULAÇÃO Aparecida Fernandes (Coordenadora de Assinaturas)
OPERAÇÕES Andressa Matias
SECRETÁRIA DA REDAÇÃO Ingrid Teodoro
É PROIBIDA A REPRODUÇÃO TOTAL OU PARCIAL DE TEXTOS, FOTOS, ILUSTRAÇÕES E INFOGRÁFICOS SEM PRÉVIA AUTORIZAÇÃO
TIRAGEM 28.400 exemplares
IMPRESSÃO Plural Indústria Gráfica
DISTRIBUIÇÃO RAC Mídia Editora
GESTÃO ADMINISTRATIVA FUSP – FUNDAÇÃO DE APOIO
À UNIVERSIDADE DE SÃO PAULO
PESQUISA FAPESP Rua Joaquim Antunes, no 727, 10o andar, CEP 05415-012, Pinheiros, São Paulo-SP
FAPESP Rua Pio XI, no 1.500, CEP 05468-901, Alto da Lapa, São Paulo-SP
SECRETARIA DE DESENVOLVIMENTO ECONÔMICO, CIÊNCIA, TECNOLOGIA E INOVAÇÃO
GOVERNO DO ESTADO DE SÃO PAULO
cartas@fapesp.br
Uma indicação do que nosso presente carrega da história das variações climáticas que a Terra já experimentou, podemos estar avançando para um novo arranjo de paisagens, com possível desaparecimento de muitas espécies (“Grãos de pólen do fundo de uma lagoa revelam a história recente da Caatinga”, nota na edição 331 e texto completo disponível no site). O H. sapiens pode entrar na lista.
Ailton Krenak
Produção em baixa
Com os cortes de investimento dos últimos anos, nem milagre faria ter mais publicação (“Avanço interrompido”, edição 331).
Priscilla Queiroz
É um assunto, me parece, cada vez mais preocupante porque os meios de combate são custosos e nem sempre eficazes (“Espécies invasoras causam prejuízo mundo afora”, disponível apenas no site). Na Europa, por exemplo, o adorável guaxinim é considerado uma espécie invasiva e são eliminados aos montes na Bélgica.
ASSINATURAS, RENOVAÇÃO
E MUDANÇA DE ENDEREÇO
Envie um e-mail para assinaturaspesquisa@fapesp.br
PARA ANUNCIAR
Contate: Paula Iliadis
E-mail: publicidade@fapesp.br
EDIÇÕES ANTERIORES
Preço atual de capa acrescido do custo de postagem. Peça pelo e-mail: assinaturasrevista@fapesp.br
LICENCIAMENTO DE CONTEÚDO
Adquira os direitos de reprodução de textos e imagens de Pesquisa FAPESP
E-mail: redacao@fapesp.br
Mas, como não conhecem fronteiras, sempre chegam outros.
Mônica C. Netto
Adoro o conteúdo da revista e sou privilegiado por ter acesso a ela na escola onde trabalho.
João Augusto Silveira Ferreira
Vídeo
Muito bom ver a valorização da pesquisa social, especialmente dos estudos sobre o punk no país (“O punk no Brasil”).
João Bittencourt
Interessante perceber que a cidade e o contexto social influenciam diretamente nossos estilos musicais e nossa forma de nos expressarmos. Boa pesquisa!
Adhalya Intchala
Punk Brasil em São Paulo, pela ótica de João Neves, ficou demais. Parabéns à FAPESP por apoiar a pesquisa que resultou nesse ótimo trabalho.
Gustavo BertolucchiSua opinião é bem-vinda. As mensagens poderão ser resumidas por motivo de espaço e clareza.
CONTATOS
revistapesquisa.fapesp.br
redacao@fapesp.br
PesquisaFapesp
PesquisaFapesp
pesquisa_fapesp
@pesquisa_fapesp
PesquisaFAPESP
pesquisafapesp
cartas@fapesp.br
R. Joaquim Antunes, 727
10º andar
CEP 05415-012
São Paulo, SP
Sua pesquisa rende fotos bonitas? Mande para imagempesquisa@fapesp.br Seu trabalho poderá ser publicado na revista.
Esse anel de torres está em fase de conclusão para despejar ar enriquecido em gás carbônico (CO2) sobre uma pequena área de floresta amazônica, 80 quilômetros ao norte de Manaus. É parte de um experimento do projeto AmazonFACE em uma reserva do Instituto Nacional de Pesquisas da Amazônia (Inpa), que no final de 2024 entrará em ação com outros cinco anéis. O experimento medirá uma diversidade de respostas fisiológicas da floresta diante das condições previstas para a mudança do clima. Duas imensas gruas ao lado de cada um dos anéis facilitarão a pesquisa de dossel. “Ver a floresta de cima é uma experiência indescritível, chega a umedecer os olhos”, conta o ecólogo David Lapola, da Universidade Estadual de Campinas.
Imagem enviada por David Lapola, do Laboratório de Ciência do Sistema Terrestre da Unicamp

A FAPESP convida bolsistas de pós-doutorado com atuação no Brasil para participar da
HUMANIDADES, CIÊNCIAS SOCIAIS E ARTES
O encontro será entre os dias 10 e 13 de dezembro em Embu das Artes, São Paulo.
Os bolsistas terão oportunidade de conhecer, interagir e debater com lideranças científicas do Brasil e do exterior e estabelecer laços profissionais com seus pares.
INSCRIÇÕES ABERTAS ATÉ 04 de novembro de 2023
Para mais informações e inscrições, acesse
À VENDA EM BANCAS DE TODO O PAÍS